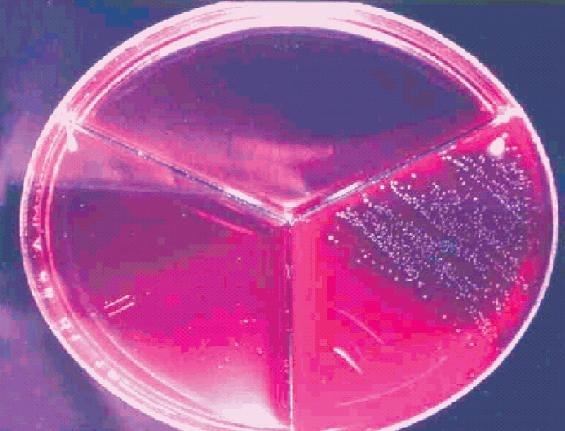

•10ª Escuela de Preparadores de CONAFE
•Ganadería Viñes
•Memoria CONAFE 2014

•El cáncer y las vacas
•Elección del sistema de refrigeración en instalaciones de vacuno lechero
Julio/Agosto 2015 - XXXV Año - Núm. 208



•10ª Escuela de Preparadores de CONAFE
•Ganadería Viñes
•Memoria CONAFE 2014

•El cáncer y las vacas
•Elección del sistema de refrigeración en instalaciones de vacuno lechero
Julio/Agosto 2015 - XXXV Año - Núm. 208




Tercera página......................................................................................3
Noticias del sector................................................................................4
REPORTAJES
•10ª Escuela de Preparadores de CONAFE 2015...........................6
•Concursos locales:
16º Campeonato de ganado frisón de Irún ..............................16
Subasta de ganado frisón de Muimenta ...................................16
19º Concurso de ganado frisón de Feiradeza............................17
21º Concurso de raza frisona Valle de Carriedo........................17
•Ganadería Viñes (Asturias)............................................................18
OPINIÓN
• Ramón Artime, Presidente de INLAC ..........................................24
CONAFE
• Resumen de la Memoria CONAFE 2014.......................................28
•Vacas Medalla de Oro y Vacas Estrella.......................................40
GENÉTICA
•¿Por qué era y es importante poner atención a la consanguinidad? La genómica ayuda a detectar problemas y a evitarlos. J.A. Jiménez..............................................................42
•Evaluación genética de facilidad de parto (II).
D. Hernández...................................................................................44
•Familias de vacas españolas: Megate. J.A. Jiménez................46
•Evaluaciones genómicas de las mejores novillas genómicas con edad inferior a 18 meses. Dpto. Técnico de CONAFE.......50
•Consultorio genómico. J.A. Jiménez ............................................52
•Pruebas CONAFE-MACE junio/agosto’15....................................54
•Nuevos toros en reparto.................................................................66
ESCUELA DE JUECES SOBRE PAPEL
•Resultados sección 69ª...................................................................72
•Sección 70ª......................................................................................73
CALIFICACIÓN
•Animales calificados EX y MB durante los meses de mayo y junio de 2015.....................................................................74
ANEMBE RESPONDE
•Aplicaciones de la fecundación in vitro a nivel comercial. R.F. Vázquez..................................................................92
•La última reforma del Código Penal. M. T. Jurado.....................94
TEMARIO
•¿El problema son las mamitis clínicas? M. Martín-Richard ........96
•Biomarcadores hemáticos. E. Trevisi...........................................100
•El cáncer y las vacas. J.V. González .........................................106
•Elección del sistema de refrigeración en instalaciones de vacuno lechero. A. Callejo....................................................110
•El secado, donde todo comienza. 1. La relación entre mastitis y reproducción (parte II). A. Jiménez...........................118
y además...
• 36º Concurso Nacional CONAFE’15 de la Raza Frisona Calendario de actuaciones y secciones..................................120
•Guía Comercial.............................................................................125
•Índice de anunciantes.................................................................126

www.conafe.com
Valoración genómica de hembras para seleccionar las futuras mejores productoras de la explotación.
El genotipado de las novillas permite tomar decisiones rápidas y fiables sobre qué animales comprar o vender, detectar enfermedades genéticas, corregir errores de genealogía o consanguinidad...
ConafeMat es un programa de acoplamientos al que se puede acceder a través de SinBad.
Su objetivo es facilitar al ganadero la selección de los toros más adecuados para sus objetivos de selección.
Programa de recogida de información sobre salud podal para el control y prevención de cojeras.
Con la colaboración de un grupo de podólogos, se recogen datos sobre dermatitis digital e interdigital, úlcera plantar, flemón interdigital, lesión de la línea blanca, laminitis crónica e hiperplasia interdigital.


Avelino Souto, campeón absoluto de la Escuela de Preparadores de CONAFE 2015
Julio/Agosto 2015
Directora: Pilar López Caño
Subdirector: Baldomero Fernández Fernández
Diseño y Publicidad: Departamento propio
Suscripciones: Charo García Tovar
Redacción, Publicidad y Suscripciones
Revista Frisona Española - CONAFE Apdo. de Correos 31 28340 Valdemoro (Madrid) Ctra. de Andalucía Km. 23,600
Tlfs: 91 895 24 12/62/68 - Fax: 91 895 14 71
Correo Electrónico: publicidad@revistafrisona.com suscripciones@revistafrisona.com conafe@conafe.com
Páginas Web: www.revistafrisona.com www.conafe.com
Precio Suscripción 2015
España.............48 Euros (IVA incluido) Europa..............77 Euros (IVA incluido) Resto Mundo...90 Euros (IVA includio)
Edita:
Confederación de Asociaciones de Frisona Española
Junta de Gobierno de CONAFE
Presidente:
Germán de la Vega Delgado, AFCA
Vicepresidente:
José Emilio García Suárez, ASCOLAF
Secretario:
José Carlos Vega Rodríguez, FEFRIGA
Tesorero:
José Antonio Hernández Martín, FEFRICALE
Interventor:
Jaime Olascoaga Enseñat, AFB
Vocales:
Antonio Casas García, AFA
Carlos Prat Castillejo, AFNA
Carlos Manuel Sánchez García, AFRIARA
Alejandro Arasanz Balongo, AFRICAMA
Miguel González de Parla, AFRIDEMA
Valentín Novales Elejalde, EFRIFE
Agustí Prat Aguilar. FEFRIC
Sofia Alday Martínez de Cestafe, Directora Gerente
Impresión: Litofinter, S.A. ISBN. 9211-3767
Depósito Legal: M-5.568-1981
CONAFE no se responsabiliza del contenido de los artículos, anuncios y otros escritos firmados, así como tampoco, necesariamente, comparte los criterios de sus autores. Se permite la reproducción total o parcial de los artículos, informaciones y fotografías de esta revista citando el origen.
El verano de 2015 está siendo calentito, y no precisamente por las altas temperaturas que se están registrando en todo el país. El ambiente se viene caldeando desde la primavera –antes incluso–, con la bajada de los precios y la desesperación de los productores. Normal que estén echando humo.
La Administración ha adoptado el rol de padre y ante la situación de crisis que viene atravesando el sector, para muchos ya insostenible, se limita a repetir las mismas frases que venimos escuchando desde hace muchos, demasiados años. La ministra García Tejerina nos recuerda que el Gobierno no puede fijar un precio para la leche porque sería contrario a las normas de competencia, que el desequilibrio entre oferta y demanda marca los precios y provoca su bajada, que cuanto menos organizado está el sector (productor), más vulnerable es; que hay que dar valor a la cadena de valor para hacerla estable y sostenible. El presidente del Gobierno, por su parte, pide “la aportación de todos para “forzar” un acuerdo en el sector lácteo”. Buenas palabras y buenas intenciones que en la práctica se quedan poco menos que en papel mojado mientras los precios que se están pagando por la leche están en muchas zonas por debajo de los costes de producción, muy lejos de los 34 o 35 céntimos de euro, mínimo teórico para cubrir los costes.
Además, la Administración siempre se puede acoger al comodín de las normativas legales y de la Comisión Nacional de los Mercados y la Competencia (CNMC). Querrían hacer, pero no pueden. La titular de Agricultura ha manifestado que en la reunión de los ministros de la UE del próximo 7 de septiembre pedirá que suban los precios de intervención pública de la leche para estimular la retirada de producción del mercado y así equilibrar oferta y demanda y facilitar las recuperación de los precios. Pues ya han dicho desde la Comisión Europea que no son partidarios de subir el precio de intervención de la leche en polvo porque retrasaría el “inevitable y necesario” ajuste del sector, disminuiría su competitividad y dañaría sus perspectivas.
Como mirar hacia Bruselas ni soluciona ni consuela, la atención de los ganaderos está puesta en Francia, donde al parecer se ha establecido un precio mínimo de 0,34 euros por litro. Y decimos al parecer porque según los productores el mínimo lo ha establecido la administración y según ésta, es un acuerdo del propio sector.
El comercio exterior tampoco es de momento una buena vía de escape. El embargo ruso, las importaciones a China e India que no acaban de despegar, ralentizan la oportunidad expansionista del mercado europeo. Como indicó a mediados de agosto el comisario europeo de Agricultura, Phil Hogan, hay “una sobreoferta general de leche en el mercado mundial, frente a una demanda global menos dinámica”.
La solución no es fácil. Son muchas las voces que piden el apoyo al resto de la población; unas promocionando el consumo de leche y productos lácteos, otras informando sobre la situación del sector. Pero la crisis afecta a todos los sectores en mayor o menor medida y a cada uno le duele lo suyo.
Está claro que la solución tiene que venir de dentro. Sindicatos y agrupaciones de productores apuntan, entre las medidas para mantener al sector, el fomento de la cooperación entre los propios productores. Sin embargo, a pesar de ser una medida aparentemente al alcance de todos los ganaderos, la unión entre productores para adoptar una postura común frente a las condiciones de industria y distribución, se evidencia muy complicada.
Mientras, como lecturas recomendadas para el verano apuntamos el borrador de la propuesta de acuerdo del sector lácteo y las doce medidas promovidas por el MAGRAMA para el sector lácteo, que incluyen, entre otras, el apoyo a las organizaciones de productores, la promoción del consumo y estudiar la posibilidad de llevar a cabo una retirada de productos lácteos del mercado si la Comisión no adopta el 7 de septiembre medidas que supongan la retirada de leche. Son numerosas las tractoradas y manifestaciones de productores que están teniendo lugar en nuestro país y que se seguirán produciendo en los próximos días, como la “marcha blanca” que bajo el lema “Nuestro futuro es la leche” está previsto salga de León el 24 de agosto para “plantarse” ante el Ministerio de Agricultura, en Madrid, el 4 de septiembre. Como decíamos, el sector productor echa humo.
La genética española participa en el Foro Holstein de Méjico
Los pasados 9, 10 y 11 de julio se celebró en Pachuca (Estado de Hidalgo, Méjico) el 6º Foro Nacional Holstein 2015 (FONAHOLSTEIN) con la participación de CONAFE y los centros de IA españoles. Durante los tres días, expertos en las diferentes áreas involucradas en el vacuno de leche analizaron y reflexionaron sobre la actualidad de la raza en relación a la eficiencia alimenticia, la mejora en las pautas de manejo y los avances en selección genética. La jornada del día 10 fue inaugurada por la charla organizada desde CONAFE con la colaboración de Aberekin, Ascol y Xenética Fontao “Uso de la genómica para la selección de ganado Holstein en España” a cargo del Dr. José Antonio Jiménez Montero como ponente invitado. El técnico de CONAFE presentó la evolución del programa de selección a nivel de centros de inseminación y a nivel de ganadería desde la llegada de la genómica. También se mostró la relación existente entre las predicciones genómicas y las posteriores pruebas de descendencia de los toros, las aplicaciones del genotipado en terneras, la reciente incorporación de información complementaria y los efectos del uso de la genómica en el progreso genético de la población.
Los más de 160 asistentes siguieron con gran interés la charla como demuestran los más de 30 minutos que duró el turno de preguntas. Los ganaderos mexicanos se mos-

traron muy interesados por el funcionamiento práctico del programa, en cuanto a tiempos, flujo de la información y aplicaciones prácticas y plantearon posibilidades de colaboración entre las asociaciones de ambos países.

Las Jornadas Técnicas de Vacuno de Leche de Seragro se centrarán en las especificidades del sector en Galicia
Los organizadores de las 13ª Jornadas Técnicas de Vacuno de Leche de Seragro –que se celebrarán los días 12 y 13 de noviembre en la Facultad de Veterinaria de Lugo– han apostado este año por una temática directamente relacionada con las especificidades del sector lechero en Galicia. Cultivo de forrajes y mercado de materias primas
Albert Porte Laborde repasará los aspectos básicos relacionados con el cultivo de maíz, desde el laboreo de las tierras hasta la siembra y la fertilización, partes cruciales del proceso que, según este ingeniero agrónomo francés, pueden condicionar en gran medida el éxito o el fracaso de la cosecha.
También se abordará el cultivo de la hierba, haciendo una revisión de los aspectos clave del manejo de la siembra de las praderas. Además, en esta exposición se tratará de buscar los posibles errores que condicionan la problemática de los silos de hierba en Galicia.
La charla de Iván Álvarez Bajo, socio y fundador de la asesoría agraria Asegrain, tendrá como objetivo, dadas las repercusiones económicas
que las subidas y las bajadas de los precios de los piensos tienen sobre el coste productivo de las explotaciones, dar a conocer algo más sobre el funcionamiento de este mercado, las fluctuaciones de los precios y los factores que las pueden inducir. Siguiendo con las materias primas, Bruno Beade García, de la Asociación Gallega de Fabricantes de Alimentos Compuestos (Agafac) explicará la metodología empleada y las pruebas realizadas a las materias primas que se utilizan para la elaboración de piensos destinados a las explotaciones.


La experiencia de tres ganaderías gallegas y los cambios en el ICO En el encuentro también intervendrán los representantes de tres ganaderías gallegas, que compartirán con el auditorio sus experiencias y puntos concretos del manejo diario de sus explotaciones. Se trata de granjas en las que el sistema de ordeño y el tipo de estabulación, en algún caso, condicionan el resto de las tareas habituales. Esta presentación permitirá ver las principales diferencias en el manejo entre un establo canadiense con un sistema de ordeño mediante un circuito en línea alta, una estabulación libre con un ordeño trasero y una granja con ordeño robotizado. Por otra parte, los asistentes tendrán la oportunidad de escuchar la conferencia de José Antonio Jiménez, jefe del Departamento Técnico de CONAFE, sobre los cambios que experimentó el ICO español, con la inclusión de caracteres funcionales y con las modificaciones de los pesos relativos de cada uno de los caracteres que lo conforman. Jiménez hará una comparación del ICO con los índices empleados en otros países, de forma que los ganaderos lo tengan más fácil a la hora de tomar decisiones.
A todo esto se añade un trabajo de campo realizado por Seragro SCG que aborda un problema recurrente
en las granjas: la mano de obra externa. Para la obtención de los resultados, que serán expuestos por el veterinario Víctor Manrique, se elaboraron encuestas que permitieron conocer los puntos críticos en la relación entre jefes y empleados. Con los resultados se pretende reducir la inestabilidad que acontece en las explotaciones motivada por tal hecho.
Otros temas
Para cerrar el programa de conferencias, la organización está gestionando la presencia de un experto que analice de la evolución del consumo de lácteos en España, recopilando también cierta ejemplificación de las continuas agresiones que, desde numerosos ámbitos de la sociedad, se lanzan contra la leche y presentando, por último, todas las bondades que este alimento de primera necesidad ofrece.
Tampoco faltará la celebración de una mesa de debate en cuya configuración se está trabajando y en la que se abordará la situación actual del mercado de la leche en Galicia y en España, así como las perspectivas de futuro.
Nuevo libro de Antonio Callejo Ramos
"El confort del ganado lechero en épocas de calor. Manejo del estrés térmico", Antonio Callejo, nos presenta su nuevo libro editado por Editorial Agrícola Española, S.L. y el MAGRAMA, y patrocinado por las empresas: Bayer, Covap, DeLaval, Emporvet, S.L. y Lallemand.
Antonio Callejo Ramos es profesor Titular del Departamento de Produccion Animal, E.U.I.T, Agrícola de la Universidad Politécnica de Madrid.

El italiano Massimo Capra comenzó a trabajar como calificador para la Asociación Frisona Italiana ANAFI para pasar luego a formar parte de la plantilla de la organización de IA C.I.Z. Desde 1991 es responsable del comercio (entre 1.200 y 1.500 cabezas holstein anuales) y de las actividades técnicas de la cooperativa C.A.F.R.I., Asociación Frisona de Cremona.
Ha juzgado el concurso nacional italiano de Cremona en 2003 y 2009, así como los más importantes certámenes de su país.
Ha juzgado también concursos en Polonia, Turquía, Holanda y España, donde juzgó el Autonómico de Galicia en 2005.
Zoetis


en una Jornada de vacuno de leche organizada por Covap



El 1 de julio tuvo lugar en Dos Torres (Córdoba) la jornada de vacuno de leche “Cambio de paradigma, mirando el margen por litro” organizada por la Cooperativa Ganadera del Valle de los Pedroches (Covap) y Editorial Agrícola. Zoetis fue el patrocinador principal de la jornada y participó en la misma de la mano de Juan Antonio Latorre (en la foto), gerente de Marketing de la Unidad de Rumiantes de la compañía, quien intervino en la mesa redonda celebrada sobre tecnologías existentes en la producción ganadera, que inciden en la rentabilidad de las explotaciones. En este sentido, Latorre expuso el concepto de Farmacoeconomía, una ciencia a aplicar a los planes sanitarios de las explotaciones ganaderas con el objetivo de tener en cuenta criterios económicos, además de sanitarios, a la hora de tomar decisiones en este ámbito. La idea clave que transmitió Latorre en la jornada fue la necesidad de percibir la sanidad como una inversión y no como un coste. Y así lo reflejó mediante cifras ya que, como argumentó el experto, “el coste de vacunar frente a una enfermedad puede suponer 10 euros por animal y año, mientras que un brote de BVD puede suponer un impacto económico de 200 a 300 € por animal en una granja que no haya estado en contacto previo con el virus.”
Este es un ejemplo más del compromiso de Zoetis con los profesionales del sector vacuno, ayudándoles en el cuidado de sus animales y, por ende, en la rentabilidad de sus explotaciones.
Septiembre:

Octubre:







Este año se celebraba la 10ª edición de la Escuela de Preparadores que CONAFE comenzó a organizar en 2005. Desde entonces han pasado numerosos alumnos por sus aulas y muchos de ellos son, hoy día, reconocidos profesionales en los eventos ganaderos más prestigiosos.
El IES de Luces, como viene haciendo desde la primera Escuela de Preparadores de CONAFE celebrada
edición. Como lo hiciera la primera vez el entonces director del Instituto, Carlos Pérez, la actual directora, Elsa Carbo-

Campeón: Avelino Souto. Subcampeona: Julia Serrabassa y Mención Honor: Abril Sabrià (a su derecha)




magníficas instalaciones con las que cuenta el centro.
Este año muchos alumnos acudían por primera vez, con unas edades comprendidas entre los 10 y los 27 años, siendo el grupo más numeroso el de los más jóvenes. Todos, eso sí, con mucha ilusión y ganas de aprender y afianzar conocimientos sobre la vaca frisona, con la que conviven en sus granjas. Mención especial para los padres que al regresar a casa, tratan de poner en práctica lo que han aprendido sus hijos en esta Escuela.
Bajo la dirección de Gabriel Blanco, Jefe del Departamento de Morfología de CONAFE y con los conocimientos impartidos por los profesores Javier Álvarez Bonet Cid y Jaume Serrabassa, que atesoran una gran experiencia ganadera, los alumnos toman contacto con todo lo que supone seleccionar, domar y preparar un animal para un concurso ganadero, así como su manejo durante el concurso propiamente dicho y la presentación de su ganadería en el correspondiente stand. Esto significa que durante cinco días los alumnos deben atender a los animales que les han sido asignados, desde su alimentavacas en lactación, además de las ta-

De nuevo, tras la experiencia del pasado año, se incluyó en el programa de actividades la presentación en PowerPoint del modelo de ganadería que representaban. En la sala de conferencias cada grupo tuvo que presentar este trabajo al resto de los participantes, interviniendo todos los integrantes del equipo. Así, unos hablaron de la selección genética que estaban realizando, otros de la alimentación, del ordeño, del tipo estabulación, reproducción, etc. Todas las presentaciones fueron excepcionales, destacando el manejo, el dominio y el conocimiento que los más pequeños tienen tanto de los soportes como de los programas informáticos.
Además de las clases habituales sobre morfología de la vaca lechera y sus regiones, alimentación, ordeño, lavado, pelado, preparación de camas, doma y manejo, se realizó una demostración práctica de arreglo de pezuñas y la distinta sintomatología que puede padecer una vaca en nuestro establo si no atendemos debidamente este aspecto. Ángel Fernández de Podología Pura, colaboró un año más



 Jon pelando, Abril lavando su novilla y Avelino, Ismael y César, en el ordeño
Mantenimiento de las camas
Clase de pelado
Jon pelando, Abril lavando su novilla y Avelino, Ismael y César, en el ordeño
Mantenimiento de las camas
Clase de pelado


compañero calificador, Santiago Mato
También nuestro agradecimiento por su colaboración a la empresa ASA y a la Fundación Caja Rural de Asturias.
Valoración de los grupos
Después de tres jornadas de intenso aprendizaje, el cuarto día de la escuela el grupo de profesores valoró el trabajo realizado por los alumnos, distribuidos en los distintos grupos. Como reflejamos a continuación con los comentarios de los monitores, la Escuela puede ser muy divertida, pero las tareas deben realizarse bien forma y tiempo porque el resultado se va a examinar a conciencia.
Grupo Trujillo: Cesar Díaz Abraira, Saúl Martínez Cuesta, Julia Serrabassa Batalla y Marco Entrecanales Díaz
Grupo S.A.T. Europe Holstein: José Casas Pombo, Alejandro Barbapolo Cagigal, Manuel Fernández López, Sara Fernández Jiménez y Alex Entrecanales Jiménez

Sociedad Carmela. Grupo 1

A juicio de Bonet, Javier y Jaume este grupo realizó un trabajo muy bueno de equipo, con las camas de sus animales muy bien hechas desde el primer día y la alimentación muy cuidada. El único punto negro que apreciaron los profesores fue el retraso en el pelado y en la realización del stand, que les llevó mucho tiempo y en el que “había cosas que se podían haber hecho mucho mejor”. En cuanto a la presentación en PowerPoint, hicieron un buen trabajo, con una presentación muy correcta, distribuyendo muy bien las áreas de las que se hablaron. Como afirmaron los monitores, trabajaron muy bien en equipo, como lo habían hecho en el resto de las tareas que realizaron durante la semana. “Aunque, recalcaron, tardaron mucho al componer el stand.
Trujillo. Grupo 2
A juicio de los propios componen-


tes del grupo, su trabajo había estado muy bien, coincidiendo todos al afirmar, respecto a su stand, que “es como es. No tenemos mucha imaginación”.
Para los monitores, las camas hechas por este equipo estaban bastantes bien y–aunque en algún momento bajaron la concentración–consiguieron llegar al final con muy buena nota.
“No habéis tenido que hacer grandes cambios. Desde el primer día, disteis con la tecla –no sabemos si por azar o porque realmente lo decidisteis de esta forma–pero se ha mantenido muy bien; es muy importante hacer una buena cama el primer día”, les transmitió Jaume, portavoz de los monitores en la valoración.

El stand sencillo y con información básica, tendría que haber estado más limpio. En cuanto al trabajo de equipo, muy desigual, poco coordinado, con altos y bajos. “Nunca habéis acabado por ser un equipo y tirar todos para adelante. Y en cuanto al pelado, les indicó Jaume, está hecho al 50% y hay que trabajar todavía mucho”.
“La alimentación hay que cuidarla más, las vacas esta tarde os pedían comida, continuaba el análisis que les transmitía Jaume- estaban inquietas tirando incluso de la cadena. Esto se tiene que cuidar, que quedan pocas horas y mañana (por el viernes) tiene que estar todo limpio y en orden y os tenéis que organizar bien, para lavar, pelar... pensad que necesitáis dos horas para que se sequen los animales”, concluyó.
Lavanda. Grupo 3

Los alumnos de este grupo pensaban que habían mejorado mucho du-

 Sociedad Carmela: Javier García Sánchez, Pau Sabrià Liaño, Avelino Souto Rozados, Ismael García Arias y Jon Vivanco Hernaiz
Lavanda: Jorge Vázquez Cuñarro, Peio Lecue de la Hoz, Abril Sabrià Liaño y Graciela Martín García
Sociedad Carmela: Javier García Sánchez, Pau Sabrià Liaño, Avelino Souto Rozados, Ismael García Arias y Jon Vivanco Hernaiz
Lavanda: Jorge Vázquez Cuñarro, Peio Lecue de la Hoz, Abril Sabrià Liaño y Graciela Martín García






rante los días previos hasta que Jaume les preguntó “¿pensáis que habéis trabajado en equipo?...”
Empezando por las camas, que es prácticamente la primera tarea que realizan en la Escuela, Jaume afirmó que estaban bastante correctas, “pero seguimos con el hándicap del primer día, sigue faltando un poco de “chicha”. Camas correctas sí, pero no sobresalientes”, apuntó Bonet Cid. Lavanda preparó un stand correcto y atractivo a juicio de los profesores. Además, al haberlo resulto en los dos primeros días de escuela, pudieron trabajar en otras facetas y hacer otros trabajos pendientes.
Continuando con la valoración de este grupo, los monitores destacaron el trabajo de equipo de sus componentes, haciendo un reconocimiento especial a Peio por ayudar a sus compañeros. Una colaboración que como equipo, faltó con el resto de grupos, que sí se ayudaron entre sí. “Nos gustaría -dijeron los profesores- ver un poco más de sintonía con otros grupos, un poco más de solidaridad, de ayuda, de conexión”. “Falta sintonía e interrelación con los otros grupos”. apostilló Javier Álvarez.
“La alimentación de las vacas está bien –continuaron los monitores con su
que tenían que comprobar muy bien los horarios para organizar el trabajo que tenían pendiente, lavar y rematar el lomo de los animales, la alimentación, el ordeño y además dormir bien y descansar para la dura jornada que les esperaba.
. Europe Holstein. Grupo 4
“Camas bastante correctas, no llegando a la perfección, desdibujadas en la linea trasera; falta un pequeño plus para que se vean más bonitas”. Así comenzó la valoración del stand de este grupo; un stand que aunque en algunos momentos no lo pareciera, consiguieron acabar, presentándolo correcto y limpio, pero con carteles mejorables.
“El trabajo en equipo ha mejorado con los días –añadieron los profesores–, y al final estáis más cohesionados, trabajando más en equipo, sin bajones, bastante constantes”. Las tareas de pelado estaban prácticamente todas hechas, a falta de los lomos y las ubres. En cuanto a la alimentación de los animales, Jaume les dijo que las novillas estaban mejor, pero la vaca no estaba lo llena que debería estar, lo deseable que debería. Como a los otros grupos les aconsejó que aprovecharan el tiempo que quedaba “a tope; organi-
 José pelando su vaca
José pelando su vaca




Categoría infantiles (de 11 a 13 años)
1ª y 1ª Preparadora Julia Serrabassa Batalla, 12 años (Barcelona)
2º Abril Sabrià Liaño, 10 años (Girona)
3º Manuel Fernández López, 13 años (Lugo)
4º y 2º Preparador Javier García Sánchez, 11 años (Cantabria)
5º Saúl Martínez Cuesta, 13 años (Cantabria)
6ª Pau Sabrià Liaño, 11 años (Girona)
7º Alex Entrecanales Jiménez, 10 años (Cantabria)
8º Marco Entrecanales Díaz, 10 años (Cantabria)
Categoría juveniles (de 14 a 16 años)
1º y 1º Preparador Avelino Souto Rozados, 16 años (Pontevedra)
2ª y 2ª Preparador Jorge Vázquez Cuñarro, 14 años (Lugo)
3º José Casas Pombo, 16 años (A Coruña)
4º Sara Fernández Jiménez, 14 años (Cantabria)
5º Jon Vivanco Hernaiz, 14 años (Cantabria)












Categoría adultos (a partir de 17 años)




1º y 2ª Preparador Ismael García Arias, 19 años (A Coruña)


2º César Díaz Abraira, 17 años (Lugo)



Alumnos y profesores con la Directora del IES de Luces y el Vicepresidente de CONAFE
En primer lugar salieron a pista los alumnos de más edad, para que los más jóvenes vieran el funcionamiento de la competición. Ismael García, fue elegido mejor manejador de la categoría, seguido por César Díaz y por Alejandro Barbapolo. La destreza de Ismael en la conducción del animal, transmitiéndole tranquilidad y la atención a las órdenes del juez, posicionando muy bien su vaca y ocultando sus defectos, le hicieron merecedor de tal distinción.
ya atesora la catalana Julia Serrabassa, con una técnica envidiable para su edad. Para Javier Álvarez, fue la mejor sección del concurso, por la soltura, tranquilidad, rapidez y agilidad que demostraron todos los alumnos. En segunda posición el juez colocó a Abril Sabrià, seguida por Manuel Fernández
Clausura y entrega de diplomas
Los Profesores-Monitores de la Escuela de Preparadores, Javier Álvarez, Bonet Cid y Jaume Serrabassa, fueron distinguidos con una mención especial por su dedicación y excelente trabajo durante estos años
se les había asignado, aplicando
A continuación salieron a pista los alumnos de 14 a 16 años. Aquí el ya veterano Avelino Souto,se impuso a los otros cuatro participantes, casi todos repetidores de la escuela,por delante de Jorge Vázquez, segundoy José Casas, tercero. Avelino volvió a demostrar su maestría en el manejo del animal, corrigiendo muy bien la posición en cada momento.
En la sección de infantiles de 11 a 13 años –la más numerosa con ocho participantes, casi todos nuevos en estas lides–destacó la experiencia que

La jornada y por ende la 10ª Escuela acabó con el tradicional acto de entrega de diplomas y premios a los alumnos y grupos destacados. En esta ocasión contamos con la presencia del alcalde y de la concejala de Cultura y Festejos del Ayuntamiento de Colunga, Rogelio Pando y Blanca Gayo; del Vicepresidente de CONAFE, José Emilio García; Elsa Carbonell, directora del IES de Luces y Javier Nievas, en representación de la Fundación Caja Rural de Asturias.
Tanto la directora como el alcalde de Colunga, felicitaron a todos los alumnos por su magnífica entrega, animándoles a que regresen el próximo año y vengan a visitar las maravillas que ofrece el concejo. Las puertas del IES de Luces –remató Elsa Carbonell–quedan abiertas para la próxima edición.
A la izquierda,



Remitido.- El concurso organizado por G.I.F.E. Asociación Frisona de Guipuzcoa celebró su 16ª edición el pasado 1 de julio en Irún (Guipuzcoa).
En dicho campeonato participaron cinco ganaderías, dos gipuzcoanas: Ondazarte Gain y Ondartza Bitarte y tres ganaderías vizcainas: Murrieta, Casa Nueva y Ardeo, con un total de 44 animales distribuidos en 6 categorías.
Fue un campeonato de alto nivel, con secciones con animales

NAFE, Paulino Badiola, que juzgó la edición 16ª del Campeonato de Ganado Frisón de Irún 2015.
Ondarte Gain Sid Tximistarri, de la ganadería Ondazarte Gain ( IgueldoGuipuzcoa), fue elegida por el juez, Novilla Gran Campeona.
Otro de los premios destacadas, el de Mejor Ubre del Campeonato, fue para la vaca propiedad de la ganadería Casa Nueva de Carranza (Vizcaya), Casa Nueva Xacobeo Melissa

Remitido.- En el recinto ferial “Manuel Vila” de Muimenta, en el ayuntamiento de Cospeito, se celebró una nueva subasta, en la que se presentaron 19 animales, la mayoría vacas recién paridas, al ser este tipo de animal lo que más demanda el mercado.
El peso de la actual coyuntura del mercado de leche se hizo notar, con cinco animales no vendidos y precios muy contenidos. Así, el precio medio fue de 1.929 €, en la línea de las subastas anteriores de Castro Ribeiras do Lea (1.940 €), Chantada (1.950 €) y de Moexmu (2.000 €).
Hubo la oportunidad de adquirir buenos animales a bajos precios, desde los 1.500 €. Los incrementos desde el precio de salida promediaron los 250 €. Con todo, hubo varios animales que animaron la subasta, que hicie-
ron subir puntualmente los precios hasta los 3.000 €. Fue el caso de la pri-



por su carácter lechero y profundidad, pese a ser un animal muy joven. Blanco Holstein Anita Ana ET, una vaca adulta de 6 años, de ganadería Blanco, fue la Vaca Subcampeona Provincial Feiradeza.
El campeonato y subcampeonato de Vacas Jóvenes fueron para dos animales de la ganadería Blanco, Blanco Sandy y Boudois Balada Gold SS Blanco.
La ganadería Blanco colocó a otra de sus vacas como Subcampeona de Intemedias, Blanco Valiant Bess Rose, y como campeona de adultas con Anita Ana de Balnco, Manteiga se llevo el subcampeonato de adultas con Manteiga Xacobeo Mandarina.
Manteiga Xacobeo Clementina, Vaca Gran Campeona con María Manteiga, propietaria de la campeona y Roberto Saiz , Juez del concurso
Los días 27 y 28 de junio se celebró en Lalín (Pontevedra) el concurso de Feiradeza, juzgado por el Juez de CONAFE, Roberto Saiz
Remitido.- En Lalín (Pontevedra) se celebró la diecimonovena edición del concurso de Feiradeza, en el que participaron 88 animales de 18 ganaderías
pontevedresas, todos de gran caliad a juico del juez Roberto Saiz Rio.
Manteiga Xacobeo Clementina de la ganadería Manteiga, fue elegida Vaca Gran Campeona absoluta del concurso y Vaca Gran Campeona Provincial Feiradeza (premio especial Diputación de Pontevedra). Clementina venía de ganar el premio de Vaca
Tanto la ganadería Manteiga como Blanco, que fueron el Mejor Criador y Segundo Mejor Criador Feiradeza, respectivamente, cosecharon varios premios en terneras y novillas.
Manteiga Airlift Claudia, fue la Novilla Gran Campeona además de Ternea Campeona.
Blanco Picolina, Ternera Subcamepona y Blanco Megamery, Novilla Subcamepona.
La ganadería Midón, de Gresande, con Midon Chavela Fever, se llevó el premio a la Novilla Campeona.
El día 8 de agosto se celebró en Villacarriedo (Cantabria) el concurso de raza frisona del Valle de Carriedo, juzgado por el Juez de CONAFE, Paulino Badiola,
Remitido.- El bonio Valle de Carriedo da nombre al concurso de la raza frisona que se celebró el pasado 8 de agosto en Villacarriedo.
En el certamen, juzgado por el Juez de CONAFE Paulino Badiola, compitieron 22 ganaderías y 125 animales, una participación muy destacable en cuanto a número y calidad.
Por segundo año consecutivo, la ganadería El Campo se llevó el título de Vaca Gran Campeona, en esta ocasión con un animal adulto de seis años: Campo Durlin Cubana, manejada en pista por su propietario, Ángel Díaz.
La ganadería S.A.T. Tezanillos obtuvo la gran mayoría de premios del concurso. El de Vaca Joven Campeona con Tezanillos Sid Bombón el de Vaca Intermedia Campeona con Te-

La Vaca Gran Campeona del concurso con la familia propietaria, el Consejero de Ganadería de Cantabria y el Juez del concurso
zanillos Sid Regaliz, la que fuera Novilla Gran Campeona Regional de Cantabria y del Nacional CONAFE’14. Remató con Tezanillos Spirte Selena que fue la Mejor Ubre del concurso. Los premios de Mejor Criador y Mejor Rebaño también fueron para S.A.T. Tezanillos.
Por detrás de S.A.T. Tezanillos, en la
sección de Mejor Rebaño, quedó Granja Perejil “El Macho”. Los títulos, en las secciones de terneras y novillas, fueron, también, para la ganadería S.A.T. Tezanillos. Gran Campeona de Novillas fue la novilla Tezanillos Windbrook Merengona y la Ternera Campeona Tezanillos Braxton Toscana

“La genómica es el futuro; está avanzando a pasos



Martín Pérez del Valle y su mujer, Ana Belén, ordeñan actualmente 70 vacas en su ganadería de Lleidas (Posada de LLanes, Asturias), en la que piensan seguir manejando vacas extraordinarias sabiendo –si la crisis del sector lo permite–que en casa tienen asegurado el relevo generacional con sus dos hijas. Vocación les sobra.
Mi padre, nos comenta Món, hermano de Martín: “Fue de los primeros que iniciaron el control lechero cuando aún no existían los núcleos, uno de los más antiguos de Asturias y de España posiblemente, a finales de los años 50 y comienzos de los 60”.
La ganadería procede de sus padres, aunque no estaba en el mismo lugar que está hoy día, según nos cuenta Martín Pérez del Valle: “La ganadería estaba muy cerca de donde está ahora. Mi padre empezó con 8, 10 vacas, entre las que había pardo alpina y frisona”.
En el año 1968 se vuelcan definitivamente en la raza frisona, dejando las vacas que tenían de la raza pardo alpina y en el año 1985 se incorpora Martín a la ganadería.
El traslado a las nuevas instalaciones se produce en el año 2002. En ese momento contaban con 73 animales, aumentando progresivamente hasta los 138 animales que tienen actualmente, ordeñando 70 vacas, el resto, 56 son novillas y


terneras y 12 vacas, que en el momento de la entrevista, estaban secas.
Estas vacas proceden de las vacas que el padre de Martín importó de Dinamarca en 1968 y de Canadá en el año 1973: “De Francia -sigue Martín- se importaron, dieciocho novillas en el año 2003, realizándose las últimas importaciones de otras novillas francesas en 2005 y 2006, que es cuando ya dimos definitivamente el salto”.
Crecimiento
Martín no piensa, por el momento, aumentar el número de vacas en producción, solamente lo que se produzca por el crecimiento natural. Están sobrepasando ligeramente la cuota que hasta abril tenían establecida que era de 650.000 kg. “Este año nos pasaremos en 50.000-60.000 kg, seguramente”, recalca Martín.
La ganadería tenía una cuota histórica de 143.000 kg, fueron comprando el resto, salvo lo poco que les reasignaron de la reserva nacional, invirtiendo nada menos que 15.000.000 millones de pesetas.
Del sistema de cuotas y de la desaparición de las mismas opina Martín lo siguiente: “Lo que esperamos es que no haya una sobreproducción, porque esto llevaría a una caída de precios. Nosotros queremos tener un poco de estabilidad y seguir como íbamos, con un crecimiento natural, porque nos lo está pidiendo todo el sistema.”
Martín es partidario de que continuara el sistema de cuotas, dada la inversión que tuvo que realizar para su adquisición y por la regulación del mercado que existía.
En la ganadería trabajan Martín y su mujer Ana Belén; una de sus hijas María José. está estudiando veterinaria y posiblemente sea el relevo generacional de la ganadería, aunque la otra hija del matrimonio, Ana Belén, no descarta seguir con la ganadería, la vocación no les falta a ninguna de ellas.
Recría
La ganadería vende alguna novilla al centro de recría Santoveña, propiedad de José Antonio, que fuera uno de los socios de Gayere: “Porque las tenemos cerca, vamos viendo la evolución que tienen y si en algún momento hay que recuperar alguna, las tenemos aquí al lado. Estas novillas se venden con opción a compra”.
La recría permanece ahora repartida entre la granja y el Rancho Las Nieves.
Instalaciones
En el año 2002 construyeron la nave actual, con un único parque, donde están las novillas y las vacas de leche. Las secas están fuera, en un prado anexo, sacan también, a las novillas al prado, cuando están preñadas de cuatro, cinco meses. Regresan a la nave un mes antes del parto. La nave cuenta con cubículos con cama de arena: “Yo creo que es lo mejor para las camas, a nosotros nos va bastante bien”, para la limpieza del patio utilizan una pala. “Hasta ahora no hemos tenido problemas con la recogida y esparcido de los purines, pero estamos en una zona muy turística, de gran crecimiento en los últimos años y empiezan a oirse algunas voces, tienes que tener cuidado”
Ordeñan en una sala de 5 x 2, con retiradores automáticos de Westfalia, que la instalaron en el año 2002. La mujer de Martín se encarga del ordeño, dos veces al día, y él, de la alimentación y de la otras labores de
y
la sala de ordeño
la central lechera, cada tres meses.
Alimentación
La ración alimenticia, que se distribuye una vez al día con el carro unifeed, la formulan y controlan los
Producción.............. 650,000 kg

Vacas en ordeño.... 70
Media producción. 32 l/v/d
3,64% Gra. 3,12% Prot.
Total de efectivos.... 138 cabezas
Terreno cultivo......... 27 ha
Edad 1ª inseminación 14,5 m.
Intervalo Parto-cubrición 85 d.
Días abiertos, parto 142d.
Inseminación fecundante.. 148 d.
Edad 1º parto......... 24m.
Fertilidad novillas..... 66%
Intervalo entre partos420 d.
Media de partos.....3,5
Media calificación.. 82 puntos
20 MB - 1 EX
Media ICO............... +1835
(Autonómica: +1752; estatal:+1843)
Evaluación junio 2015
técnicos de ASA, Martín la mezcla en el carro, añadiendo el pienso y los correctores que le suministran: “Nosotros hacemos dos raciones para las vacas de leche, una cuando tenemos maíz y podemos añadirlo a la ración y otra para cuando no tenemos maíz”.
La ración de las vacas de leche esta compuesta de silo de raygrass 24 kg, heno de alfalfa 5 kg, más la mezcla 13 kg, en una cantidad total de 42 kg.
Para las novillas y secas la ración está compuesta de silo de raygrass 16 kg, harina de soja 0,800 kg, núcleo, 3,500 kg y paja de cebada 3,500. En total 23,800 kg .
Reproductivo
El reproductivo y la clínica lo lleva el veterinario David Iglesias, que dirige y pertenece a un grupo de seis veterinarios de Ribadesella.
Con este equipo trabaja también para implantar los embriones: “A la Tec Viñes Shottle Sacha ET, que es una vaca calificada 2 veces excelente, y que estuvo seleccionada para participar en la Confrontación Europea en 2013, le hemos hecho 2 flushing para extraerle embriones. Tenemos una ternera de Maccuchen con ella y estamos poniendo embriones de Silverridge V Elude, que ya hay preñeces, y ahora vamos a hacerla un flushing con Bayli Chen”.
El ganadero no recibe ninguna

La nave tiene un único parque de producción donde están las vacas de producción y las novillas

ayuda para realizar el trasplante de embriones pero le es rentable para la selección y mejora de su cabaña. Lo que si pueden optar es a la oferta de toros élite que anualmente realiza Ascol, a precios muy competitivos: “Es lo que se llama una compra conjunta de semen, el ganadero tiene asignada una cantidad de dinero para la adquisición de dosis y no te puedes pasar de ahí y te ofrecen un abanico de toros para que elijas que toros usar”.
Selección genética
A la hora de seleccionar que toros, Martín lo hace personalmente tras consultar las pruebas oficiales nacionales e internacionales, con el asesoramiento de los técnicos de Ascol: “Desde Ascol nos envían, todos los años, una relación de acoplamientos de todos los animales que tenemos, con tres opciones, pero no lo seguimos a pies juntillas De todas formas, ellos ya saben la línea genética que nos gusta. A la hora de sacar embriones si nos dicen que toro debemos usar, utilizando su programa de acoplamientos. Cuando vamos a hacer un flushing ha-
neras que nos nacen. Empezamos con Yorick y vimos que el resultado es bueno, luego pasamos a Brendy, que yo creo que va a ser mejor, muy positivo, también hemos utilizado, que están sin parir, a Mckayne, ahora estamos con Baily Chen. Utilizamos 25 dosis, de 25 en 25 dosis, para conseguir 18 preñeces, ocho, diez hembras, las que haya. También hemos utilizado semen sexado, puntualmente, cuando la situación lo requería”.


Martín ya ha hecho una prueba genómica a una de sus novillas, asesorado por Ascol, que estaban interesados en ver su prueba: “Yo creo que esto es el futuro, la genómica está avanzando a pasos agigantados, va muy rápido y con resultados positivos, que eso es lo bueno. Cuando pasen cuatro, cinco años, yo creo que los toros genómicos que ahora tienen un 73% de fiabilidad van a pasar a un 90%, que eso también es muy bueno”. “Aunque hay que decir –continúa Martín- que el precio de las dosis, ahora resulta un poco caras. Lo que no nos planteamos, es si el precio por hacer la prueba genómica de las novillas es ba-



Uno de ellos, un hijo de la Shottle Sacha, Mono Viñes Llabres ET ”. La ganadería ha mantenido una línea genética canadiense, desde que el padre de Martín empezara a seleccionar los animales, buscando buenas morfologías sin perder la producción: “Principalmente lo que buscamos son buenas estructuras y patas, que son fundamentales para que las vacas aguanten según la estabulación con los cubículos. Pero miramos también la vida productiva, que es de donde sale el dinero al final. Usamos también algún toro de línea americana, pero toros puntuales, nada más. De Ascol usamos toros en prueba y ya probados. En una época también utilizamos a Xacobeo”.
Entrega y precio de la leche
Viñes es socio de Central Lechera Asturiana, de la que eran abastecedores desde hace 20 años, en calidad de socios llevan cuatro años. En cuanto al precio que están cobrando ahora, Martín nos dice que es malo: “Estamos en 294,00 euros por mil litros, más las primas por cantidad, que en nuestro caso son 20 euros por mil litros, la prima por consumo de pienso a través de ASA y la prima de calidad doble A, que también tenemos, al final, sin IVA, cobramos sobre 57,60 ptas., 0.34 céntimos de euro. Este es el precio que vamos a cobrar en agosto, que ahora nos mandan una carta con el precio que vamos a cobrar con un mes de antelación”.
El precio ha ido bajando mes a mes desde primeros de año y de momento no parece que vaya a subir: “La crisis se alarga mucho y la ganadería y el sector lácteo, en toda la cornisa, como no se produzca un cambio rápido, se va a resentir y muchas ganaderías se van a quedar por el camino”, asevera Martín.
Aunque le hacemos ver que ellos al menos están en una central fuerte, Martín nos comenta lo siguiente: “Sí, bien relativamente, ya que se da la

paradoja que tenemos el caso de Corbera que es unas cooperativa para la compra-venta de leche, y está pagando precios por encima de los que nos paga la Central. ¿Cómo es posible?”
Crisis del sector lácteo
En cuanto a que acciones pueden emprender los ganaderos para cambiar la situación actual y que cobren más por la leche producida, Martín lo tiene claro: “Los ganaderos poco podemos hacer, lo único es que se consumieran más productos nacionales, que se fomentaran las campañas para favorecer el consumo de leche y sus derivados”. “La verdad no se lo que pasará, concluye Martín”.
gente. Los ganaderos ya saben que el sector está muy mal, pero hay que caminar un poco hacía la distribución, que se cambien los hábitos de consumo y que el consumidor vaya más a las firmas, no tanto a las marcas blancas y que consuma productos nacionales, como decía antes”
Concursos
mentalmente, ya que ellas suponen casi el 50% del total de las vacas de la ganadería.
La primera de ellas, Viñes Crusader Bruma (MB 85) con 13 partos, proviene de una vaca importada de Canadá en el año 1973.: “De esta familia hay en la actualidad 23 animales en la ganadería, destacando por su longevidad, muy buenas producciones y un temperamento muy bueno para el manejo, de los 14 animales vivos calificados de esta familia, en estos momentos, excepto uno de ellos, el resto están calificados BB (8) o MB (5).

“Los concursos nos gustan bastante, pero ahora participamos poco, que te quita mucho tiempo. Íbamos a los locales que se hacían aquí en Posada, a los regionales de Asturias y a los nacionales. Este año queremos volver al nacional, ya veremos”
En cuanto a las movilizaciones que se están empezando a llevar a cabo, Martín piensa que no sirven de mucho: “Porque es muy difícil concienciar a la

En cuanto al funcionamiento de CONAFE y Ascol y los servicios que reciben están muy contentos: Solemos colaborar en todo lo que podemos y nos piden, aportando vacas para las confrontaciones (se aportaron dos, una en el año 2000 y otra en 2013) o para que se hiciera aquí, en la ganadería, una reunión de calificadores para la unificación de criterios”
En la Ganadería Viñes hay que destacar tres familias de vacas funda-
La segunda de las familias se inicia con la vaca llamada Pedrosa Herta Beautician, una vaca adquirida en el año 1993 en la ganadería Pedrosa de Cantabria: “De esta vaca, cruzada con Juror, salieron dos hijas:
• VIñes Juror Herminia (MB 87), con una producción vitalicia superior a los 50.000 kg y,
• Viñes Juror Skena (MB 88), con Mención de Honor.
VIñes Juror Herminia se cruza con Integrity y se obtiene Viñes Integrity Herta (MB 86), con una producción en 5 lactaciones superior a los 56.000 kg.
De esta familia tenemos 21 anima-


les, de los cuales, ocho, están calificados MB, algunos de ellos en primer parto y con producciones superiores a los 10.000 Kg, como: Viñes Braxton Dasha (MB-85). Hay que destacar la longevidad de esta familia, ya que varias de ellas se encuentran en 5ª y 6ª lactación”. “Otras vacas destacadas de esta familia son:
- Viñes Tamy Waira (MB-88) 2º parto y, - Viñes Wimbrok Flor (MB-87) 2º parto”. La tercera de las familias y en la que tienen puestas unas grandes ilusiones es la que se inicia con Tec Viñes Shottle Sacha, 2 veces EX. Ésta vaca, nos cuenta Martín: “Tiene 7 generaciones MB o EX. Procede de un embrión del programa TEC de la Consejería de Ganadería de Asturias y de Ascol. Su madre es Raypel Sacha J. Allen VG (87) 6*, y su abuela, Raypel Sacha Rudolph (VG 88) 17*, siguen:
- Raypel Leadman Sara (VG 87) 12*
- Comestar Seventy Chief (EX) 23*
- Belle du Jour Sevenny (EX) 10*
- Belle du Jour Seven-Up
- Hodgsondale Laddie Lucy (VG) 1*. “Tenemos a Rudolph, Leadman y Chief Mark en la familia y 69 * en línea materna”.
La Sacha es la madre del semental de Ascol, Mono Viñes Toystory Llabres. Tiene 22 descendientes en la ganadería y, alguna, premio superior ICO.
“Los animales descendientes de la Sacha están calificados BB o MB, lo que denota el carácter transmisor del potencial genético de esta vaca. Así mismo todas las que han alcanzado la segunda lactación han superado de media, con creces, los 10.500 Kg. Destaca también y, es un factor que en la ganadería se cuida mucho, el magnífico temperamento de todos los ani-


males de esta descendencia”.
Hoy en día la vaca está dedicada a obtener embriones, una ternera, Mono Viñes Mccutchen Sacha, con un Gico de 3.439, está situada en el puesto 189 de las mejores terneras genómicaas, CONAFE julio 2015, una ternera de tremenda estructura. En la actualidad se están colocando los embriones obtenidos con Elude, en el otoño, una vez colocados los existentes, se le efectuará otra extracción”.
Futuro
“Según estamos ahora pienso que se va a quedar mucha gente por el camino, si no cambian las cosas, por el tema de precios. Dependerá de la producción y de la materia prima propia que tenga la ganadería. Uno de los mayores problemas que tenemos en Asturias es que tenemos poco terreno. Nosotros tenemos 27 ha, nueve de maíz, nada más, porque no tenemos hecha la concentración parcelaria. La gran mayoría son fincas pequeñas y con malos accesos”.
“Prácticamente tenemos que comprar casi toda la materia prima para la alimentación y los forrajes están por las nubes y la alfalfa también está muy cara, pero -continúa Martín- el problema mayor es el precio, no puede estar el coste de producción por encima del precio. Tanto el ministerio, que es el que tiene que tomar cartas en el asunto, y las empresas transformadoras, que se tomen esto en serio y que vean que o se hace algo o se hunde el sector”.



 Vista posterior de algunas de las vacas y novillas de Martín y Ana Belén, trabadas en las cornadizas, alimentándose
Vista posterior de algunas de las vacas y novillas de Martín y Ana Belén, trabadas en las cornadizas, alimentándose
ESPM0803197548
PLANET x TOYSTORY x GOLDWYN

THOS Planet Lion
• El único toro español y el mejor toro europeo del TOP 100 TPI INT. (USA, agosto 2015)
• Descendiente de una de las mejores familias de vacas (“Laia”) de Can Thos, con 6 generaciones MB y altos índices genéticos
• Buenas producciones de leche con excelentes calidades de grasa (+0,45 %) y proteína (+0,11 %)
• Tipo funcional y muy equilibrado, sin debilidades
• Alta longevidad (120) y muy bajos recuentos celulares (118)
• Facilidad de parto: indicado para novillas
• El toro ideal para los rebaños comerciales: vacas sin problemas, con buenas producciones, tipo correcto, ubres sanas y muy longevas


Ramón Artime conoce bien el sector lácteo como ganadero, como sindicalista y como Presidente de la Interprofesional Láctea, INLAC.
Hablamos con él de su experiencia en los tres frentes .


Frisona Española.- Ramón, nos comentabas fuera de micrófono que el culpable o uno de los culpables fundamentales de la situación de crisis que vive el sector lácteo español, es la distibución. ¿En qué basas esta afirmación?
El 60% de la leche que producimos va al brik y cuando hay un poco más de abundancia va más al brik y entonces, automáticamente, esto la distribución lo utiliza y lo está utilizando en estos momentos con subastas a la baja, lógicamente la industria entra a esas subastas bajando precios, porque tiene que colocar la leche y eso es lo que
está distorsionando los precios.
El consumidor sigue pagando, hoy, por el litro de leche, lo que pagaba hace seis o siete meses.
¿La industria no puede forzar para que no se produzca esta situación?
La industria lo que tiene que hacer es ir a productos de mayor valor añadido, productos como el queso, que un kilo de queso son diez o doce litros de leche y, después, tienen que pensar en los mercados exteriores, no se puede seguir pensando únicamente en el mercado interior, pero se-
guimos empeñados en meter toda la leche en el brik y es el gran error que tenemos en este sector.
Pero la industria también fabrica yogures y elabora quesos, incluso una empresa está dedicada casi exclusivamente a los yogures.
Se está incrementando la producción de quesos, pero hay que pensar en mercados exteriores. No se puede pensar en acceder a los mercados internacionales a través de fondos de inversión, desde mi punto de vista, hay que ocuparlos directamente, la industria española tiene que estar allí y tiene que ir con productos que demanden esos mercados, y no se estuvo haciendo hasta ahora. Sabíamos que iban a desaparecer las cuotas y lo dejaron pasar, no se dan cuenta de que esto tiene que cambiar.
En estos momentos ¿sobra leche en nuestro país para la comercialización a través del brik?
Sí, porque se ha incrementado la producción un 4% y ha disminuido el consumo otro 4%, pero se ha incrementado el consumo de quesos y yogures, entonces, lógicamente, si el mercado demanda esos productos tienes que ir a eso y para esto no está preparada la industria española.
¿Es este el desfase que llevamos arrastrando entre la cuota que teníamos asignada y el consumo real? Quesos sobre todo, que vienen de otros países europeos, ya tranformados y elaborados, para su inclusión en los lineales.
En el mercado español leche líquida entra muy poca, por no decir nada, lo que entran son quesos. Lo que tiene que pensar la industria española, vuelvo a repetir, es que si sobra leche y siguen metiendo más leche en el brik, más baja el precio ¿quién está pagando las consecuencias de esa mala política comercial? el ganadero, porque al final la distribución sigue ganando más de lo que ganaba, porque sigue vendiendo al mismo precio y le cuesta menos, mientras que la industria sigue ganando porque le baja el precio al ganadero. El ganadero, al final, es el gran perjudicado.
En las reuniones de INLAC, donde la industria está representada por la FENIL ¿qué dice ésta a este respecto?
Hay que tener en cuenta una cosa, que la industria láctea española pasó de ser una industria patriarcal, por decirlo de alguna manera, con D. Tomás Pascual, por ejemplo, a ser una industria donde los directores generales presionados por las multinacionales van a conseguir resultados, si el resultado no se consigue en el punto de venta se consigue en el punto de compra, que es mucho más fácil, y es lo que están haciendo.
¿Qué soluciones se han propuesto desde INLAC en las reuniones con el Ministerio, en las que también está presente la distribución?
Nosotros pensamos que la incorporación de la distribución a las mesas es bueno, porque están las dos opiniones y no vale buscar disculpas unos con otros, estamos todos allí y todos tenemos que hablar y escucharnos. Las soluciones pasan, primero, por la industria española, que tiene que cambiar el chip totalmente, tiene que ir a fabricar productos de mayor valor añadido, productos que nos permitan exportar, porque ya no sirve decir que España es deficitaria en leche, estamos en Europa y Europa produce mucha más leche de la que consume. Segundo, el ganadero también se tiene que
“el producto está en la explotación y lógicamente esa es la baza que tienen los ganaderos para organizarse y buscar un sistema que les permita controlar el mercado.en lugar de la referencia a la leche en brik”
organizar, hay sistemas de venta de leche que se utilizaron hasta ahora y que ya no sirven. Tenemos un problema muy grave en Galicia, y lo tenemos porque yo entiendo que hay muchos primeros compradores que no son transformadores, y eso, cuando hay escasez funciona, pero que muy bien, tira del precio hacia arriba, pero cuando hay abundancia ¿qué ocurre? que esa leche termina toda para secar y lógicamente eso hace caer el precio.
El ganadero tiene que mirar hacia atrás y ver qué es lo que se hizo bien y qué es lo que se hizo mal, el ganadero tiene que darse cuenta de que tiene en sus manos la base fundamental del sector, que es el producto, lo que está claro es, que sin producto no hay ganaderos, ni industrias ni lineales, por lo tanto el producto está en la explota-

Ganadería Artime: Sociedad civil de cuatro socios gestionada por el hijo de Ramón. Está asociada a CONAFE desde hace 21 años y en Control Lechero de 1992; también es socio de CLAS. Ordeñan 95 vacas de un total de 170 animales. Tienen un ICO de +1759, 80 puntos de media de calificación y una producción media anual de 10.000 kg/v al 3,60 % de grasa y 3,20% de proteína. La producción de este año sobrepasará el millón de kilos Cuota: 740.0000 kg, histórica 110.000

ción y lógicamente esa es la baza que tienen los ganaderos para organizarse y buscar un sistema que les permita controlar el mercado.
¿A qué niveles puede el ganadero controlar el mercado?
Hay tres ejemplos claros en España, Asturias con Central Lechera, País Vasco con Iparlat y Andalucía con la Covap, destacan en los baremos de precios, y ¿por qué destacan? porque participan y porque están consiguiendo valor añadido. ¿Dónde cae el precio en picado? en Galicia ¿por qué?, porque están mal organizados, no pueden tener una cooperativa en cada pueblo que gestione dos o tres cisternas de leche, esos tiempos ya pasaron, hay que ir a otros modelos, y habrá que implicar a las administraciones, habrá que implicar

al sector, habrá que hacer centros de recogida y cooperativas con volúmenes que permitan hacer quesos o secar leche, y donde el ganadero tenga un control sobre eso.
¿Cerrarán ganaderías en España? ¿Se va a volver a reestructurar el sector en nuestro país con el abandono de más explotaciones?
En España hemos pasado de más de 100.000 explotaciones de leche a apenas 17.000 actualmente y estas producen más que las 100.000. Para que eso ocurriera hubo que pasar las vacas de aquellas explotaciones, a las que quedan, hubo que hacer instalaciones nuevas, hubo que comprar cuota, un papel, que nos endeudó, el gran problema que tiene el sector es que está muy endeudado. En España no sé si cerraran explotaciones, lo que sí sé, es una cosa, que el modelo gallego de comercialización, desde mi punto de vista, tiene que sufrir una revisión, si no lo revisan, estamos sujetos a que nos pase factura cada cuatro meses.
¿Quién tiene que hacer esos cambios? ¿la administración, la industria, los productores?
Depende de los propios productores y depende de las cooperativas y depende de la administración. Las industrias no lo van a querer hacer, las industrias están muy contentas como están en ese sentido.
En estos momentos las cooperativas, las OPs, los sindicatos, ¿tienen fuerza para poder revisar el modelo actual?
Las Ops son unas figuras nuevas que se crearon pensando que se iba a aglutinar la venta de leche, pero a la hora de la negociación no es así, porque bajo el paraguas de una OPs, supongamos que haya 1.000 ganaderos y esos ganaderos pueden entregar a diez compradores diferentes, si entregaran a uno solo, todavía. Lo que tienen que hacer los ganaderos es autocontrolarse y autogestionarse, y para eso tienen que tener los mecanismos que hoy no tienen y que la administración debería apoyar.
¿Esto se podrá enfocar ahora con las ayudas que les va a dar el Ministerio a las OPs?
No creo, las OPs son una figura que tiene que estar ahí, pero no son la solución del sector, la solución del sector pasa por otros canales. A la industria hay que darle la leche que necesita y de la que sobra ni un litro, porque si tu le das a la industria la leche que necesita y le das la que sobra, al final se derrumban los precios. El ganadero debe gestionar y hacerse participe de esa gestión.
Para la reunión del 18 de agosto, a la que les ha emplazado el secretario general, Carlos Cabanas ¿tienen fijados unos objetivos concretos?
Los objetivos según está el mercado ahora mismo, son muy difíciles de lograr, porque va a ser el mercado quién los dictamine. No hay que olvidar una cuestión, se quitaron las cuotas creyendo que los países emergentes iban a absorber todos los excedentes que había en Europa, sin ningún tipo de problema, ¿qué ocurre?, que nos encontramos con el veto Ruso, un paso atrás, y nos encontramos con que China no consume tanto como estaba previsto, automáticamente los excedentes están ahí. Rusia importaba mantequilla y quesos, los rusos están sustituyendo la mantequilla
por grasas vegetales, no está comprando mantequilla en otros mercados y esto está haciendo mucho daño. Ese problema lo tiene que solucionar la Unión Europea, porque ellos cambiaron el sistema de cuotas a un sistema de libre producción y se equivocaron, tendrán que rectificar y buscar fórmulas para que esto no siga así, de lo contrario vamos a la ruina, todos
¿Están funcionando los contratos?
Unos sí, pero hay empresas en que no, tiene que producirse un cambio de cultura total. La relación de la industria con el ganadero siempre fue una relación de palabra. Los pocos papeles que se firmaban no se cumplía ninguno, querer imponer un nuevo sistema de la noche a la mañana cuesta muchísimo, yo el contrato lo veo bien, porque cada uno tiene que saber, cuando sale la leche de su explotación y a qué precio la va a cobrar. Ahora ya hay empresas haciendo contratos a tres años, en base a precios referenciados a alimentación. Al final el contrato se impondrá porque es de sentido común, pero lo que se necesita es un plan de refinanciación del sector, hacer un estudio de viabilidad de las explotaciones y refinanciarlo en años, según la edad del ganadero.
En el resto de países de la UE, caso de Holanda, Francia, Alemanía, ¿están pasando también por esta bajada tan brutal de precios? Fueron precisamente ellos, los países del norte de Europa quienes quisieron abolir las cuotas.
Yo creo que es el más castigado es España, porque ellos tienen una capacidad de producción que nosotros no tenemos y tienen unos costes de producción mucho más bajos que los nuestros. Nosotros en el país en el que nos tendríamos que mirar es Italia, un país que elabora productos con mucho valor añadido
¿Y la solución fancesa de fijar un precio mínimo al que tienen que cobrar los ganaderos?
Dudo que se puede hacer eso, pero si fuera posible hacerlo debería ser para todos, estamos en un mercado único y no debería haber reglas de juego distintas en unos países que en otros.
¿Sería la solución para la situación en la que nos encontramos?
Si trasladamos cuatro céntimos al consumidor y que eso repercuta en el sector ganadero, para las industrias que están fabricando leche líquida o yogures, perfecto, es muy fácil de hacer, pero ¿y todo lo que va a leche en polvo? todo lo que no pasa por la industria y que se recoge ¿cómo lo hacemos? No es tan fácil hacer una subida lineal de precios de la leche por culpa de la comercialización que tenemos.
Entonces ¿cómo ve usted el futuro?
Tenemos una situación muy clara, hay 17.000 explotaciones de leche en España, lo primero que habría que hacer es plantearse quienes son los titulares de esas explotaciones, que edades tienen y que posibilidades tienen de sucesión, porque si no hay posibilidades de sucesión, esto se acabó y ver las que tengan futuro, con una persona joven y hacer políticas de apoyo porque podemos vernos en una situación que cierren las que puedan continuar y continúen las que van a cerrar por la edad del titular. Así haríamos una radiografía perfecta de las ganaderías que van a quedar en el
“A la industria hay que darle la leche que necesita y la que sobre ni un litro, porque si tu le das a la industria la leche que necesita y le das la que sobre, al final te derrumban los precios”
futuro. La gente joven que está trabajando ahora es la que más endeuda está y no se le puede frenar la capacidad de poder crecer y producir, para un ganadero de 60 años que se sabe que le quedan cinco años en activo, habrá que buscar una solución.
También puede darse el caso de que haya una deslocalización, porque la industria va a intentar por todos los medios tener la producción cerca de los centros de transformación.
¿Es posible que veamos vacas de la Cornisa migrar hacia el interior de la península?
Que nadie olvide una cosa, que el norte tiene vacas, por los prados, y que cada vez los prados significan menos en la producción de leche. Además en el norte tenemos un problema medioambiental que no van a tener ni en Castilla y León ni en Castilla-La Mancha ni en Andalucía, además las inversiones son más caras en el norte que en otras partes.
De todos modos creo que las administraciones deben diseñar un plan para mantener las explotaciones de la Cornisa.
Le ha tocado un periodo difícil como presidente de INLAC
Este sector tiene seis meses buenos y seis años malos. Pienso que la leche va a subir a final de año, pero tampoco sabemos cuánto va a durar. Vamos a un sistema americano donde los dientes de sierra cada vez van a ser más pronunciados y nos vamos a tener que acostumbrar a que cuando este alto el precio, guardar, para cuando este bajo, pero es difícil debido al gran endeudamiento que tienen las explotaciones.


Ha trascurrido un año desde la última vez que se redactaban estas líneas y toca de nuevo hacer una revisión de lo que 2014 ha supuesto para el sector lácteo y para el sector de la mejora genética de nuestra raza, la frisona.
Si bien 2014 se afrontaba con cierta incertidumbre al ser casi el último año del sistema de cuotas, hay que decir que hasta finales del mismo se ha observado que los ganaderos se han arriesgado y han optado por incrementar el tamaño de sus ganaderías, preparándose para el nuevo escenario que se inicia en abril de 2015. Todos saben que el crecimiento de las ganaderías de vacuno lechero no es algo que se pueda hacer de la noche a la mañana, sino que hay que adecuar las instalaciones y las herramientas necesarias para manejar y poner en producción estos animales. De 491.896 reproductoras a 31/12/2013 se ha pasado a 500.500, a 31 de diciembre de 2014 (Cuadro 1), mientras que el número de ganaderías asociadas disminuyó de 7.052, en 2013, a 6.813, en 2014. El tamaño de las ganaderías se incrementa de media de 70 a 73 animales en un solo año.
Sin entrar en demasiados detalles, el precio de la leche y de las materias primas ha permitido respirar un poco a los ganaderos, los cuales han estado muy ocupados tratando de organizarse en organizaciones de productores para poder negociar sus contratos con la industria de igual a igual. Por otra parte, industria y distribución han tratado, en diversos foros, de hacer ver al ganadero que quieren que el sector productor sobreviva, no sabemos bien en qué condiciones, pues a ellos les interesa mantener un tejido productivo. Sospechamos que lo que quieren es cumplir con los mínimos exigidos por la ley de la cadena alimentaria. No es nada nuevo.
En solo un año, el tamaño medio de las ganaderías se ha incrementado de 69 a 73 animales.
En lo que al sector de la mejora y a CONAFE se refiere, ha sido un año positivo en cuanto a objetivos alcanzados. No lo ha sido tanto respecto a las subvenciones provenientes del MAGRAMA, que se han mantenido en el 2,43% del presupuesto de CONAFE, algo a lo que ya nos estamos acostumbrando. No obstante, podemos estar satisfechos de que todo lo que sale adelante es gracias a los ganaderos asociados y, por ello, con más razón tenemos que esforzarnos cada vez más en desarrollar las herramientas que permiten seleccionar mejor a los animales de las ganaderías. En
2014 se ha continuado con el desarrollo de las herramientas asociadas a la genómica, a los nuevos caracteres, a la mejora de las herramientas informáticas y a la gestión de la información.
Recordamos aquí la organización por parte de CONAFE de la 30ª Asamblea y Conferencia de la Federación europea de Holstein, lo que supuso un gran esfuerzo por parte del personal de CONAFE, el cual, además de los objetivos propios de la Confederación, asumió la preparación total de la misma. Como resultado se obtuvo un éxito de convocatoria, con un total de 204 asistentes, de los cuales 140 fueron extranjeros. Y también fue un éxito en lo que se refiere a los temas que se trataron, los retos de la ganadería de selección, con un especial hincapié en que fuera una conferencia orientada al ganadero. Aprovechamos estas líneas para agradecer el apoyo por parte de ASCOL en la organización de este evento.
Finalmente, queremos reconocer también que para todas las actividades desarrolladas se ha contado con la participación y colaboración de las Asociaciones/Federaciones integradas en CONAFE y con el apoyo de las Administraciones, Central y Autonómicas, sin olvidarnos de la mejor disposición que con CONAFE han tenido otros organismos y empresas ligadas de alguna forma con la mejora y selección de la raza frisona. A todos el más sincero agradecimiento.
El Real Decreto 2129/2008, de 26 de diciembre, por el que se establece el Programa Nacional de Conservación y Mejora de las Razas Ganaderas, constituye la base legal del Libro Genealógico y de las actividades que su desarrollo conlleva. Nuestro actual Reglamento del Libro Genealógico fue aprobado por Resolución de la Dirección General de Recursos Agrícolas y Ganaderos el 27 de junio de 2011.
El Libro Genealógico es pilar básico e imprescindible para desarrollar cualquier programa de mejora y de selección de la raza, y en él se inscribe y se mantiene toda la información relacionada con genealogías, calificaciones morfológicas, producciones, índices de mejora, filiaciones genéticas, consanguinidad, premios, méritos y otros, con el fin de que toda esta información esté integrada en una base de datos única, lo que constituye la referencia integradora más amplia de cualquier proceso informático para el desarrollo de la raza frisona.
El Registro de Animales es una de las actividades de la gestión del Libro Genealógico, cuyo servicio se presta a los ganaderos, bien directamente
Cuadro 1. Reproductoras vivas en el L. G. (hembras nacidas entre los años 2003 y 2012)



por CONAFE, o bien a través de las Asociaciones/Federaciones integradas en la Confederación tales como: AFA (Andalucía); AFB (Baleares); AFCA (Cantabria); AFNA (Navarra); AFRICAMA (Castilla-La Mancha); ASCOLAF (Asturias); EFRIFE (País Vasco); FEFRIC (Cataluña), FEFRICALE (Castilla y León) y FEFRIGA (Galicia).
En diciembre de 2014, el número de animales inscritos en el Libro ascendía a 760.554 animales: 756.371 hembras y 4.183 machos (Cuadro 2).
Los registros en el Libro Genealógico de la Raza Frisona Española se dividen en dos secciones: Auxiliar y Principal.
Registros en el año 2014
La inscripción en el año 2014 (Cuadro 3) ha sido de un total de 169.841 animales, lo que indica un incremento respecto al año anterior, de 5.223 animales, es decir, un 3 % más.
Por registros, aumenta en 1.667 animales el Registro Auxiliar “A”, disminuye
Cuadro 3. Registros del año 2014 por CC.AA.

en 507 el Registro Auxiliar B y aumenta en 759 el Registro de Importadas. Disminuye en 18 la inscripción en el Registro de Machos y aumenta en 3.322 animales en el Registro Principal de Hembras.
a) Sección Auxiliar
En el Registro Auxiliar se inscriben las hembras que, poseyendo las características étnicas de la raza, carecen total o parcialmente de documentación genealógica que acredite su ascendencia o incumplen la normativa de la gestión del Libro.
El Registro Auxiliar se clasifica en Auxiliar A, en el que se registraron 12.430 animales durante 2014, y Auxiliar B, con 9.921 animales registrados en el mismo periodo. El total de 22.351 animales representa el 13,16% de todos los animales registrados en el año 2014 en el Libro Genealógico.
b) Sección Principal
La sección Principal del Libro Genealógico se subdivide en varios registros: Principal, Importadas, Toros y Méritos.
1. Registro Principal. En él se inscriben las hembras

el mismo registro. En el ejercicio de 2014 se han registrado 140.474 hembras. Galicia, con 57.095 animales (el 40,64%), es la Comunidad que más registros ha tenido, seguida por Cataluña con 14.808, Asturias con 13.940, Castilla y León con 13.041 y Cantabria con 12.879.
2. Importadas. Se registran las hembras procedentes de la UE y terceros países. En 2014 se inscribieron 5.755 hembras (759 más que en 2013).
3. Toros. Se inscriben en este registro los toros que provienen de otros Libros Genealógicos y los nacidos de padres y madres del Registro Principal. En el 2014 se han registrado 1.261 machos, lo que supone 18 más que el año anterior.
4. Méritos. Los animales inscritos en el registro de méritos son animales incluidos en la sección Principal del Libro Genealógico. Se subdivide en registro de hembras y machos. El Reglamento del Libro especifica los requisitos que deben cumplir los animales para inscribirse en este registro, en sus diversas clasificaciones. En este registro están inscritos 62 machos y 1.159 hembras (Cuadro 4).
activos o vivos
Toros-Padres de los animales registrados en 2014
De las 151.653 hembras registradas en 2014 (excluyendo las de Registro Auxiliar “A” e Importadas), 73.300 son hijas de toros nacionales (el 20,4% son toros con prueba y el 27,9% son toros sin prueba) y 78.353 son hijas de toros extranjeros; de éstos el 38,7% son toros con prueba y el 13,0% son sin prueba.
Se consideran toros extranjeros con prueba aquellos que, bien tienen prueba en el Catálogo Oficial de CONAFE –aunque algunos no aparezcan por no cumplir las condiciones de CONAFE referentes a su inscripción en el L.G.–, o están evaluados por Interbull, tomando como año de referencia el año de las inscripciones de sus hijas.
Son considerados toros extranjeros sin prueba, los que no tienen prueba oficial en CONAFE, y no han sido enviados por CONAFE a la Evaluación MACE de Interbull.
Evolución del L. G. en los últimos cinco años

El Cuadro 5 recoge la evolución del Libro Genealógico y de la selección de la Raza Frisona en España. Se puede observar que el descenso en el número de ganaderías va acompañado de un aumento en el número de reproductoras y en la media de vacas por explotación.
Fiabilidad del Libro Pruebas de Filiación
En diciembre de 2009 se firmó un convenio con el Laboratorio de Genética Molecular de Xenética-Fontao, para realizar las pruebas de filiación mediante la determinación de 17 loci (en algunos casos hasta 30), todos ellos normalizados y homologados por la Sociedad Internacional de Genética Animal (ISAG).
El objetivo de las pruebas de filiación es doble: por un lado conocer la fiabilidad de las genealogías del Libro Genealógico y, por otro, detectar fallos o posibles fraudes en el Libro Genealógico
La extracción de muestras es responsabilidad
de cada Asociación Autonómica, cuyo coste es abonado por CONAFE.
Huellas Genéticas por ADN
En el año 2014 la Junta de Gobierno aprobó la realización de 1.000 muestras aleatorias y dirigidas. La distribución de los análisis se ha llevado a cabo por CC.AA., tendiendo a una proporcionalidad por C.A. en relación con los registros y reproductoras.
Se han realizado un total de 865 muestras y los resultados del muestreo aleatorio han sido de un 5,00% de negatividad.
CALIFICACIÓN MORFOLÓGICA
Se empezó el año con 10 meses y medio de intervalo, finalizando el año con once meses, calificándose 117.628 hembras y visitado 6.917 fincas (Cuadro 6). Durante el año también se calificaron 301 machos y se valoraron 9.598 hembras como Aptas en el registro auxiliar.
Como en años anteriores, Lugo, Cantabria, Pontevedra, La Coruña, Gerona y Asturias son las más interesadas en el servicio de Petición de Parte-Conjunta, habiéndose calificado 960 animales en 60 ganaderías; 106 animales menos y 30 visitas menos que en el 2013.
En cuanto a Petición de Parte Individual se han

calificado 139 animales en 8 ganaderías. En el trascurso del año 2014 se ha mantenido una reunión de unificación de criterios de la calificación morfológica con la participación de los técnicos calificadores y los del Dpto. de Genética, que tuvo lugar en Asturias (12 y 13 de Junio) en las ganaderías La Paloma y Magón.
Cuadro 6. Calificaciones por autonomías y categorías en el año 2014

Ganadería Magón



Ganadería La Paloma

CONTROL LECHERO
CONAFE es la organización responsable de la gestión de la Base de datos nacional de Control Lechero de la raza frisona, según lo establecido en el Real Decreto 368/2005, de 8 de abril, por el que se regula el Control Lechero Oficial del Rendimiento Lechero para la Evaluación Genética en
La media de producción alcanzada en 2014, en lactaciones a 305 días, fue de 9.736 kg de leche, es decir, 190 kg más que en 2013.
las especies bovina, ovina y caprina, modificado por la Resolución de 22 de octubre de 2013, de la Dirección General de Producciones y Mercados Agrarios, por la que se publican las recomenda-
Cuadro 7. Evolución fenotípica en España.

ciones publicadas por el Comité Internacional para el Control de Rendimiento Animal, de acuerdo con las instrucciones de aplicación de las mismas establecidas por la Comisión Nacional de Control Lechero Oficial.
En este sentido, a lo largo del 2014 se han realizado los trabajos habituales relacionados con la gestión y mantenimiento de la Base de Datos nacional de Control Lechero: recepción e integración en la base de datos de lactaciones, de datos de facilidad de parto, velocidad de ordeño e inseminaciones, que se reciben cada dos meses; revisión de datos, elaboración de informes, etc.
En cuanto a la estructura de este programa, en 2014, este servicio ha contado con la participación de 244 controladores, lo que supone una media de 28 ganaderías y 2.051 reproductoras por controlador.
La media de producción alcanzada en 2014, en lactaciones normalizadas a 305 días, fue de 9.736 kg de leche, 353 kg de grasa y 312 kg de proteína. Esto supone un aumento, respecto a 2013, de 190 kg de leche, 4 de grasa y 6 de proteína.
La evolución fenotípica de las lactaciones naturales en los últimos cinco año se muestra en el Cuadro 7 y en el Cuadro 8 se muestran las medias de producción de las lactaciones finalizadas y válidos en 2014.
Cuadro 8. Lactaciones terminadas y válidas en el período de enero a diciembre de 2014. Total nacional

EVALUACIONES GENÉTICAS
Evaluaciones genéticas nacionales
En el Cuadro 9 se muestra el número de lacta-

de longevidad de las vacas se obtienen indirectamente a partir de las pruebas de recuento de células somáticas y tipo.
Cuadro 9. Lactaciones y calificaciones utilizadas en las evaluaciones genéticas

Cuadro 10. Vacas vivas evaluadas y con índices

Evaluaciones internacionales
Las pruebas de descendencia de los toros obtenidas en la evaluación genética nacional se han integrado en las evaluaciones MACE y evaluaciones GMACE que ha realizado INTERBULL en 2014 para producción, conformación, recuento de células somáticas, longevidad y fertilidad.

En los Cuadro 11 y 12 se muestran las correlaciones genéticas utilizadas por Interbull en el MACE de Agosto de 2014 entre España y los principales países exportadores de semen para los 5 grupos de caracteres considerados (producción, recuento de células somáticas, longevidad funcional y conformación). Se aprecia un alto grado de semejanza entre las pruebas de los distintos países incluido España, siendo las correlaciones para los caracteres de tipo incluso superiores a las de producción. Las correlaciones para longevidad son, en general, más bajas que en otros caracteres y son menores entre los países europeos. La razón parece estar en que es un carácter que resume muchos otros caracteres y que en realidad la longevidad de las vacas está muy ligada al tipo de explotaciones y manejo existente en cada país.
Cuadro 11. Correlaciones genéticas de España y los principales países exportadores de semen para los caracteres de kg proteína, RCS, longevidad y D.A.

Cuadro 12. Correlaciones genéticas de España y los principales países exportadores de semen para caracteres de tipo


Las pruebas MACE de Interbull en la base y escala española se combinan en CONAFE con su información genómica cuando se dispone de ella y estas pruebas combinadas son oficiales en nuestro país para aquellos toros extranjeros sin prueba en el Catálogo de Sementales de CONAFE. De forma similar las pruebas GMACE de los toros jóvenes de otros países que no tienen prueba oficial en España también son oficiales.
Entre las tareas realizadas por el Dpto. Técnico en 2014, están –en cuanto a las evaluaciones genéticas tradicionales se refiere–el cálculo de fiabilidad e hijas efectivas de días abiertos con la misma metodología que el resto de caracteres y el análisis de la calidad de la base de datos de controles mensuales.
En cuanto a la genómica, se han realizado mejoras en metodología y procesos, en modelos de evaluación genómica y cálculo de fiabilidad, en la combinación de valores genómicos directos, índices de pedigrí y pruebas de descendencia y en los procesos de evaluación genómica semestrales y mensuales.
También, y entre otras cosas, se ha llevado a cabo la validación y envío de las pruebas genómicas españolas al GMACE y el diseño de chips de baja densidad en el entorno de EuroGenomics.
PROMOCIÓN
Conferencia Europea Holstein y Holstein Roja
CONAFE organizó la Conferencia Europea de la EHRC el 25 de septiembre en Gijón, bajo el tema “Desafíos 2020 para el ganadero de vacuno lechero Holstein”, a la que asistieron 200 personas procedentes de 22 países.
Para desarrollar este tema –estructurado en tres bloques: competitividad, nuevas tecnologías y nuevas herramientas para el productor–, CONAFE, contó con la participación de quince expertos en vacuno lechero, desde genetistas, a ganaderos, para conocer las opiniones y experiencias desde distintos enfoques.
Tras la inauguración por parte de Montserrat Castellanos, del Ministerio de Agricultura, Alimentación y Medio Ambiente y del Vicealcalde de Gijón, Rafael Felgueroso, David Hewitt, Secretario General de la EHRC y Sofía Alday, Directora Gerente de CONAFE, fueron dando paso a las conferencias de una jornada tan apretada como interesante que finalizó con la mesa redonda “El futuro visto por los ganaderos” en la que participaron los ganaderos Erik Hansen (Dinamarca), Markus Gerber (Suiza), Alberto Gandolfi (Italia) y Agustí Prat (España). Moderó Jos Buiting (Holanda).
La Consejera de Agroganadería y Recursos Autóctonos del Gobierno de Asturias, María Jesús Álvarez, se encargó de clausura la jornada.
El programa de la Conferencia –que contó con la colaboración del Ministerio de Agricultura, Alimentación y Medio Ambiente, el Ayuntamiento de Gijón y Ascolaf y el patrocinio de Aberekin, Ascol, Genetical y Xenética Fontao– finalizó al día siguiente con la visita a las ganaderías Badiola y La Corona y al centro de inseminación de Ascol.
También se celebró la reunión de la Asamblea General de la EHRC durante la cual David Hewitt, Secretario general desde 2008, entregó el testigo a Suzanne Harding. Se acordaron entre otras cuestiones celebrar en Hungría la Conferencia EHRC 2017 y la 31ª Asamblea General 31 y celebrar la Confrontación Europea 2019 en Libramont, en Bélgica.


35º Concurso Nacional de Otoño. Gijón
El Nacional de otoño se celebró del 25 al 28 de septiembre en Gijón, coincidiendo como es habitual con la celebración de Agropec. En esta edición participaron 50 ganaderías con 134 animales.
Ganaderías Animales
CC.AA.2013 2014 2013 2014

Se encargó del juzgamiento Jaume Serrabassa Vila,Juez Internacional de CONAFE, quien eligió como Vaca Gran Campeona a Badiola Murdoc Lubasca, de la asturiana Gan. Diplomada Badiola S.L. Lubasca, que había sido nombrada Vaca Joven Campeona, se impuso a su compañera de establo Badiola Damion Koketa, que fue nombrada Vaca Adulta Campeona y Gran Campeona Nacional Reserva.
El título de Gran Campeona Nacional de Novi-

Reportaje enF. E. Noviembre/Diciembre 2014
El Concurso Nacional de Otoño contó con la participación de 50 ganaderías y 134 animales




Mejor Autonomía y Cantabria, con 90 puntos, el se Segunda Autonomía.
Fueron nombrados mejores manejadores del certamen, por este orden, Agapito Fernández, Germán Fernández y Avelino Souto.






XIV Campeonato Nacional de Manejadores
Como parte de las actividades del Concurso Nacional, el 27 de septiembre se celebró el Campeonato de Manejadores que concentró a 28 participantes de distintas edades.
El Campeonato fue juzgado por Jaume Serrabassa y Javier Álvarez, ambos jueces internacionales de CONAFE.
En la categoría infantil el Campeón fue Pere Bosch y el Subcampeón, Pau Sabriá. En la categoría de juveniles, Cristina Carro fue la Campeona y Avelino Souto el Subcampeón. Finalmente, en la categoría se adultos se impusieron José Manuel Sánchez como Campeón y Águeda Capón como Subcampeona.
Otros Concursos
Como en años anteriores, los Jueces Nacionales de CONAFE, han juzgado concursos por toda la geografía nacional e incluso en otros países


-Cid Salgado, Bonet
-Freije Freije, Francisco Javier
-García Souto, Santiago
-González Antón, Conrado
-Juanola Codina, Jordi
-Medina Menéndez, José Manuel
-Paz Conde, José Manuel
-Sabriá Pujol, Joaquín
-Saiz Río, Luis
-Saiz Río, Roberto
-Serrabasa Vila, Jaume
Otras actividades
A lo largo de 2014, CONAFE ha organizado y/o participado en diferentes jornadas, con especial hincapié en las charlas informativas sobre genómica, impartidas en diferentes eventos ganaderos.
Por otro lado, en septiembre tuvo lugar la tercera jornada de unificación de criterios entre podólogos organizada por CONAFE dentro del marco del programa I-SAP (Programa de recogida de Información de Salud Podal, para el control y la prevención de cojeras). El escenario para la sesión práctica fue la ganadería Urbasa S.A.T. (Gozón,


Los podólogos del programa I-SAP en la ganadería Urbasa
Participaron los podólogos Juan Aguilar, Javier Aturrate, Millán de la Pisa, Iker Eletxiguerra, Jesús Fiallega, Aarón Fernández, Icíar Fernández, Andrés Fuentes, Miguel Ángel Franco, Javier García, Joseba Garma, José Enrique Gonzalo, Daniel López, Emilio López, Hugo López, José Antonio Pérez, Jesús Rivera y Miguel Varela.
Títulos a animales y ganaderías
Como cada año, CONAFE otorgó los diferentes títulos y reconocimientos a las hembras y explotaciones, que se conceden después de cada evaluación genética.
En 2014, el título de Maestro Criador, que se concede tras la evaluación de noviembre y que solo se puede obtener cada diez años, correspondió a las siguientes ganaderías:
Caravillas – Lugo
Casa Celedonio – Asturias
Chiquero – Toledo
El Barro, S.C.L. – Salamanca
Granda Longa Sdad. Coop. Galega – A Coruña
Granja Pino Palmera, C.B. – Cádiz
La Cascajera – Palencia
S.A.T. Capador – Lugo
S.A.T. Casa Caetano Xuga 1299 – Lugo
S.A.T. Rial 1171 Xuga – A Coruña
Soc. Coop. Los Arenales-Granja – Salamanca
Tahoces, S.C. – Asturias
Vieitez – Pontevedra
Villa Conchita, S.C. – León Xuana - Lugo
Federación Frisona de Cataluña (Fefric). Jaume Serrabassa fue el director técnico de estas jornadas en la que participaron de 56 ganaderos y técnicos.
Se contó con la colaboración de quince ganaderías: de Barcelona, Can Soca, Mas Isern, El Pinos Nou, SAT Vilatortella, Mas Palou (Caramatxel), L´Era d´en Sola y el Campgran; de Girona, Can Pou, SAT Can Pol y Mas La Roca; de Lleida, Ramadería Hortets, Ramadería Marí, Ramadería

Como todas las secciones tuvieron lugar en el Esta edición de la Escuela se completo con la visita opcional a tres de las ganadería colaboradores: El Campgram, Mas Isern y Vilatortella.












Formación y diversión de nuevo se dieron la mano en la Escuela de Preparadores de 2014 que congregó a 23 participantes, de los cuales 18 eran menores de edad y de estos, 7 tenían entre 11 y 14 años
9ª Escuela de Preparadores
El IES de Luces (Asturias), acogió la novena edición de la Escuela de Preparadores que se celebró del 30 de junio al 4 de julio. Asistieron veintitrés participantes que se distribuyeron en cinco equi-

De izquierda a derecha: Jorge Vázquez, Marcos Rivas y Avelino Souto elegidos 3º, 2º y 1º Manejador de la Escuela de Luces

CONAFE, quien contó con la colaboración de los técnicos calificadores Juan Manuel Fernández y Santiago Mato.
Al finalizar la Escuela se eligió como mejor equipo, por la preparación y mantenimiento de sus animales y del stand, el “La France”, seguido por “S.A.T. La Estrella”. En el Campeonato de Manejadores alcanzaron las primeras posiciones, Marcos Rivas López en la categoría de adultos, Avelino Souto Rozados en la de juvenil y Jorge Vázquez Cudaño en la categoría infantil. Y en el Campeonato de Preparadores María Manteiga en la categoría de adultos, Iván Torrado Morado en la categoría juvenil y Julia Serrabassa Batalla en la infantil.
Se contó con el apoyo económico de Caja Rural, ASA y el Servicio de Podología Pura. Como en ediciones anteriores, Juan Prado y Ángel Amandi, del IES de Luces, prestaron su desinteresada colaboración.
OTRAS ACTIVIDADES
Internas
Además de todas las actividades específicas que se resumen en el transcurso de esta memoria, CONAFE está presente en todas aquellas actividades propias del desarrollo del Libro Genealógico. También interviene en foros cuyo objeto es el desarrollo, promoción e intereses de la ganadería de leche.
En 2014 CONAFE ha formado parte de los siguientes Comités Nacionales:
• Comisión Nacional de Control de Rendimiento Lechero.
• Comité de Secretarios de FEAGAS
• Comité Técnico de FEAGAS
• Mesa de Acuerdos, en la que participan los programas de testaje y CONAFE.
• Foro de Control Lechero de CONAFE.
Externas
La presencia de CONAFE en el extranjero es cada día más asidua e importante. Durante el año 2014, CONAFE ha formado parte de los siguientes Comités y Subcomités; en los que han intervenido el personal de CONAFE especializado en cada tema:
• Comité Permanente de Secretarios Ejecutivos de la EHRC. Miembro del Comité Ejecutivo de Asociaciones Europeas.
• Subcomité de Calificación y Juzgamiento de la EHRC. Miembro del Comité Ejecutivo.
• Comité Europeo de Jueces. Miembro del Comité Ejecutivo.
• Comité Mundial de Calificadores. Miembro del Comité Ejecutivo.
• Reuniones anuales de ICAR e Interbull.
• Reuniones del Steering Committee y del Board de EuroGenomics.
SOCIOS DE CONAFE Y REPRESENTACIÓN EN VOTOS
A 31 de Diciembre de 2014 permanecían 6.813 ganaderías dadas de Alta en el L.G. Esta cifra representa 239 ganaderías menos que en el año anterior. En cuanto a reproductoras, hay un aumento de 8.604 animales.
De acuerdo con los Estatutos vigentes de la Confederación, la distribución de votos de las Asociaciones/Federaciones que constituyen CONAFE es la que figura en el Cuadro13.
celebradas en Asamblea General Extraordinaria, el 22 de junio de 2011, la Junta de Gobierno está compuesta por: Presidente AFCA (Cantabria)
de la Vega Delgado
Vicepresidente ASCOLAF (Ppdo. de Asturias).
José Emilio García Suarez
Secretario AFB (Islas Baleares).
Jaime Olascoaga Enseñat
Tesorero FEFRICALE (Castilla-León).
José Antonio Hernández Martín
Interventor FEFRIGA (Galicia).
José Carlos Vega Rodríguez
Vocales AFA (Andalucía).
Antonio Casas García
AFNA (Navarra).
Carlos Prat Castillejo AFRIARA (Aragón).
Carlos Manuel Sánchez García
AFRICAMA (Castilla-La Mancha).
Alejandro Arasanz Balongo
AFRIDEMA (Cdad. de Madrid).
Miguel González de Parla EFRIFE (País Vasco).
Valentín Novales Elejalde
FEFRIC (Cataluña).
Agustí Prat Aguilar
Directora Gerente:
Sofía Alday Martínez de Cestafe
Cuadro 13. Socios de CONAFE y representación en votos


A la izquierda, San Cristobal Lauri Mtoto ET (2004)
A la derecha, Badiola Goldwyn Megamara ET (2011)
Como vienen siendo habitual tras las evaluaciones genéticas, CONAFE concede los títulos de Vaca Medalla de Oro y Vaca Estrella para reconocer a aquellas vacas que combinan una alta producción, una conformación superior y una adecuada longevidad.
El título de Vaca Medalla de Oro (VMO) se concede a las vacas que han conseguido tres es-


mente, la madre y Vaca Estrella en cuestión también cumple con las exigencias que se piden a sus hijas. En el caso de Vaca Estrella por hijas procedentes de trasplante de embriones (VEE), aparece un asterisco (*) junto al nombre.
Los requisitos necesarios para obtener estos títulos se pueden consultar en www. conafe.com.
Las vacas vivas en el momento de calcular la evaluación aparecen resaltadas en color. Se indica el criador y propietario actual o último conocido y su provincia; en caso de no coincidir, se especifican ambos.
A continuación aparecen los títulos correspondientes a la evaluación de junio de 2015


Número
Nombre
Propietario actual o último




Los programas de mejora genética tratan de identificar a los animales portadores de los genes más interesantes para la mejora de la rentabilidad de las explotaciones. Una vez conocidos, para obtener progreso genético tratamos de favorecer que esos genes pasen a la siguiente generación usando a los animales que los portan como reproductores, optimizar este progreso implica el uso masivo de los mejores animales. Ir acumulando estos genes interesantes implica obviamente aumentar la consanguinidad.
Llevar control del nivel de parentesco a la hora de diseñar los acoplamientos ha sido siempre una preocupación para todo ganadero. Los argumentos para tener cuidado con este tema han sido evitar la denominada depresión por consanguinidad, que afecta a algunos caracteres de importancia, especialmente se detectan estos efectos en aquellas características relacionadas con la reproducción. Además, los problemas más fácilmente identificables han sido la aparición de enfermedades de origen genético asociadas a genes recesivos.
En relación con estos últimos, a lo largo de la historia se han ido describiendo diferentes enfermedades como el BLAD, BRACHYSPINA, CVM… Más recientemente y como comentábamos en el número 199 de la revista, el genotipado masivo de la población ha permitido descubrir nuevos caracteres recesivos que se engloban en los denominados Haplotipos que afecta a la fertilidad. Recordemos que se trata de secuencias concretas del genoma que siendo frecuentes en la población, no se encuentran en homocigosis (la misma secuencia en el cromosoma de origen paterno y en el de origen materno) en ningún individuo. Y esto es debido a que los embriones homocigóticos con esta secuencia no llegan a desarrollarse plenamente y se interrumpe la gestación.
Nuevo haplotipo que afecta a la supervivencia de las terneras
Gracias a la genómica se puede conocer por tanto que regiones son las problemáticas y centrar el control de la consanguinidad en esas zonas. Hoy presentamos un ejemplo que ha recibido una gran atención desde que se presentase en la última reunión de Interbull a mediados del pasado Julio (Kipp et al, 2015). Se trata del denominado haplotipo HDC que a diferencia de los haplotipos de los que hablábamos previamente no está relacionado con muertes embrionarias, sino que los animales nacen sanos pero mueren a los pocos meses. Esta diferencia hace mucho más difícil descubrir el problema y le da aún más valor a los siste-
mas de recogida de información en graja. Gracias a ellos se ha podido evolucionar hasta donde nos encontramos y cada día tenemos más ejemplos de porqué sigue siendo el factor clave para asegurar la mejora genética en el futuro. La historia de este descubrimiento es realmente interesante:
En una granja Alemana se dieron casos de muerte de terneros de algunas semanas o meses tras sufrir diarreas que no era posible controlar. A la ganadera le gustaba conocer la genealogía de sus animales y empezó a indagar sobre los orígenes de los animales que sufrían esta enfermedad, se dio cuenta de la presencia de Storm en la mayoría de ellas y de que solía aparecer en más de un caso. Posteriormente en otra ganadería donde se detectó el mismo problema se confirmó la presencia de este toro en los orígenes paternos y maternos simultáneamente de los animales afectados (Figura 1).
Tras un proceso de investigación con algunos animales afectados se encontró que los animales heterocigóticos (una sola copia) presentaban niveles bajos de colesterol, pero los homocigóticos no y sin él sólo sobreviven unos meses (Tabla 1). En este caso, es igual de malo que para nosotros tener niveles muy altos. A partir de un estudio de asociación (GWAS) se detectó una región del cromosoma 11 muy relacionada con esta patología.
Estudiando la presencia de la secuencia problemática en la población a través de los animales genotipados se observó que esta aumentó desde menos del 1% en el año 2000 a más del 10% a partir de 2010, lo cual no es de extrañar teniendo en cuenta la presencia de Storm en la genealogía de

Se estima que en Alemania nacen unos 3400 animales homocigotos que se verán afectados al año lo que supone unas pérdidas aproximadas de 1.3 millones de Euros que serían fácilmente evitables evitando acoplamientos entre portadores.
Un problema añadido para la identificación de los portadores es que algunos de los animales homocigotos no presentan la enfermedad. La secuencia problemática procede del bisabuelo materno de Storm, Fairlea Royal Mark nacido en 1966, que es a su vez el padre de Mark Anthony, pero este último aunque tiene la misma secuencia de SNPs no es portador del problema, la mutación apareció por tanto en el propio Storm, en su madre Tacy o en su abuela Gail (Figura 2). Por tanto los animales que tienen al menos una copia procedente de Mark Anthony aunque con el análisis genómico aparezcan como homocigotos, realmente no van a presentar la enfermedad.
De esa misma época tenemos al animal Meadow Bridge Inspire ET TL TV y a Nordkap que están en la misma situación que Mark Anthony. Por tanto es necesario un análisis conjunto del genotipo y de la genealogía para determinar si un animal es portador, si tiene riesgo de serlo o si es un falso positivo. Este es un ejemplo más de la importancia de la correcta asignación de paternidades y del mantenimiento de una genealogía fiable de nuestra población.
A partir de las secuencias de genoma completo se ha tratado de encontrar la mutación (que no está en ninguno de los SNPs del 50K) pero de momento no se ha dado con ella.
En la población registrada en CONAFE, el número de descendientes de Storm es de 658.849 con 641.436 vacas ESPH de las cuales tienen a este toro en su genealogía materna y paterna 38448, 8803 ya están dadas de baja, de estas 757 un 8,6% murieron entre los 21 y 180 días de edad, el periodo indicado por los Alemanes. A modo de comparación los descendientes que sólo tienen a Storm una vez y por tanto si la genealogía es correcta estarían libres de la enfermedad y están dados de baja son 234848 de los cuales murieron en ese periodo 8696, un 3,7%.
Obviamente es un factor a tener en cuenta, a partir de Septiembre se calculará el estatus para todos los animales genotipados, se incluirá en la próxima versión del informe de recesivos para aquellos ganaderos que así lo soliciten usando el nuevo formulario disponible en la web de CONAFE y se incorporará al programa de acoplamientos. Como se comentó al principio, esto no es más que trabajar en el control de la consanguinidad directamente sobre las regiones problemáticas, por tanto no debemos alarmarnos ni rechazar el uso de animales mejorantes por el hecho de ser portadores de este o de problema genético, el progreso que nos han proporcionado los animales de esta familia, supera con creces este tipo de inconvenientes. Como ya se ha comentado, los problemas que antes se descubren son aquellos que afectan a los mejores toros (porque son los más usados). El mensaje importante es que gracias a los programas de acoplamientos se puede gestionar esta información y evitar los problemas de forma eficiente, por supuesto mucho más si las hembras están genotipadas.
Análisis de nuestra población.
Una vez recibidos los resultados completos de Alemania se ha definido el haplotipo tratando de diferenciar a los descendientes de Storm de los descendientes de Mark Anthony que teníamos genotipados. Se han analizado 11352 animales que tienen resultado en Alemania, de los cuales 393 fueron identificados como portadores.
Tabla 1. Comparativa en los niveles de Colesterol y triglicéridos de tres animales con los tres posibles status respecto al haplotipo HDC


Fairlea Royal Mark CANM0000299855
Wykholme Dewdrop Gail ET CANH0003399564
Wykholme Dewdrop Tacy ET BL RF CANH0004467150
Storm CANM0005457798
Willowholme Mark Anthony CANM0000334489
Normac Royal Mistress CANH0002905964
Meadow Bridge Inspire ET TL TV ESPM0000028294

A partir de los genotipos y la genealogía disponible se han encontrado 360 haplotipos iguales al de Storm. De ellos 202 tenían a este toro en la genealogía y no a Mark Anthony o alguno de los otros toros que se comentaron antes. 128 tenían a Storm pero también alguno de los otros por lo que se les consideraría posibles portadores, 14 sólo tenían a Mark Anthony, Inspire o Nordkap y por tanto serían falsos positivos y otros 16 en principio no eran descendientes de ninguno pero se marcarían como posibles portadores (Tabla 2).
Los 202 animales confirmados como portadores coinciden con los resultados distribuidos por Alemania. De los 128 animales posibles portadores
126 han sido declarados en Alemania como portadores mientras que dos aparecen como libres, los Falsos Positivos 13 han sido catalogados como portadores en Alemania y uno como libre y de los 16 en los que no aparece ningún ancestro de los evaluados 10 están marcados como portadores en Alemania y 6 como libres.
De los 42 animales positivos en Alemania que no se identifican con el haplotipo definido por CONAFE 15 animales presentan a Storm en la genealogía mientras que el resto serían posibles portadores o falsos positivos.
Del listado de 202 portadores confirmados los toros nacionales con más hijas serían Bos Emerson Ginebre ET, Badiola Megano y Tejos Havadu Talon ET.
Para Recordar
Como conclusión, queda una vez más demostrado como las nuevas herramientas que tenemos a nuestro alcance como son el genotipado de las terneras, incluyendo la información de recesivos y el uso de programas de acoplamiento adecuados nos permitirán solventar una parte importante de los problemas relacionados con el incremento inevitable del nivel de consanguinidad de la población.
Bibliografía: S. Kipp, D. Segelke, S. Schierenbeck, F. Reinhardt, R Reents, C. Wurmser2, H. Pausch, R. Fries, G. Thaller, J. Tetens, J. Pott, M. Piechotta, W. Grünberg. 2015. A new Holstein Haploytpe affecting calf survival. Interbull Meeting 11/07/2015 Orlando, FL, USA.


Como vimos en el artículo anterior, el carácter facilidad de parto se ha codificado en tres clases principales en función de cómo se ha producido el parto de la vaca.
La clase 1: se refiere a los partos “fáciles”. En esta clase se agrupan dos tipos de datos diferentes:
•Los partos que el ganadero ha visto han ocurrido sin problemas, es un parto normal sin ayuda humana.
•Los partos que se han producido en ausencia del ganadero y que tanto el ternero como la madre están sanos. El ganadero no tiene forma de discernir qué ha ocurrido en su ausencia, así que clasifica estos partos como fáciles.
Las clases 2 y 3 son partos distócicos; son aquellos que necesitan (o hubieran necesitado) la intervención del hombre para que el nacimiento se produzca con éxito. Las intervenciones posibles del ganadero pueden ser:
• Tracción ligera: cuando es necesaria una pequeña ayuda del ganadero para que el parto llegue a buen fin. El ternero nace sin problemas añadidos. Este tipo de ayuda pertenecería a la clase 2 (o ligera dificultad) que hemos codificado para la evaluación genética. Estos partos son aquellos en los que el ternero habría nacido de cualquier forma sin ayuda.
• Tracción fuerte: cuando hay que insistir en la ayuda al ternero para salir. El parto es complicado y se necesita tiempo y la pericia del ganadero para que el ternero nazca.
• Cesárea: cuando para la supervivencia del ternero es necesaria la intervención quirúrgica.
• Fetotomía: es la intervención más complicada, fatal para la vida del ternero, y sólo se produce en casos extremos para salvar la vida de la madre.
Las tres últimos partos distócicos, debido a su pequeño volumen en relación a la masa de datos, se han agrupado en la clase 3 (parto difícil) de fa-


Delfino Hernández. Dpto. Técnico de CONAFE
cilidad de parto. En la clase 3 hay que añadir también aquellos partos donde el ganadero observa “a posteriori” del parto, severos problemas bien en el ternero, la vaca o en ambos.
Aunque aparentemente las diferencias entre las clases es clara, puede haber cierta confusión para discernir netamente la diferencia entre las clases 1 y 2. En la tabla I se muestran las diferencias que se observan entre las distintas regiones donde se recoge el dato.
En principio no se ha seleccionado por este carácter en la población española, por lo que su distribución debería ser similar en las diferentes regiones. Sin embargo, se observa como en alguna región el porcentaje de partos de la clase 1 supera el 88% del total (región G) y en otras regiones la clase 2 es la más numerosa llegando en torno al 80% en la región F.
Además la clase 3 tiene una media de 3,5 % del total de datos. Esta media es bastante más baja de lo descrito en la bibliografía, donde, como mínimo, es superior al 5% de los partos. Como se describió en el anterior artículo, los partos difíciles son más frecuentes en novillas que en vacas que ya han tenido otro parto.
Para tratar de limpiar los datos de controles inexactos, se hizo una segunda criba de los datos, eliminando aquellos rebaños donde los partos de la clase 3 en novillas de primer parto no alcanzaran el 3% del total. Con esto, se pretende eliminar, al menos en parte, el sesgo que presentan los datos.
En la tabla II se muestra la distribución de los datos después de esta segunda depuración. La región D desaparece del conjunto de datos por no llegar al mínimo exigido. Se puede observar cómo las diferencias entre las clases 1 y 2 entre las regiones se han suavizado sensiblemente. Igualmente, se observa que al eliminar los rebaños donde no se recogía bien el dato, la clase 3 tiene una media dentro de los rangos normales citados en la literatura.
Desde CONAFE pedimos a todos los implicados en la recogida de datos de facilidad de parto un esfuerzo más para hacer más comprensible la diferencia entre lo que definimos como parto fácil y con ligera dificultad, dicho de otro modo, lo que hemos definido clase 1 y clase 2.
Recuerda

Parto fácil es todo aquel que se ha producido sin la ayuda humana y donde tanto la madre como el ternero están bien. Aquí hay que incluir esos partos exitosos que se han producido en ausencia del ganadero.
Parto con ligera dificultad es aquel en el que hemos tenido que intervenir ligeramente, para no alargar el momento del parto y evitar un posible sufrimiento de la vaca o del hijo, pero sin nuestra ayuda se habría producido igualmente.





En este número hablaremos sobre una de las familias seguramente más conocidas por la mayoría de los ganaderos. Además, es un fantástico ejemplo para ilustrar la relación entre las familias de vacas tradicionales que destacaban en los concursos morfológicos y en ocasiones se utilizaban como madres de sementales, las vacas con altas producciones y excelente conformación que habitualmente han liderado los rankings genéticos y las recientes pruebas genómicas de terneras. En esta familia encontramos excelentes animales por cualquiera de los criterios que han definido a las buenas vacas. Como por otro lado no podría ser de otro modo.
Badiola Formation Megate I (ESPH3301461817)
Con la cuarta generación de vacas nacidas ya en España llegó la vaca que da nombre a la familia Badiola Formation Megate I , nacida en 1998, que ha dejado un total de 29 crías entre las que encontramos algunos toros de inseminación artificial como Megagipsy Megagenio o Megalonso. En la actualidad acumula un total de 23 Estrellas y fue galardonada como Vaca Superior en ICO en 2002. Su calificación final fue de 87 puntos con 91 en Estructura y capacidad, 88 en Sistema Mamario y Estructura lechera y 84 en Patas y Pies, su ICO actual es de 2097.
De sus hijas vamos a destacar seis: Megamática, Megamara, Megate I, Megate II, Megatelva
y Megate, todas nacidas en Ganadería Diplomada Badiola, de Asturias.
Badiola St. Megamatica ET (ESPH3302253141)
De esta hija nacida en 2003 han nacido los animales con un mayor nivel genético de la familia, a través de su hija Badiola Champion Megatea (ESPH3302538625) Vaca Superior ICO en 2008. Esta vaca, calificada 2 veces Excelente, tiene además un gran palmarés en concursos, destacando el título de Novilla Subcampeona CONAFE’06 y el de Vaca Intermedia Campeona en el Nacional de Primavera 2009. Megatea destaca también con su producción ya que en cuatro lactaciones (1.765 días) ha dado 77.900 kilos de leche.
Entre los descendientes más destacados de Champion Megatea se encuentra Badiola Goldwyn Megatea I (ESPH3302846614), calificada MB-87, que también obtuvo el título de Vaca Superior ICO en 2010 y se alzó con el subcampeonato de vacas jóvenes en Gandagro 2010. Actualmente su hija Badiola Shottle Megatea I (ESPH3303298675), MB-86, es el animal con mayor nivel genético de la familia con 3807 puntos de ICO tras la evaluación de Junio de 2015 que la sitúan en el puesto 7 de las mejores vacas por ICO. En esta línea de la familia destacan como vaca genómica Campa Mascalese Megatea (ESPH1503894076) con 3360 de ICO-G y su hija Campa Ma Kng Megatea Fiv ET (ESPH1504138485) nacida en marzo de este año y que tras su valoración genómica tiene un valor IGO-G de 3593. Otras descendientes destacadas de esta línea


son Badiola Doorman Melisa (ESPH3303953082) con ICO 3295, y la descendencia de Blancoh. Duplex Megatina ET (ESPH3602894260), calificada MB-86, Vaca Superior ICO 2010 y primera en la sección de vacas de 30 meses del concurso de FEFRIGA 2010. Entre la descendencia de esta vaca nos encontramos tres hembras genómicas con valor superior a 3000 Blanco Megamery (ESPH3603888132), Blanco Megabrac (ESPH3603818472) y Blanco Megamila (ESPH3604052430).
Badiola Goldwyn Megamara ET (ESPH3302670434)
Esta vaca, calificada Excelente, fue Superior ICO en 2008, ha sido galardonada por su producción vitalicia en 2014 con 101.719 litros de leche producidos en seis lactaciones y obtuvo el título de Vaca Medalla de Oro con seis Estrellas en junio de 2012. De su descendencia destacamos a Badiola Shottle Megaluchy (ESPH3303296566) calificada como superior ICO en 2012 y que actualmente tiene un valor de 2451 y sobre todo su hija Ponderosa Snowman Megamara (ESPH2503608631) con ICO-G 3303.
Badiola Leduc Megate I (ESPH3301904576) Esta
de la familia es la más laureada a nivel de concursos morfológicos, destacando el papel de


Calbrett Starbuck Megan ET ESPH5000362130 Albaproget Megan Blackstar-ET ESPH5000689940
Badiola Astre Megane ESPH3301100079

ICO 2475
Badiola Goldwyn Megatea ESPH3302846614 ICO 3133
Badiola Shottle Megatea 1 ET ESPH3303298675 ICO 3807
Campa Mascalese Megatea ET ESPH1503894076 ICO 3360
Campa Ma Kng Megatea Fiv ET ESPH1504138485 ICO 3593
Campa Dempsey Megatea ESPH1503795982 ICO 3258
Campa Megafashion ESPH1503518416 ICO 3148
Campa Atwood Megafashion ESPH1504045067 ICO 3024
Eiras Shottle Megatea ET ESPH1504091611 ICO 3181
Badiola Duplex Megania ET ESPH3302807305 ICO 2238
Badiola Atwood Megania ESPH3303466664 ICO 2742
Badiola Doorman Melisa ESPH3303953082 ICO 3295
Badiola Lauthority Megapury ESPH3303648151 ICO 2388
Badiola McCutchen Megapili ESPH3303956096 ICO 3090
Blancoh. Duplex Megatina ET ESPH3602894260 ICO 2322
Blanco Megatila ESPH3603258434 ICO 2648
Blanco Megamery ESPH3603888132 ICO 3275
Blanco Megabrac ET ESPH3603818472 ICO 3061
Blanco Megan ESPH3603792099 ICO 2404
Blanco Megamila ESPH3604052430 ICO 3217
Badiola Shottle Megaluchy ET ESPH3303296566 ICO 2451
Ponderosa Snowman Megamara ESPH2503608631 ICO 3303
Badiola Damion Megamary ESPH3303093562 ICO 1984
Badiola McCutchen Megaclara ESPH3303874583 ICO 3133
Badiola Roumare Megamara III ET ESPH3302914746 ICO 2549
Badiola Sid Megamara ESPH3303577613 ICO 2299
Badiola Doorman Megamina ESPH3303874589 ICO 3074
Badiola Goldwyn Megate I ET ESPH3303045423 ICO 2710
Badiola Shottle Megadonna ET ESPH3303471038 ICO 3112
Badiola Epic Miranda ET ESPH3303868139 ICO 3134
Badiola Shottle Megadelia ET ESPH3303471037 ICO 3057
Badiola Duplex Megana ET ESPH3302848556 ICO 2669
Badiola Goldwyn Megachel ESPH3303178113 ICO 2967
Badiola Alexander Megacheca ESPH3303470461 ICO 2301
Badiola Doorman Megachelsy ESPH3304075212 ICO 3074
Badiola Shottle Megana ESPH3303350353 ICO 2986
Badiola Stormatic Megaty ESPH3302208700 ICO 2036
Badiola Goldwyn Megaty IV ESPH3302971974 ICO 2961
Badiola Uno Megaty ESPH3303956089 ICO 3092







Más información en la página 87 de este número
Badiola Champion Megatea ET (Foto 2009)
en el Nacional CONAFE’15, acumula en su haber los títulos de Gran Campeona de Gandagro 2012 y 2015, así como el de Adulta Subcampeona Gandagro 2015. Su hija MB-88 Badiola Shottle Megadonna (ESPH3303471038) es otra “reina” de las pistas con los títulos de Joven Campeona CONAFE’13, Intermedia Campeona CONAFE’14 y Gran Campeona Reserva Gandagro’15. Además, esta vaca tiene una valoración ICO 3112, superado por su hija Badiola Epic Miranda (ESPH3303868139) que tras ser genotipada tiene una valoración de 3134.
Badiola Leduc Megate II ET (ESPH3301904577)
La hermana completa de Leduc Megate I también obtuvo el título superior ICO 2004, que identifica a las 1000 mejores vacas de cada evaluación, y como ternera obtuvo el primer puesto en su categoría en el nacional de 2001. Su hija Badiola Stormatic Megaty (ESPH3302208700) está calificada 2 veces Excelente, ambas con 92 puntos, y tiene un amplísimo palmarés en concursos, destacando el título de Vaca joven Campeona CONAFE’05 y los de Intermedia Subcampeona CONAFE’06 y Primavera’07. Además también se encontraba entre las vacas con título Superior ICO en 2006. A nivel genético actual destaca una descendiente suya con ICO 3092, Badiola Uno Megaty (ESPH3303956089).
Badiola Goldwyn Megatelva ET (ESPH3302917448)
De Megatelva, calificada Excelente y con 72.437 kilos de leche producidos en cuatro lactaciones finalizadas y una en curso, destaca su hija Badiola Sanchez Megatelia (ESPH3303466659), Vaca de Mérito por ICO en noviembre de 2014, que con un ICO 3052 se sitúa entre las 1000 mejores vacas tras la evaluación de junio de 2015.
Badiola Roy Megate ET (ESPH3302426959)
La última hija que hemos incluido en este artículo es Roy Megate, EX-90, que destaca por su calificación ICO Superior en 2007 y sobre todo por ser la madre de Badiola Goldwyn Mensula (ESPH3303044944) de nuevo entre el top 1000 (Superior ICO) en 2011. Ménsula, EX-92, fue la Adulta Subcampeona de Gandagro’14, pero antes formó parte del grupo de vacas con el que a España participó en la Confrontación Europea celebrada en Friburgo (Suiza) en 2013.
Badiola Goldwyn Megatea (Foto 2010)
Su construcción compacta, una sola unidad central que controla hasta 5 cabinas y los amplísimos detalles técnicos desarrollados por especialistas en ordeño hacen del sistema MIone un sistema pionero en eficiencia y sostenibilidad.
MIone – un en desempeño.
GEA Farm Technologies Ibérica S.L.
Avda. Sant Julià 147, 08403 Granollers, España
Telefono: +34 938 617 120, e-mail: agricola@geagroup.com www.gea.com



Introducción
El listado de hembras genómicas menores de 18 meses tras la evaluación mensual de Julio 2015, está dominado por las hijas de Gener Biffer Huma 1048 ET, en concreto por Gener Bluba Bombero 1389 ET, Gener Touchdown Blisa 1377 ET y Gener Bulma 1367 ET que ocupan las tres primeras posiciones con unas valoraciones de 4417, 4360 y 4281 puntos de ICO respectivamente. También encontramos a Gener Touchdown Blua 1382 ET en el puesto siete con 4047, sin olvidar a Gener Bluma Supersire 1245 ET y Gener Bliuma Supersire 1243 ET que abandonaron este listado al cumplir los 18 meses, pero que junto a Huma, la madre de esta saga, se mantienen entre las diez mejores hembras genómicas mayores de 18 meses por ICO. Hasta la
fecha ninguna vaca había conseguido colocar a tantas hijas en la parte superior de los rankings; pronto llegará la cuarta generación de esta familia genómica que comenzó con Ge-Glen-DHaven Biffy Plane ET la mejor hembra genómica del 2009.
Las otras novedades de este listados son Mono Lapiedra Superlola ET en el puesto 15 con 3914 y cerrando el listado Cundins Crisis Altameteor con 3863
La mejor ternera que no es producto de embrión es Cavallería Mogul Medula con 4188 en el puesto 5 y la mejor ternera hija de un toro nacional Teixeiro Barman Glibar ET con 3999 en el puesto 12.
TOP 20 en ICO tras el genotipado
En la Tabla 1 aparecen las 20 mejores novillas genómicas de la evaluación de julio.

TOP 5 en Kilos de Leche
El dominio de las Huma en ICO también se refleja en Kilos de Leche donde Blisa y Bluba adelantan a su hermana Bulma. También entra en este listado Thos Meridian LLeona con 1712 Kg de leche (Tabla 2).
TOP 5 en Kilos de Grasa
En Kilos de grasa de nuevo aparecen cuatro nuevas incorporaciones: Ulloa XF Blanca 224 ET, Thos Overbay Creulina, San-Rian Bailista Balisto y Lscg 79 Jabir FIV ET en lo más alto del ranking (Tabla 3).
TOP 5 en Kilos de Proteína
En este ranking entran tres nuevas terneras, las dos hijas de Huma que lideran el ranking por ICO y por encima de ellas con una valoración de 63 Kilos de proteina San-Rian Noray Balisto Fiv ET (Tabla 4).
TOP 5 en IPP
En el número anterior había una errata en este listado, los valores que aparecían eran los valores genómicos directos en lugar de los valores genómicos combinados (pedigrí + genómica) que son las pruebas oficiales. La mejor ternera genómica en IPP sigue siendo Arenas Noe Jett Air pero su valor genómico oficial es 2,40 en lugar del 2,93 que correspondía al valor genómico directo. La única incorporación a este listado es San Miguel Torrel 734 con 2,20 en el puesto 3 (Tabla 5).
TOP 5 en ICU
Un número más y ya van 4 el ranking por ICU lo lidera C.A.P. 3510 San-Rian Alta5g ET, en este número aparece en segunda posición Blanco Rose Bethany con 3,06 (Tabla 6).
TOP 5 en RCS
El listado de recuento se mantiene copado por las 5 medias hermanas con las encabezado por Llera Doorman Nenita con 133 (Tabla 7).
TOP 5 en Longevidad
En este número sólo tenemos una incorporación al listado por Longevidad se trata de Caseriodernes 5G Aro con valor 140 (Tabla 8).
TOP 5 en Dias Abiertos
En el top por días abiertos se mantienen las mismas 5 terneras que aparecían en el número anterior, encabezado por Vistahermosa Brendy Tama y Campa Jabir Leona con 126 puntos en este carácter (Tabla 9).
Ganaderías con más novillas en el Top 200 por ICO tras el genotipado
En el listado de ganaderías con al menos 4 terneras en el Top 200 genómico nos encontramos tras el genotipado de los dos últimos meses con un empate entre Mas Gener S.C.P. y Ramadería Can Thos S.L. que colocan en este listado 20 terneras cada una aunque en esta oca-
Tabla 2. Listado de las 5 mejores novillas genómicas españolas de menos de 18 meses por Kilos de Leche tras la evaluación de Julio 2015.

Tabla 3. Listado de las 5 mejores novillas genómicas españolas de menos de 18 meses por Kilos de Grasa tras la evaluación de Julio 2015.

Tabla 4. Listado de las 5 mejores novillas genómicas españolas de menos de 18 meses por Kilos de Proteína tras la evaluación de Julio 2015.

Tabla 5. Listado de las 5 mejores novillas genómicas españolas de menos de 18 meses por Ínidce de Patas y Pies - IPP tras la evaluación de Julio 2015.

Tabla 6. Listado de las 5 mejores novillas genómicas españolas de menos de 18 meses por Ínidce Compuesto Ubre - ICU tras la
de Julio 2015.


Tabla 8. Listado de las 5 mejores novillas genómicas españolas de menos de 18 meses por Longevidad tras la evaluación de Julio 2015.

Tabla 9 Listado de las 5 mejores novillas genómicas españolas de menos de 18 meses por Días Abiertos tras la evaluación de Julio 2015.

sión las de Mas Gener promedian 3700 puntos ICO frente a los 3620 de las de Can Thos. Con más de 10 se mantienen San Rian Sdad. Coop. Galega, Landeira Sdad. Coop. Galega y Mas La Cavalleria.
Las ganaderías que se incorporan al listado son Cunordam S.C. con cinco terneras que promedian 3618 puntos de ICO y S.A.T. Etxalde con cuatro terneras con una media de 3538.
Tabla 10. Listado de ganaderías con 4 o más terneras entre las 200 mejores tras la evaluación de Julio de 2015.

Desde Junio de 2015 se puede obtener una gran cantidad de información adicional junto a las evaluaciones genómicas de las terneras. Una duda inmediata que surge es cómo se debe trabajar con la información obtenida.
Respecto a las enfermedades recesivas, hasta la fecha el elevado coste de la analítica hacía inviable el chequeo rutinario de las hembras y

dades en nuestra granja y por tanto evitar los costes y problemas que acarrean.
Gracias a los avances en el estudio del genoma del vacuno vamos descubriendo cada día en distintas regiones del genoma, efectos adversos cuando se encuentran un espermatozoide y un óvulo portadores de la misma variante problemática. Lo que tradicionalmente se había tratado de evitar mediante el control de la consanguinidad a nivel genealógico, ahora podemos hacerlo directamente evitando que las variantes que provocan problemas se acumulen en un individuo.
La forma más eficaz de trabajar con estos caracteres es conocer el estatus del animal e incorporarlo al programa de acoplamientos que se use habitualmente, de esta forma evitaremos de forma ágil y sencilla los problemas en forma de abortos o crías con malformaciones que suelen ser el resultado visible.
Desde luego no es recomendable dejar de usar toros por ser portadores, cada día se descubren nuevas regiones problemáticas. Como decíamos antes, esto no es más que entrar en el detalle de lo que siempre se conoció como problemas relacionados con la consanguinidad. Toros como Storm, Shottle, Snowman, o Bolton son portadores de algunos de estos genes, pero no hay duda de que la mejora genética que han aportado a la raza supera con creces el riesgo. Además si en lugar de estos toros se hubiesen utilizado otros inferiores esto no habría evitado que este tipo de problemas apareciesen y el progreso de la raza habría sido menor.

En esta sección tratamos de dar respuesta a las preguntas que van surgiendo en relación con la selección genómica. Os animamos a enviar vuestras preguntas a: conafe@conafe.com referencia “Consultorio Genómico”




Para la elaboración del Catálogo Internacional de Sementales agosto 2015 se han utilizado las pruebas oficiales de CONAFE disponibles a junio’15 y las pruebas MACE de agosto’15 de producción, tipo, recuento de células somáticas, longevidad funcional y días abiertos, que son oficiales en España para los toros sin prueba en nuestro país para estos caracteres.
Desde la última evaluación se incorporan también a los listados aquellos toros genómicos que tengan una prueba oficial en las evaluaciones genómicas mensuales que transcurren desde la última evaluación semestral nacional hasta la fecha de la publicación de las pruebas MACE.
Las pruebas MACE son calculadas y distribuidas por INTERBULL para estimar cómo pueden compararse los toros de otros países sin prueba española con los toros que sí tienen prueba en España. Para calcular las evaluaciones internacionales, INTERBULL recibe las valoraciones de los toros en cada país y, mediante el método MACE, obtiene las pruebas de todos los toros en las escalas de cada uno de los países participantes.
Las listas de mejores toros se establecen según el ICO –el índice de mérito genético global oficial

en CONAFE– y según requisitos de fiabilidad.
En la columna de Tipo de Prueba, se indica con una “M” cuando es una prueba MACE, "I" = sólo indirecta y "F" = prueba faltante.
En longevidad, las pruebas de los toros sin prueba nacional se calculan combinando las pruebas MACE de longevidad y las pruebas MACE de miembros y aplomos, profundidad de ubre y RCS.


A continuación aparecen los primeros 400 toros mejoradores por ICO del listado internacional de sementales. Para elaborar este listado se han exigido los siguientes requisitos:
1. Estar dentro del percentil 90 por ICO en la última evaluación nacional realizada por CONAFE, es decir, su ICO es igual o superior al del mejor 10% de los toros probados en España.
2. Fiabilidad igual o superior al 80% en producción y tipo.
3. En tipo, el requisito de la fiabilidad se aplica sobre la fiabilidad máxima en alguno de los países participantes en las evaluaciones MACE. El resto de toros del catálogo internacional se puede consultar en la página web de CONAFE www.conafe.com.
Toros MEJORADORES ordenados por ICO. Pruebas CONAFE junio 2015 + MACE agosto 2015 Orden POM Nombre Año Nacimiento PRODUCCIÓN TIPO RCS LONGEV. D. A. ICO V.



A continuación se publica el segundo listado del catálogo internacional de sementales que recoge la relación de toros con baja fiabilidad dentro del percentil 99 por ICO y que cumplen los siguientes requisitos:
1. Estar dentro del percentil 99 de la última evaluación nacional realizada por CONAFE, es decir, su ICO es igual o superior al del mejor 1% de los toros probados en España.
2. Fiabilidad inferior al 80% en producción o tipo.
3. En tipo, el requisito de la fiabilidad se aplica sobre la fiabilidad máxima en alguno de los países participantes en las evaluaciones MACE.


La relación completa se puede consultar en www.conafe.com.
Toros con BAJA FIABILIDAD ordenados por ICO. Pruebas CONAFE junio 2015 + MACE agosto 2015 Orden POM
Nombre Año Nacimiento PRODUCCIÓN TIPO RCS LONGEV. D. A. ICO V.
Tipo Prueba Fiabilidad Hijas Kg. Leche Kg. Grasa % Proteína Kg. Proteína Tipo Prueba Fiabilidad Hijas IPP ICU Fiabilidad R. Células Somáticas Tipo Prueba Fiabilidad Longevidad Tipo Prueba Fiabilidad Días Abiertos Valor
• NO SOLO SABRÁ QUE SU VACA ESTÁ EN CELO, SINO QUE EL SISTEMA LE INDICARÁ EL MOMENTO ÓPTIMO DE INSEMINACIÓN.
• MEJORARÁ LOS RATIOS DE PREÑEZ Y POR CONSIGUIENTE EL INTERVALO ENTRE PARTOS.
• MÁS DE 1.000 GANADEROS YA LO UTILIZAN EN HOLANDA.
• EFICACIA PROBADA CON UN 90% DE FIABILIDAD.
• SENCILLA INSTALACIÓN, CON RESULTADOS A CORTO PLAZO.


A continuación aparecen –ordenados alfabéticamente por su nombre corto–los nuevos toros puestos en reparto facilitados por los centros de Inseminación Artificial españoles propietarios de los mismos.
La información de cada animal es la registrada en el Libro Genealógico de CONAFE.
En la primera línea aparecen el nombre completo del toro y los caracteres recesivos; la fecha de nacimiento; el código de IA y el número genealógico.
En la segunda y tercera línea, se muestran los índices genéticos correspondientes a las últimas
















1ª: Vaca A



2ª: Vaca C



3ª: Vaca B



4ª: Vaca D



Observaciones previas:
Fantástica sección de vacas Intermedias con dos ubres superiores en las primeras plazas de la categoría.


Explicación oficial:
Introducción:
Una ganadora fácil, con la mejor ubre y estructura lechera de la sección.
1ª sobre 2ª: Por una mejor inserción anterior de la ubre así como por ser más larga en general, sobre todo en su tercio anterior, y por presentar mayor profundidad y arqueamiento en su costillar.
2ª sobre 3ª: Dos posiciones cercanas, pero hoy damos ventaja a las inserciones de ubre, tanto anterior como posterior, de nuestra segunda vaca sobre la bonita vaca, de buena estructura lechera, colocada tercera.
3ª sobre 4ª: Por una mejor profundidad e inserción anterior de la ubre así como por tener un tercio anterior más fino y descarnado y mejor calidad de hueso.

Ganador entre los acertantes con pleno: David Bagaria Pont, ganadero. Prullans (Lleida)

Resto de acertantes:
Alberto Rios Crespo,estudiante. Silleda (Pontevedra)







EXPLICACIÓN DE LA COLOCACIÓN:






Es imprescindible razonar el orden elegido, hablando del conjunto de la sección, mencionando dos o tres características de cada posición y haciendo un comentario final (Consultar “Manual de juzgamiento” de Conafe). Solo se admitirá una respuesta por participante
Introducción:
1ª sobre 2ª:
2ª sobre 3ª: .......................................................................................................
3ª sobre 4ª:
Conclusiones:
Orden Vaca 1ª 2ª


Premio: Forro polar de CONAFE
Datos del concursante:
Nombre y apellidos:
Profesión:
Dirección: .......................................................................
Código postal, localidad y provincia:
Teléfono:
A continuación aparece la relación de animales (nombre y propietario) calificados durante los meses de MAYO y JUNIO de 2015, que han obtenido las categorías de EX o MB.
En la web de Conafe www.conafe.com aparece esta misma relación junto con el número genealógico y el padre de cada
Técnicos Calificadores
Gabriel Blanco del Campo (Jefe del Dpto. de Morfología)
Juan Manuel Fernández Ahedo (Coordinador de Calificadores)

Marcial Avelló Santiago Santiago Mato Montouto Domingo Ces Ares Julián Montero García
Alejandro Glez. del Valle Mier Pedro Javier Peréz Pérez
Luis Mario López Vázquez Rafael Vierna Pita
animal. También en esta web, a través de SinbadFree, se puede ampliar la información sobre genealogías, índices y producciones de estos animales.
MACHOS EXCELENTES
HERBARFER SPIRTE CHULO/HERBARFER - VIZCAYA
MACHOS MB - 88 PUNTOS
GUSTAVO JORDAN PALMACIN/IGLESIAS-FERRADAS, S.C. - PONTEVEDRA
MACHOS MB - 87 PUNTOS
ESTEBANO SC SID RONALDO/VILLAMEITIDE, S.L. - LUGO
SOMOBOO TRUENO SID/SOMOBOO - CANTABRIA
URKITZE SID MANOLETE/RUCABAO - VIZCAYA
MACHOS MB - 86 PUNTOS
BALDOMERO TANGO ACME/GANADERIA TRIQUEL, S.C. - ASTURIAS
HOYOS MARCELO ARTES/FERNANDO BARQUIN CRESPO - CANTABRIA
TORO ALEX/URBASA S.A.T. - ASTURIAS
MACHOS MB - 85 PUNTOS
CASTRO BLANCO DUDE ET/CASA CASTRO, S.C. - A CORUÑA
EL VALLE STORMATIC PANCHO/EL MOLINO - CANTABRIA
LUCHO MARXUAN GALAN ET/GANADERIA MOLINEIRO, S.C. - ASTURIAS
NODI EXPLODE NERON FIV ET/GANADERIA ASTURAO, S.C. - LUGO

HEMBRAS 2 VECES EXCELENTES
AORMI DANIELA BUCKEYE/AORMI - CANTABRIA
BADIOLA DUPLEX LENA/GAN. DIPLO. BADIOLA - ASTURIAS
BADIOLA SHOTTLE KATY/GAN. DIPLO. BADIOLA - ASTURIAS
BADIOLA TALENT MEGATILA/GAN. DIPLO. BADIOLA - ASTURIAS
COTO DAMION DANIELA/CASA COTO - ASTURIAS
FELE TOYSTORY JANA/GANADERIA FELE, S.C. - ASTURIAS
HERBARFER DUPLEX RIANA/HERBARFER - VIZCAYA
LOS TEJOS DUPLEX IRINA/LOS TEJOS, C.B. - VIZCAYA
MOLINO RUEDAS LAMBRETA LOU/EL MOLINO DE RUEDAS - CANTABRIA
PEDREGAL SHOTTLE VANY/GANADERIA ELOY, S.C. - ASTURIAS
HEMBRAS EXCELENTES
ARRUÑADA HEIDY CUT/URBASA S.A.T. - ASTURIAS
BADIOLA AFTERSHOCK DARONA/GAN. DIPLO. BADIOLA - ASTURIAS
BADIOLA ASHGOLD MIMI/GAN. DIPLO. BADIOLA - ASTURIAS
BADIOLA ATWOOD LUTY/GAN. DIPLO. BADIOLA - ASTURIAS
BADIOLA DAMION CHANELA/GAN. DIPLO. BADIOLA - ASTURIAS
BADIOLA DAMION KOKETA/GAN. DIPLO. BADIOLA - ASTURIAS
BADIOLA DUPLEX SHARAPOVA/GAN. DIPLO. BADIOLA - ASTURIAS
BADIOLA MR SAM JAMINA/GAN. DIPLO. BADIOLA - ASTURIAS
BADIOLA SANCHEZ BERSKA/GAN. DIPLO. BADIOLA - ASTURIAS
 3 EX
3 EX
BEA DUPLEX/LA PITERA - CANTABRIA
BLANCO BOND VILACOBA III ET/BLANCO - PONTEVEDRA
BLANCO.H DUPLEX SONIA 315/BLANCO - PONTEVEDRA
BOS CID SHOTTLE LANA ET/GANDEIRIA CID, S.C. - LUGO
CASIMIRA LHEROS YOSUNE/GANADERIA CASIMIRA - ASTURIAS
CATALINA FBI/S.A.T. CRESPO LAVIN-BARCEÑA - CANTABRIA
CID GOLDWYN MATIGUEIRA ET/GANDEIRIA CID, S.C. - LUGO
COBERTORIA RUEDA SHAKER/URBASA S.A.T. - ASTURIAS
COTO ROY ELDA/LUCHO, S.C. - ASTURIAS
CRUZ LEZAMA DESIRE TOYSTORY/S.A.T. CRUZ LEZAMA - CANTABRIA
CRUZ LEZAMA LARA BAXTER/S.A.T. CRUZ LEZAMA - CANTABRIA
DOROÑA XACOBEO CHOLA 0242/S.A.T. DOROÑA 1094 - A CORUÑA
EL CRUCE BOLTON GABRIELA/S.A.T. EL CRUCE - CANTABRIA
EL CRUCE SHOTTLE PANDORA/S.A.T. EL CRUCE - CANTABRIA
EL CRUCE SHOTTLE PINELA/S.A.T. EL CRUCE - CANTABRIA
ELOY XACOBEO NONA/GANADERIA ELOY, S.C. - ASTURIAS
FISURE.CB TALENT PERDIDA/FISURE PORTILLO, C.B. - VIZCAYA
FLORA DUPLEX ABIGAIL/CASA FLORA. SDAD.CIVIL - ASTURIAS
FLORA DUPLEX LARISSA/CASA FLORA. SDAD.CIVIL - ASTURIAS
HNOS UZQU SPIRTE UZKIANO 1/ZALDUBITXI S.C. PEQUEÑA - ALAVA
LA FLOR GOMEZ SADY/GANADERIA LA FLOR, S.C. - ASTURIAS
LA HUERTA SALOME ROY/LA HUERTA - CANTABRIA
LLUISA GAVOR PEPI/S.A.T. LLUISA - ASTURIAS
LLUISA XACOBEO PEPINA/S.A.T. LLUISA - ASTURIAS
LLUISA XACOBEO VILLA/S.A.T. LLUISA - ASTURIAS
LOUREIROS BALA DUPLEX/RIAL DE LOUREIROS - A CORUÑA
MANTOÑO BAXTER RIANA/MANTOÑO HOLSTEIN - LUGO
MANTOÑO SPIRTE GAILA/MANTOÑO HOLSTEIN - LUGO
MARJAL VELLA ROMEO ROMA/SARABIA - CANTABRIA
MINGON DENZEL LINDA/GANADERIA MINGON, S.COOP. - ASTURIAS
MURRIETA DAMION LEONA/MURRIETA - VIZCAYA
NORINO DUPLEX JANA/GANADERIA ALBAUR,S.C. - ASTURIAS
ONDARTZA SANCHEZ 4657/ONDARTZA BITARTE SC - GUIPUZCOA
OUTEIRO SHOTTLE BETA/OUTEIRO,S.C. - LUGO
PATALLO ALINO AFRICA/TOÑO PATALLO - ASTURIAS
POLO XACOBEO XACOBEA/CASA DE POLO, S.C. - LUGO
PORCILO ATHENA GOLDWYN/GANADERIA SAN MARTIN - ASTURIAS
PORCILO ELISA GOLDWYN/GANADERIA PORCILO, S.C. - ASTURIAS
PUENTE KINGLY JAGUA/GANADERIA PUENTE, S.C. - ASTURIAS
S.M. OLIMPIA FINEST/GANADERIA PARLERO, S.C. - ASTURIAS
SOMOBOO SAKYRA GOLDWYN/SOMOBOO - CANTABRIA
TEC COTO SHOTTLE MAZDA ET/CASA COTO - ASTURIAS
TONJOVI INDIRA ROMEO/TONJOVI - ASTURIAS
TORRE BUFALO PACA/GANADERIA LA TORRE - CANTABRIA
VENTURA RESTELL SORAYA/GANADERIA VENTURA, S.C. - ASTURIAS
VIÑA GOLDWYN LUPE/CASA VIÑA, S.C. - ASTURIAS
VIÑA SHOTTLE BLANQUINA/CASA VIÑA, S.C. - ASTURIAS
HEMBRAS MB DE 1º PARTO - 88 PUNTOS
ARTIME ATWOOD HARMONIE/AGROARTIME, S.C. - ASTURIAS
BADIOLA ACME MANOLY/GAN. DIPLO. BADIOLA - ASTURIAS
BADIOLA ATWOOD MAGY/GAN. DIPLO. BADIOLA - ASTURIAS
BADIOLA DEMPSEY MILITA/GAN. DIPLO. BADIOLA - ASTURIAS
BADIOLA GOLDWYN ANNA/GAN. DIPLO. BADIOLA - ASTURIAS
BADIOLA LAUTHORITY BARBARA/GAN. DIPLO. BADIOLA - ASTURIAS
BADIOLA STANLEYCUP MELISA/GAN. DIPLO. BADIOLA - ASTURIAS
BADIOLA WINDBROOK SILVINA/GAN. DIPLO. BADIOLA - ASTURIAS
COTO SID RADIANNCE/CASA COTO - ASTURIAS
FACIO SID BARBY/GANAD. FACIO HOLSTEIN - ASTURIAS
MANTOÑO GOLD CHIP DURIA/MANTOÑO HOLSTEIN - LUGO
UZQUIANO- WINDBROOK UZKIANO 3/ZALDUBITXI S.C. PEQUEÑA - ALAVA
HEMBRAS MB DE 1º PARTO - 87 PUNTOS
BADIOLA ACME LORENA/GAN. DIPLO. BADIOLA - ASTURIAS
BADIOLA BRADNICK MARTINA/GAN. DIPLO. BADIOLA - ASTURIAS
BADIOLA BRADNICK MEGATUNA/GAN. DIPLO. BADIOLA - ASTURIAS
BADIOLA BRAXTON MEGACRISTY/GAN. DIPLO. BADIOLA - ASTURIAS
BADIOLA DEMPSEY JUDEA/GAN. DIPLO. BADIOLA - ASTURIAS
BADIOLA DUSK LASY/GAN. DIPLO. BADIOLA - ASTURIAS
BADIOLA HEFTY MASAKO/GAN. DIPLO. BADIOLA - ASTURIAS
BADIOLA SID SINGAPUR/GAN. DIPLO. BADIOLA - ASTURIAS
BADIOLA WINDHAMMER MAFALDA/GAN. DIPLO. BADIOLA - ASTURIAS
BADIOLA YORICK FIFA/GAN. DIPLO. BADIOLA - ASTURIAS
BADIOLA YORICK PATAKY/GAN. DIPLO. BADIOLA - ASTURIAS
BALDOMERO TAIR BRADNICK ET/GANAD. BALDOMERO - ASTURIAS
BENERATEJOS DIOR GOLDWYN ET/GANADERIA BENERA - CANTABRIA
BLANCO VERONE INSU ET/BLANCO - PONTEVEDRA
BOS CID ATWOOD MONI ET/GANDEIRIA CID, S.C. - LUGO
BOUDOIS BALADA GOLD. SS BLANCO/BLANCO - PONTEVEDRA
CASA-NOVA CHARISSE LEOPARD 918/GANAD. CARRO - A CORUÑA
ELOY BRADNICK ESTOPA/GANADERIA ELOY, S.C. - ASTURIAS
ELOY SID PALMA/GANADERIA ELOY, S.C. - ASTURIAS
LLARRIBA BRAXTON RUMBA III/LLARRIBA, S.C. - ASTURIAS
LLUISA ATWOOD LADY/S.A.T. LLUISA - ASTURIAS
LOS.TEJOS PLANET NICKINET/LOS TEJOS, C.B. - VIZCAYA
MANTOÑO DAMION BLACKROSE ET/MANTOÑO HOLSTEIN - LUGO

MANTOÑO GOLD CHIP DIVIANA/MANTOÑO HOLSTEIN - LUGO
MANTOÑO LAUTHORITY GALEONA/MANTOÑO HOLSTEIN - LUGO
MANTOÑO SID RENICE ET/MANTOÑO HOLSTEIN - LUGO
MANTOÑO WINDBROOK AUDRA ET/MANTOÑO HOLSTEIN - LUGO
PEREJIL BOBALICONA ET/GRANJA PEREJIL "EL MACHO" - CANTABRIA
PORCILO LILI RAE ATWOOD/GANADERIA PORCILO, S.C. - ASTURIAS
TEZANILLOS DEMSEY GANADORA/S.A.T. TEZANILLOS - CANTABRIA
VENTURO FEVER ROSITA/CASA VENTURO - ASTURIAS
VIÑES YORICK CHANEL/LA PIENDA, S.C. - ASTURIAS
HEMBRAS MB DE 1º PARTO - 86 PUNTOS
AGR YORICK TOLE/AGROARTIME, S.C. - ASTURIAS
ARENAS NOA METEOR/S.A.T. ARENAS Nº 39119 - CANTABRIA
ARGOMOTA ATWOOD STELA/LA ARGOMOTA - ASTURIAS
ARRABAL ARENA/ARRABAL, S.C. - CANTABRIA
BADIOLA ATWOOD SUSY/GAN. DIPLO. BADIOLA - ASTURIAS
BADIOLA BRADNICK DESIDERIA/GAN. DIPLO. BADIOLA - ASTURIAS
BADIOLA BRADNICK MEGALBA/GAN. DIPLO. BADIOLA - ASTURIAS
BADIOLA BRADNICK ROSA/GAN. DIPLO. BADIOLA - ASTURIAS
BADIOLA BRAXTON LETONIA/GAN. DIPLO. BADIOLA - ASTURIAS
BADIOLA DEMPSEY LIA/GAN. DIPLO. BADIOLA - ASTURIAS
BADIOLA DUSK DONGA/GAN. DIPLO. BADIOLA - ASTURIAS
BADIOLA DUSK PITUSA/GAN. DIPLO. BADIOLA - ASTURIAS
BADIOLA EXTREME LINDA/GAN. DIPLO. BADIOLA - ASTURIAS
BADIOLA GOLD CHIP MENCIA/GAN. DIPLO. BADIOLA - ASTURIAS
BADIOLA GOLD CHIP NATY/GAN. DIPLO. BADIOLA - ASTURIAS
BADIOLA LAUTHORITY TUNIA/GAN. DIPLO. BADIOLA - ASTURIAS
BADIOLA MORGAN BAMBOLA/GAN. DIPLO. BADIOLA - ASTURIAS
BADIOLA SID RUSA/GAN. DIPLO. BADIOLA - ASTURIAS
BADIOLA STANLEYCUP MAGATADEA/GAN. DIPLO. BADIOLA - ASTURIAS
BADIOLA STANLEYCUP MASCARA/GAN. DIPLO. BADIOLA - ASTURIAS
BADIOLA STANLEYCUP SANTERA/GAN. DIPLO. BADIOLA - ASTURIAS
BADIOLA YORICK MARTA/GAN. DIPLO. BADIOLA - ASTURIAS
BADIOLA YORICK TERESA/GAN. DIPLO. BADIOLA - ASTURIAS
BALDOMERO CARAMELA SID/GANAD. BALDOMERO - ASTURIAS
BENERAPEREDA IRENE GOLD CHIP/GANADERIA BENERA - CANTABRIA
BLANCO DELIÑA ET/BLANCO - PONTEVEDRA
BLANCO DELIA DALILA ET/BLANCO - PONTEVEDRA
BLANCO EMILY/BLANCO - PONTEVEDRA
BLANCO GALLETERA GOLADA ET/BLANCO - PONTEVEDRA
BLANCO SIDRA/BLANCO - PONTEVEDRA
BOS CAMPA SUDAN LEONA ET/S.A.T. A CAMPA - A CORUÑA
BRUNI 3061/GANADERIA LAS LLAMAS, S.C. - ASTURIAS
CAMPA ATWOOD 0944/S.A.T. FINCA EL PILAR 868 XUGA - A CORUÑA
CARBALLEIRAS DUDE SHARON/S.A.T. CARBALLEIRAS - PONTEVEDRA
CASA-NOVA LORIN ATWOOD 912/GANAD. CARRO - A CORUÑA
COTO WINDBROOK BRANDY/CASA COTO - ASTURIAS
EDESA ANDY GOLD CHIP/GRANJA LA FUENTE, S.C. - CANTABRIA
EDESA TEDY ATWOOD/GRANJA LA FUENTE, S.C. - CANTABRIA
EL CRUCE SID TITA/S.A.T. EL CRUCE - CANTABRIA
F.M. 6906 JORDAN 6240/S.A.T. FAMILIA MARTINEZ - A CORUÑA
FARIÑEIRO DANCER CUCHI/FARIÑEIRO S.A.T. Nº 1049 XUGA - LUGO
GAYERE CUP GOLDWYN SID/SAMASILVA - ASTURIAS
GRANDE KOALA STANLEYCUP KARINO/S.A.T. GRANDE - LUGO
GUSTAVO WINDBROOK BRANDY/IGLESIAS-FERRADAS - PONTEVEDRA
H.TOBIAS FEVER CHOMBERA/CASA FLORA. SDAD.CIVIL - ASTURIAS
HACHE/GANAD. CARRO - A CORUÑA
HERBARFER LAVANGUAR LAVA/HERBARFER - VIZCAYA
HOTTE 831/ABELEDO, S.C. - A CORUÑA
LA CALEONA WONDER MONTANA/LLARRIBA, S.C. - ASTURIAS
LA FLOR TEE OFF EDERRA/LA FLOR - CANTABRIA
LANDETXE SONY/LANDETXE S.C. - ALAVA
LARREA S. BRAXTON ESTOMA/LARREA S.C. - ALAVA
LLARRIBA BRAXTON MISS MARINA/LLARRIBA, S.C. - ASTURIAS
LLUISA ATWOOD CALA/S.A.T. LLUISA - ASTURIAS
LLUISA ATWOOD LUISA/S.A.T. LLUISA - ASTURIAS
LLUISA ATWOOD TAYLOR/S.A.T. LLUISA - ASTURIAS
LLUISA BRAXTON BRASIL/S.A.T. LLUISA - ASTURIAS
LLUISA WINDHAMMER TEXAS/S.A.T. LLUISA - ASTURIAS
LORENZO FEVER FIONA/CASA LORENZO,S.C. - ASTURIAS
LOS.TEJOS SHOTTLE BABI/LOS TEJOS, C.B. - VIZCAYA
LOS.TEJOS SHOTTLE SHOL/LOS TEJOS, C.B. - VIZCAYA
LUCARIA SID CUBANA/CASA LUCARIA - ASTURIAS
LUCARIA YORICK LOVESTAR/CASA LUCARIA - ASTURIAS
LUCHO BRADNICK MARQUESA/LUCHO, S.C. - ASTURIAS
MANOLERO WINDBROOK CHANEL/GANADERIA MANOLERO - ASTURIAS
MANTOÑO ATWOOD FRIDA/MANTOÑO HOLSTEIN - LUGO
MANTOÑO ATWOOD MELANCOLIA/MANTOÑO HOLSTEIN - LUGO
MANTOÑO BRAXTON DALIA/MANTOÑO HOLSTEIN - LUGO
MANTOÑO BRAXTON DUNBRA ET/MANTOÑO HOLSTEIN - LUGO
MANTOÑO BRAXTON FROXTY/MANTOÑO HOLSTEIN - LUGO
MANTOÑO DAMION GYSELA/MANTOÑO HOLSTEIN - LUGO
MANTOÑO DAMION LEXI ET/MANTOÑO HOLSTEIN - LUGO
MANTOÑO LAUTHORITY DIENA ET/MANTOÑO HOLSTEIN - LUGO
MEYRAZO SID PRIXEIDA/CASA EL MEYRAZO - ASTURIAS
MINGON LONGITUDE CORE/GANADERIA MINGON, S.COOP. - ASTURIAS
76 Frisona Española 208 j/a (pasa pág. 78)
MONASTEIRO SC XACOBEO RAQUEL/GANADERIA MONASTERIO - LUGO
MURRIETA ATWOOD ANKA/MURRIETA - VIZCAYA
ONDARTZA BRAXTON 5400/ONDARTZA BITARTE SC - GUIPUZCOA
ONDARTZA WINDBROOK 3243/ONDARTZA BITARTE SC - GUIPUZCOA
PEREJIL CLAMORES ET/GRANJA PEREJIL "EL MACHO" - CANTABRIA
PIENDA WINDBROOK MISSJOYA/LA PIENDA, S.C. - ASTURIAS
PORCILO NIKA JORDAN/GANADERIA PORCILO, S.C. - ASTURIAS
SABINO FEVER VIENA/SABINO - ASTURIAS
SARABIA JUDIT GOLDWYN/SARABIA - CANTABRIA
SERJA JUANITA IMO/S.A.T. SERJA Nº 39018 - CANTABRIA
SOMOBO DANDY WINDBROOK/SOMOBOO - CANTABRIA
SOMOBOO ORIGINAL FEVER/SOMOBOO - CANTABRIA
TEZANILLOS BRAXTON ACACIA/S.A.T. TEZANILLOS - CANTABRIA
VH PILAR 6445/S.A.T. A CAMPA - A CORUÑA
VIÑA BOLIVIA LUCIA/CASA VIÑA, S.C. - ASTURIAS
VIÑA YORICK MAJICA/CASA VIÑA, S.C. - ASTURIAS
VILA 900 BRAXTON/S.A.T. GANADERIA VILA DE SANTAIA - A CORUÑA
1190 PLAZA ATWOOD TARTA/CASA LA PLAZA - ASTURIAS
6942 PLAZA DEMPSEY LENA/CASA LA PLAZA - ASTURIAS
HEMBRAS MB DE 1º PARTO - 85 PUNTOS
AGIRRESOR TALON 3195/AGIRRESOROAUNDI,S.C. - GUIPUZCOA
AGR DAMION TWIN ET/AGROARTIME, S.C. - ASTURIAS
AGR DEMPSEY PATRICIA/AGROARTIME, S.C. - ASTURIAS
AGR DESTRY FRUELA/AGROARTIME, S.C. - ASTURIAS
AGR JORDAN VIOLINA/AGROARTIME, S.C. - ASTURIAS
AGR LAUTHORITY CARLA/AGROARTIME, S.C. - ASTURIAS
ALAMBRERO STANLEYCUP DALIA/ALAMBRERO, S.C. - LUGO
AR.MOLINO FEVER ASONA/EL MOLINO, S.C. - VIZCAYA
AR.MOLINO SANCHEZ URKIOLA/EL MOLINO, S.C. - VIZCAYA
AR.MOLINO WINDBROOK ARIZNOA/EL MOLINO, S.C. - VIZCAYA
ARCE ARTES SUSE/S.A.T. ARCE III - CANTABRIA
ARENAS ADELE SHOTTLE ET/S.A.T. ARENAS Nº 39119 - CANTABRIA
ARENAS MONTANA GABOR/S.A.T. ARENAS Nº 39119 - CANTABRIA
ARGOMOTA SID HONEY/LA ARGOMOTA - ASTURIAS
ARGOMOTA STANLEYCUP HARMONY/LA ARGOMOTA - ASTURIAS
ARGOMOTA YORICK JENYFER/GANADERIA MANOLERO - ASTURIAS
ARRABAL VELETA WINDBROOK/ARRABAL, S.C. - CANTABRIA
ARRONTE BOMBA DURABLE/S.A.T. ARRONTE N.8434 - CANTABRIA
ARRONTE ERIKA PALERMO/S.A.T. ARRONTE N.8434 - CANTABRIA
ARTATXIA SEAVER ARTATXIA/ARTATXIA CECA - ALAVA
ARTIME ATWOOD GUINEA/AGROARTIME, S.C. - ASTURIAS
ARTIME FEVER DELIA/ARTIME, S.C. - ASTURIAS
ARTIME GOLDWYN FLORIDA/AGROARTIME, S.C. - ASTURIAS
ARTIME GOLDWYN ROMEA/AGROARTIME, S.C. - ASTURIAS
ARTIME SANCHEZ ANNA/AGROARTIME, S.C. - ASTURIAS
ARUSE CERVERIZ FRANCESCA/S.A.T. ARUSE - ASTURIAS
ARUSE COCKER GELANA/S.A.T. ARUSE - ASTURIAS
ARUSE DEMPSEY TATSUYA/S.A.T. ARUSE - ASTURIAS
BADIOLA ATWOOD KALIMERA/GAN. DIPLO. BADIOLA - ASTURIAS
BADIOLA DEBONAIR BARBARA/GAN. DIPLO. BADIOLA - ASTURIAS
BADIOLA GOLD CHIP LANA/GAN. DIPLO. BADIOLA - ASTURIAS
BADIOLA SID SIRIA/GAN. DIPLO. BADIOLA - ASTURIAS
BADIOLA STANLEYCUP MAGY/GAN. DIPLO. BADIOLA - ASTURIAS
BADIOLA STANLEYCUP MEGATANIA/GAN. DIPLO. BADIOLA - ASTURIAS
BADIOLA ZIPI KATIUSKA/GAN. DIPLO. BADIOLA - ASTURIAS
BALBINA CAMOUFLAGE DULCINEA/GANADERIA BALBINA - ASTURIAS
BALDOMERO CARITA SID ET/GANAD. BALDOMERO - ASTURIAS
BALDOMERO TAFFI BRADNICK ET/GANAD. BALDOMERO - ASTURIAS
BALDOMERO TEA GOLD CHIP/GANAD. BALDOMERO - ASTURIAS
BARCENIA ARRENDAJA FEVER/S.A.T. BARCENIA 8.109 - CANTABRIA
BARGAÑA ATWOOD BRUNI/LA BARGAÑA, S.C. - ASTURIAS
BARGAÑA SID IBIZA/LA BARGAÑA, S.C. - ASTURIAS
BENERA PEREDA BEA SHAMROCK ET/GANADERIA BENERA - CANTABRIA
BENERAPEREDA LANGORIA FEVER ET/GANADERIA BENERA - CANTABRIA
BENERAPEREDA LARISA GOLD CHIP/GANADERIA BENERA - CANTABRIA
BENERAPEREDA PATY FEVER/GANADERIA BENERA - CANTABRIA
BERNABE LONGITUDE CAROLA/GANADERIA BERNABE, S.C. - ASTURIAS
BLANCO CHIEF TARA TARY/BLANCO - PONTEVEDRA
BLANCO DEBY/BLANCO - PONTEVEDRA
BLANCO ELTON GRACE GRACIELA/BLANCO - PONTEVEDRA
BLANCO YUSENA/BLANCO - PONTEVEDRA
BOS CID FEVER CENTRAL ET/GANDEIRIA CID, S.C. - LUGO
BUSTO CHORI MARINA/GARCIA DEL BUSTO, S.C. - ASTURIAS
BUSTO JOHNSON SAMBA/GARCIA DEL BUSTO, S.C. - ASTURIAS
C.B.S.I. GABOR ARGIA/SAN ISIDRO - VIZCAYA
C.V. ANASTASIA RUSH/S.A.T. N 39001 CUATROVIENTOS - CANTABRIA
C.V. VICTORIA RUSH/S.A.T. N 39001 CUATROVIENTOS - CANTABRIA
CACHORRO DEMPSEY INES/GAN. CACHORRO - ASTURIAS
CACHORRO DEMPSEY MAGDALENA/GANAD. CACHORRO - ASTURIAS
CAMPA MOGUL REGINA F.I.V. ET/S.A.T. A CAMPA - A CORUÑA
CARB-AMER HILL SHERICE ET/OS AMERICANOS - PONTEVEDRA
CARBALLEIRAS CHAP KAY/S.A.T. CARBALLEIRAS - PONTEVEDRA
CARBALLEIRAS DELETE CATTY/S.A.T. CARBALLEIRAS - PONTEVEDRA
CARBALLEIRAS HILL MARTA/S.A.T. CARBALLEIRAS - PONTEVEDRA
CARBALLEIRAS SHAMROCK FELICE/S.A.T. CARBALLEIRAS - PONTEVEDRA

CARBAYEDA YORICK CECILIA/CARBAYEDA - ASTURIAS
CARBAYEDA YORICK DAMA/CARBAYEDA - ASTURIAS
CARDOSA ROLAND 3884/S.A.T. LOS LLARES N. 7530 - CANTABRIA
CARTEIRO 334 ALEXANDER/GANDEIRIA CARTEIRO, S.C. - A CORUÑA
CASA DE LOLA MECENA XACOBEO/CASA DE LOLA - A CORUÑA
CASA DO CAMPO 0906 BRAXTON/CASA DO CAMPO - A CORUÑA
CASA LUIS ALEXANDER ROSA/CASA LUIS - ASTURIAS
CASA-NOVA ARIADNA ATWOOD 932/GANAD. CARRO - A CORUÑA
CASA-NOVA CRISTINA JORDAN 914/GANAD. CARRO - A CORUÑA
CASA-NOVA ELEGANTE II ATWOO ET/GANAD. CARRO - A CORUÑA
CASA-NOVA NUCA IOTA 945/GANAD. CARRO - A CORUÑA
CASA-NOVA PANDORA WINDBROOK/GANAD. CARRO - A CORUÑA
CASA-NOVA VALENTINA 927/GANAD. CARRO - A CORUÑA
CASA-NOVA VALERIA ATWOOD 935/GANAD. CARRO - A CORUÑA
CASABLANCA METEOR SUSIE/S.A.T. CASABLANCA - CANTABRIA
CASABLANCA MONREAL VALVA/S.A.T. CASABLANCA - CANTABRIA
CASABLANCA MOREAL IVANIA/S.A.T. CASABLANCA - CANTABRIA
CATALINA BIZKIT/ALFREDO JOSE PEREZ FDEZ - ASTURIAS
CELEDONIO DEMPSEY CHABELA/CASA CELEDONIO - ASTURIAS
CELEDONIO WINDBROOK CHARLEN ET/CASA CELEDONIO - ASTURIAS
CELEDONIO WONDER REINA/CASA CELEDONIO - ASTURIAS
CHOUSA STEADY LAURA/GANADERIA A CHOUSA, S.L. - LUGO
CHRIS SELMA SECURE ROJA/CHRIS,S.C. - ASTURIAS
CHUISA LOFFICIEL ISLEÑA/RONDEROS Y GARCIA, S.C. - ASTURIAS
CIUCENDE DELETE/AGROCIOCENDE, S.C. - A CORUÑA
CIUCENDE DELETE 6740/AGROCIOCENDE, S.C. - A CORUÑA
CIUCENDE DELETE 6746/AGROCIOCENDE, S.C. - A CORUÑA
CIUCENDE WINDBROOK 6759/AGROCIOCENDE, S.C. - A CORUÑA
CLARA ARTES SHASA/CASA CLARA - ASTURIAS
COTILAN COCKER ADELA/CASA COTILAN - ASTURIAS
COTILAN XACOBEO PRISCILA/CASA COTILAN - ASTURIAS
COTO SID APHRODITHE/CASA COTO - ASTURIAS
CRUZ LEZAMA ABIGAIL JORDAN/S.A.T. CRUZ LEZAMA - CANTABRIA
CRUZ LEZAMA ELVIRA FAIR/S.A.T. CRUZ LEZAMA - CANTABRIA
CRUZ LEZAMA GLORIA CRISTIANO/S.A.T. CRUZ LEZAMA - CANTABRIA
DEL LLANO PERLA SID/EL LLANO, S.C. - CANTABRIA
DORVISOU GERARD CONNIE/DORVISOU - PONTEVEDRA
EIRELLO XIMENA DANCER/CASA EIRELLO - ASTURIAS
EL CALERO RONALDO MAKARENA/EL CALERO, S.C. - ASTURIAS
EL CRISTO CAMPANERA/CANASTRILLAS, S.C. - CANTABRIA
EL CRUCE BRAXTON CAMINO/S.A.T. EL CRUCE - CANTABRIA
EL CRUCE BRAXTON MOLDAVIA/S.A.T. EL CRUCE - CANTABRIA
EL CRUCE PLANET YOLANDA/S.A.T. EL CRUCE - CANTABRIA
EL CRUCE STORM CRACOVIA/S.A.T. EL CRUCE - CANTABRIA
EL MERACHO MAMEN TOM/SARABIA - CANTABRIA
EL REY MAHE LAUTHORITY/S.A.T. COGU-EL REY - CANTABRIA
EL REY ROGELIA SINDO/S.A.T. COGU-EL REY - CANTABRIA
EL SECO BONITA IOTA/EL SECO, S.C. - CANTABRIA
EL TOLEDANO ELSA II WINDBROOK/GAYERE C.B. - ASTURIAS
EL VALLE DEBUTANTE TINA ROJA/PRESMANES CAGIGAS - CANTABRIA
EL.CAMPO GOLD CHIP LOLA/EL CAMPO - VIZCAYA
EL.HAYA STANLEYCU LENA/EL HAYA MATIENZO, C.B. - VIZCAYA
ELOY AKUKU SENSEI/GANADERIA ELOY, S.C. - ASTURIAS
ELOY BRADNICK NURI/GANADERIA ELOY, S.C. - ASTURIAS
ELOY DELETE GRANDA/GANADERIA ELOY, S.C. - ASTURIAS
ELOY SHOTTLE VISA/GANADERIA ELOY, S.C. - ASTURIAS
ESPINEIRO LUCARIA PITBULL/CANO FERNANDEZ, S.C. - ASTURIAS
ESPINETE LORENA LAUTAMIC/S.A.T. PEREZ-OTI ZUÑEDA - CANTABRIA
ESTEBANO SC AMSTERDAM TALIA/ESTEBANO, S.C. - LUGO
ESTEBANO SC WILDMAN SUSANA/ESTEBANO, S.C. - LUGO
FACIO GOLD CHIP GÜENDOLINA/GANAD. FACIO HOLSTEIN - ASTURIAS
FACIO YORICK EVIDENCIA/GANAD. FACIO HOLSTEIN - ASTURIAS
FARRIN YORICK CHUECA/GANADERIA ISABEL - ASTURIAS
FERREIRO AMSTERDAM 7392/S.A.T. O FERREIRO 977 XUGA - A CORUÑA
FERREIRO GERARD 2573/S.A.T. O FERREIRO 977 XUGA - A CORUÑA
FERRERU WINDBROOK GILDA/LLARRIBA, S.C. - ASTURIAS
FISURE.CB DUPLEX DUBAI/FISURE PORTILLO, C.B. - VIZCAYA
FISURE.CB TEE OFF REYES/FISURE PORTILLO, C.B. - VIZCAYA
FISURE.CB WINDBROOK SURRA/FISURE PORTILLO, C.B. - VIZCAYA
FLORA DEMPSEY JESSIE/CASA FLORA. SDAD.CIVIL - ASTURIAS
FLORA FEVER MANDERLINE/CASA FLORA. SDAD.CIVIL - ASTURIAS
FLORA LAUTHORITY INIA/CASA FLORA. SDAD.CIVIL - ASTURIAS
FONTELAS XACOBEO 625/S.A.T. XUGA 747 FONTELAS - A CORUÑA
FRANA MELA AL/FRANA, S.C. - CANTABRIA
GAYERE BOLIVIA FEVER/GAYERE C.B. - ASTURIAS
GENER ELECTRICA MP HILL 1158/MAS GENER S.C.P. - GIRONA
GENER HIMALAYA ZENISTA 1165/MAS GENER S.C.P. - GIRONA
GOMEZAN FEVER 420 LINDA/CASA FERREIRO, S.C. - ASTURIAS
GRANDE ROSER ATWOOD ROSABELLA/S.A.T. GRANDE - LUGO
GRANDELO DELETE DUMBRIA/GANADERIA GRANDELO - LUGO
GRANDELO XACOBEO MARIA/GANADERIA GRANDELO - LUGO
HERBARFER FEVER VICKY/HERBARFER - VIZCAYA
HERBARFER VINCE VANESA/HERBARFER - VIZCAYA
HUERTO SAREYO FINA/GANADERIA PERICON - ASTURIAS
HUSSARDE 5100/ESTEBANO, S.C. - LUGO
ILMA WINDBROOK 144/S.A.T. 828 ILMA-XUGA - A CORUÑA
78
Frisona Española 208 j/a
ILMA XACOBEO 135/S.A.T. 828 ILMA-XUGA - A CORUÑA
ISLA BUTZE 87/LA ISLA, S.C. - CANTABRIA
ISLA GABOR 91/LA ISLA, S.C. - CANTABRIA
JADO LUNERA GOLDWYN/GRANJA JADO - CANTABRIA
JUANA DUPLEX PASTORA/CASA JUANA - ASTURIAS
JULIANA SID ORPHEE/CASA JULIANA - ASTURIAS
KATARAN S STEADY 516 STEAD/KATARAN, S.C. - ALAVA
L.SALCES LAUTHORIT LILIAN/LOS SALCES, C.B. - VIZCAYA
LA CORONA 25 SUPER/GANADERIA LA CORONA, SL - ASTURIAS
LA CORONA 4966 SID/GANADERIA LA CORONA, SL - ASTURIAS
LA FLOR GOLDWYN ISABEL/LA FLOR - CANTABRIA
LA FLOR STANLEYCUP ANGELICA/LA FLOR - CANTABRIA
LA MAZA LUNA SAILING/CANASTRILLAS, S.C. - CANTABRIA
LACTEOS B WINDBROOK 6503/LACTEOS BORDATXO,S.L. - GUIPUZCOA
LARREA S. FEVER ETEREA/LARREA S.C. - ALAVA
LAS QUINTAS SID MONIKA/LAS QUINTAS - ASTURIAS
LASTAOLA WYMAN BOND/LASTAOLA BASERRIA - GUIPUZCOA
LAUZTITUR DOR 4444/LAUZTITURRIETA ELKARTE - GUIPUZCOA
LEONOR GUNILA DURHAM ATLAS/AGROARTIME, S.C. - ASTURIAS
LIMONERA 51/CIFP LA GRANJA - CANTABRIA
LINA DELANO ANA/LINA - LUGO
LLAMAS DEMPSEY NADIA/GANADERIA LAS LLAMAS, S.C. - ASTURIAS
LLARRIBA YORICK TISIMA/LLARRIBA, S.C. - ASTURIAS
LLONGUERA MILLION CUESA/S.A.T. LA LLONGUERA - ASTURIAS
LLONGUERA MILLION ROMA/S.A.T. LA LLONGUERA - ASTURIAS
LLONGUERA OLIN CRIS/S.A.T. LA LLONGUERA - ASTURIAS
LLUISA ATWOOD AZABACHE/S.A.T. LLUISA - ASTURIAS
LLUISA GOLD CHIP AGUA/S.A.T. LLUISA - ASTURIAS
LLUISA GOLD CHIP GOLDEN/S.A.T. LLUISA - ASTURIAS
LLUISA GOLD CHIP RUMBA/S.A.T. LLUISA - ASTURIAS
LLUISA SANCHEZ SUITE/S.A.T. LLUISA - ASTURIAS
LLUISA SID ATALAYA/S.A.T. LLUISA - ASTURIAS
LLUISA YORICK NATACHA/S.A.T. LLUISA - ASTURIAS
LOS CURTOS EDIT/LOS CURTOS, S.C. - CANTABRIA
LOS.TEJOS DEMPSEY ELENIA/LOS TEJOS, C.B. - VIZCAYA
LOS.TEJOS POWER JAMALA/LOS TEJOS, C.B. - VIZCAYA
LOS.TEJOS SHAMROCK SHAM E.T./LOS TEJOS, C.B. - VIZCAYA
LOS.TEJOS SHOTTLE MIRA/LOS TEJOS, C.B. - VIZCAYA
LOS.TEJOS TIME ROLI/LOS TEJOS, C.B. - VIZCAYA
LOUREIROS JUANA DUPLEX/RIAL DE LOUREIROS - A CORUÑA
LUCARIA WINDHAMMER PEGY SUE/CASA LUCARIA - ASTURIAS
LUCARIA YORICK MARACAIBA/CASA LUCARIA - ASTURIAS
LUCHO ATWOOD ROXETA/LUCHO, S.C. - ASTURIAS
LUCHO HEFTY SIRIA/LUCHO, S.C. - ASTURIAS
LUCHO YORICK ZANUSI/LUCHO, S.C. - ASTURIAS
M.R. HILIUS DEMPSEY/EL MOLINO DE RUEDAS - CANTABRIA
MADANELO KAMPMAN 3678/GANADERIA MADANELO S.A.T. - LUGO
MANOLERO BRAXTON CAROLINA/GANADERIA MANOLERO - ASTURIAS
MANOLERO SID HOLLY/GANADERIA MANOLERO - ASTURIAS
MANOLIN CLAUDIA/CASA MANOLIN - ASTURIAS
MANTEIGA ARTES EVA ET/GANA. MANTEIGA - PONTEVEDRA
MANTEIGA LAUTAMIC DORA/GANA. MANTEIGA - PONTEVEDRA
MANTOÑO ALEXANDER GYSYT ET/MANTOÑO HOLSTEIN - LUGO
MANTOÑO BRAXTON VERONIK/MANTOÑO HOLSTEIN - LUGO
MANTOÑO DAMION LAURANA/MANTOÑO HOLSTEIN - LUGO
MANTOÑO LAUTHORITY MIRAX/MANTOÑO HOLSTEIN - LUGO
MARGARITA JORDAN VIOLETA/MARGARITA - ASTURIAS
MARIBEL JORDAN SOMBRA/MARIBEL - VIZCAYA
MARINA RUBENS CHANEL/LLARRIBA, S.C. - ASTURIAS
MENOR METEOR FANTA/S.A.T. CASA MENOR 1017 XUGA - A CORUÑA
MEYRAZO ALEXANDER PANDORA/CASA EL MEYRAZO - ASTURIAS
MIRANDA ALEXANDER INES/CASA COTO - ASTURIAS
MODESTO MONTROVE 6433/LA PARAYA, S.C. - CANTABRIA
MOLINO RUEDAS RAMBO SID/EL MOLINO DE RUEDAS - CANTABRIA
MONO COTO EPIC MANDY ET/CASA COTO - ASTURIAS
MONO REGUERA GOLDCHIP JENNY ET/CASA REGUERA - ASTURIAS
MURRIETA ATWOOD BLASY/MURRIETA - VIZCAYA
MURRIETA WINDBROOK LULU/MURRIETA - VIZCAYA
NAYO BRAXTON DOBRA/CASA LEONARDO,S.C. - ASTURIAS
NAYO SID ABIS/CASA LEONARDO,S.C. - ASTURIAS
NODI ARTES FINA/NODI, S.C. - LUGO
OBISPO ARTES MEGATE/GANADERIA EL OBISPO, S.C. - ASTURIAS
OCEJO BARBARA STANLEYCUP/SARABIA - CANTABRIA
ONDARTZA ARTES 4837/ONDARTZA BITARTE SC - GUIPUZCOA
ONDARTZA CHARIOT 3363/ONDARTZA BITARTE SC - GUIPUZCOA
ONDARTZA PLANET 3249/ONDARTZA BITARTE SC - GUIPUZCOA
ONDARTZA SID 4933/ONDARTZA BITARTE SC - GUIPUZCOA
ONDAZARTE DUDE URA/ONDAZARTE GAIN,S.L. - GUIPUZCOA
OTURIELLO YEMA YORICK/EL OTURIELLO, S.L. - ASTURIAS
OUTEIRO STANLEYCUP DORNA/OUTEIRO,S.C. - LUGO
PACHO ATWOOD TALVA/CASA DE PACHO - ASTURIAS
PACHO GOLD CHIP ENTIVA/CASA DE PACHO - ASTURIAS
PACHO MICKEY DAROKA/CASA DE PACHO - ASTURIAS
PACHO MICKEY ZALVA/CASA DE PACHO - ASTURIAS
PACHO SID SISTOLE/CASA DE PACHO - ASTURIAS
PACHON WINDBROOK TOLA/TAHOCES, S.C. - ASTURIAS
PARLERO SANCHEZ BRILLOSA/GANADERIA PARLERO, S.C. - ASTURIAS
PB NEW MAGREBI/PORTELO-BARBAS,S.C. - LUGO
PEDRAS-ALBAS ANXELO MALLA/CASA REI DE PEDRAS ALBAS - LUGO
PEDREGAL LATTERSHOT ANA/EL PEDREGAL, S.C. - ASTURIAS
PELAMBRE KEMER FEVER/EL PELAMBRE, S.C. - CANTABRIA
PEREJIL MARIACHI/GRANJA PEREJIL "EL MACHO" - CANTABRIA
PIENDA JERRICK EUPHORIA/LA PIENDA, S.C. - ASTURIAS
PIENDA YORICK JUANKA/LA PIENDA, S.C. - ASTURIAS
PONTEBOADO 9852 TOYOTA/JAVIER SUEIRO VAZQUEZ - A CORUÑA
PORCILO JUANA STANLEYCUP/GANADERIA PORCILO, S.C. - ASTURIAS
PORCILO LIVI RAE GOLDWYN ET/GANADERIA PORCILO, S.C. - ASTURIAS
PORCILO ZARA STANLEYCUP/GANADERIA PORCILO, S.C. - ASTURIAS
POSTIGO AZALEA FEVER/EL POSTIGO - CANTABRIA
POSTIGO LLUVIA RAIMUNDO/EL POSTIGO - CANTABRIA
POSTIGO TELVA RAIMUNDO/EL POSTIGO - CANTABRIA
POYU.SC SANCHEZ ETXARRI/POIU BASERRIA, S.C. - VIZCAYA
POZA WINDBROOK SELENA/LA POZA HOLSTEIN - CANTABRIA
QUINTANA BRENDA BLADE/QUINTANA, S.C. - CANTABRIA
QUINTANA LUCERA 700 FEVER/S.A.T. QUINTANA N. 7259 - CANTABRIA
REDONDA ISA LONGTIME/S.A.T. LA REDONDA - CANTABRIA
REGUERA ATWOOD TIFFANY/CASA REGUERA - ASTURIAS
REGUERA COCKER GLADYS/CASA REGUERA - ASTURIAS
RETO DAMADARLIN MINISTER/RETO A LA ESPERANZA - CANTABRIA
RETO DAVIVA SAILING/SDAD.COOP.RETO A LA ESPERANZA - CANTABRIA
ROSALINO FROILAN GRACIA/CASA ROSALINO - ASTURIAS
ROSALINO FROILAN KAREN/CASA ROSALINO - ASTURIAS
ROSALINO FROILAN LIBERTY/CASA ROSALINO - ASTURIAS
ROSALINO WILCOX BRANDY/CASA ROSALINO - ASTURIAS
ROSALINO WONDER SERINA/CASA ROSALINO - ASTURIAS
S.A. MINA/S.A.T. PEREZ-OTI ZUÑEDA - CANTABRIA
SAAMIL Nº1978 BRETT/SAAMIL - A CORUÑA
SAAMIL Nº6828 BRAXTON/SAAMIL - A CORUÑA
SABINO JORDAN QUELA/SABINO - ASTURIAS
SABINO SID GOYA/SABINO - ASTURIAS
SAGUALES AMERICANA SID/GANADERIA SAGUALES, S.C. - CANTABRIA
SANTAMARIA YEDRA EMILYSON/CASA MINGO, S.C. - ASTURIAS
SARABIA BELINDA FEVER/SARABIA - CANTABRIA
SARABIA ISABELA LAUTHORITY/SARABIA - CANTABRIA
SEOANE JERRICK PERDIZ 312/GANDEIRIA SEOANE,S C. - A CORUÑA
SERJA BONITA SHOTTLE/S.A.T. SERJA Nº 39018 - CANTABRIA
SERJA ESTRELLA SHOTTLE/S.A.T. SERJA Nº 39018 - CANTABRIA
SERJA VICENTA WINDBROOK/S.A.T. SERJA Nº 39018 - CANTABRIA
SERPA SEAVER HILARY/AMETSLEKU, C.B. - VIZCAYA
SHOT ROSARE/GRANJA MOLINO - CANTABRIA
SHOUT WALDA/LA FUENTONA - CANTABRIA
SIERRA ALONDRA PLANET/SIERRA DE CUETO REDONDO - CANTABRIA
SOLAPEÑA JUNGLE JUNCAL/SOLAPEÑA - VIZCAYA
SOMOBOO SUSA FEVER/SOMOBOO - CANTABRIA
SOTER DUQUESA/LA FUENTONA - CANTABRIA
SPEZI 1144 ET ROJA/S.A.T. A CAMPA - A CORUÑA
STA ANA ILENIA/GANADERIA SANTA ANA, S.C. - CANTABRIA
TEC MIÑO S. GOLDEN RED ROJA ET/CASA TIMOTEO, S.C. - ASTURIAS
TEZANILLOS GOLDWYN GUMA ET/S.A.T. TEZANILLOS - CANTABRIA
TEZANILLOS SID BOMBON/S.A.T. TEZANILLOS - CANTABRIA
TEZANILLOS SID REGALIZ/S.A.T. TEZANILLOS - CANTABRIA
TEZANILLOS SUDOKU REDONDA/S.A.T. TEZANILLOS - CANTABRIA
TOMAS SUELLEN SID/CAL TOMAS - GIRONA
TORRE BRAXTON CARLA/GANADERIA LA TORRE - CANTABRIA
TORRE LAZARENA/GANADERIA LA TORRE - CANTABRIA
TRESPANDIO YORICK GITANA/CASA LORENZO,S.C. - ASTURIAS
URBASA ATLANTIC LAURA/URBASA S.A.T. - ASTURIAS
URBASA ATWOOD JESTA/URBASA S.A.T. - ASTURIAS
URBASA FARSANO ALBA/URBASA S.A.T. - ASTURIAS
UZQUIANO- FEVER UZKIANO 3/ZALDUBITXI S.C. PEQUEÑA - ALAVA
UZQUIANO- SPECTRUM UZQUIANO/ZALDUBITXI S.C. PEQUEÑA - ALAVA
V. MURAL MARIA/GANADERIA VILLA - CANTABRIA
VALDES BAXTER CENICIENTA/CASA VALDES - ASTURIAS
VALNERA ARRECIFE SID/NURIA.H - VIZCAYA
VEGA LAUTHORITY ANGELES/CASA VEGA - ASTURIAS
VEIGUEIRO GABOR HUNGARA/VEIGUEIRO S. COOP. GALEGA - LUGO
VEIGUEIRO SPECTRUM MEGANE/VEIGUEIRO S. COOP. GALEGA - LUGO
VENTURA ATWOOD PARIS/GANADERIA VENTURA, S.C. - ASTURIAS
VENTURA DELETE PAMELA/GANADERIA VENTURA, S.C. - ASTURIAS
VENTURA HEFTY MOCOSA/GANADERIA VENTURA, S.C. - ASTURIAS
VENTURA YORICK TOÑA/GANADERIA VENTURA, S.C. - ASTURIAS
VENTURO FEVER BICHETTE/CASA VENTURO - ASTURIAS
VENTURO FEVER ROMANTICA/CASA VENTURO - ASTURIAS
VENTURO KITE VIOLETT/CASA VENTURO - ASTURIAS
VENTURO WINDBROOK MARGUISE ET/CASA VENTURO - ASTURIAS
VH PILAR 4343/S.A.T. A CAMPA - A CORUÑA
VIÑA ATWOOD ALBA/CASA VIÑA, S.C. - ASTURIAS
VIÑA ATWOOD NELY/CASA VIÑA, S.C. - ASTURIAS
VIÑA DEMPSEY NORI/CASA VIÑA, S.C. - ASTURIAS
VIÑA DUDE LESLY ET/CASA VIÑA, S.C. - ASTURIAS
VIÑA SID MALU/CASA VIÑA, S.C. - ASTURIAS
VIÑA YORICK MORA/CASA VIÑA, S.C. - ASTURIAS

VIÑES BRAXTON DASHA/GANADERIA VIÑES - ASTURIAS
VILA 896 DELETE/S.A.T. GANADERIA VILA DE SANTAIA - A CORUÑA
VILLAR BOLIVIA CHACA/CASA VILLAR, S.C. - ASTURIAS
VISTAHERMOSA ANDREW DANIELA/GANADERIA PARLERO - ASTURIAS
VIUDA BAXTER PARTISANA/ISABEL BOTO ALVAREZ - ASTURIAS
XACALEN DE SHAME MAURA/CASA BIGOTES, S.C. - ASTURIAS
XACALEN DE YORICK AMEBA/S.A.T. XACALEN Y GONZALEZ - ASTURIAS
XACALEN DE YORICK MIRIAN/EL ALBA, S.C. - ASTURIAS
XUANUCO LAUTHORITY ROSAURA ET/CASA PATRON, S.C. - ASTURIAS
ZALDUMEND ADMIRAL 9400/ZALDUMENDI, S.C. - GUIPUZCOA
ZALDUMEND WINDBROOK 9209/ZALDUMENDI, S.C. - GUIPUZCOA
ZAMINA TORTUGA 6448 WINDBROOK/S.A.T. LA ZAMINA - CANTABRIA
ZORRILLA JIRAFA DUPLEX/S.A.T. ZORRILLA - CANTABRIA
ZORRILLA WANIA WINDBROOK/S.A.T. ZORRILLA - CANTABRIA
03950074/LASTAOLA BASERRIA - GUIPUZCOA
04112182/LAUZTITURRIETA ELKARTE - GUIPUZCOA
04112190/LAUZTITURRIETA ELKARTE - GUIPUZCOA
04113471/LASTAOLA BASERRIA - GUIPUZCOA
3165/GRANJA DE MOJANTE, S.L. - CANTABRIA
9817 LOFFIECIEL/S.A.T. M.LAVIN-LOREDO - CANTABRIA
HEMBRAS MB DE 2º O MAS PARTOS - 89 PUNTOS
ALMONT BENITA 8974 DUPLEX/ALMONT, S.C. - CANTABRIA
BEHI-ALDE CHAMONIX 5541/COOPERATIVA BEHI-ALDE - ALAVA
BERMUI 8353/FINCA BERMUI, S.C. - A CORUÑA
BLANCO LEONA/BLANCO - PONTEVEDRA
BLANCOH. SHOTTLE COBA ET/BLANCO - PONTEVEDRA
CABANARES LANA SEPTEMBER/LOS CABANARES S.C. - ASTURIAS
CARBALLEIRAS BRUNO BRUNA/S.A.T. CARBALLEIRAS - PONTEVEDRA
COTO DAMION MADISON/CASA COTO - ASTURIAS
FINAGA MAGOT AMANDA/FINAGA - VIZCAYA
INSA/BLANCO - PONTEVEDRA
LA VISTA DANCER GUILLERMINA/LA VISTA - ASTURIAS
LLARRIBA ALLIANCE AMANDA/LLARRIBA, S.C. - ASTURIAS
LOS CURTOS MARISOL ROJA/LOS CURTOS, S.C. - CANTABRIA
LOUREIROS NOA SHOTTLE/RIAL DE LOUREIROS - A CORUÑA
MANTOÑO SEPTEMBER DONATELA/MANTOÑO HOLSTEIN - LUGO
MARCELO GEISHA GOMEZ/MARCELO SEBRAN,S.C. - ASTURIAS
RETO ROSALINDA MAUGHLIN STORM/RETO A LA ESPERANZA-CANTABRIA
SARABIA RUSIA SANCHEZ/SARABIA - CANTABRIA
HEMBRAS MB DE 2º O MAS PARTOS - 88 PUNTOS
ARENAS LUNA KINGLY/S.A.T. ARENAS Nº 39119 - CANTABRIA
ARMUCELA BOTAFOGO RUDOLPH/GANDEIRIA ARMUCELA - A CORUÑA
BADIOLA DAMION MAGIA/GAN. DIPLO. BADIOLA - ASTURIAS
BALDOMERO RAQUEL SID/GANAD. BALDOMERO - ASTURIAS
CABANARES DENA DRAC/LOS CABANARES S.C. - ASTURIAS
CALLOBRO MONTGOMERY ZELTIA G-Z/CALLOBRO HOLSTEIN - LUGO
CAMPO PICOLO MANDARINA ROJA/LA FLOR - CANTABRIA
CARBALLEIRAS BETANZOS PETA/S.A.T. CARBALLEIRAS - PONTEVEDRA
CARRAL XACOBEO MOLINERA/CARRAL - PONTEVEDRA
CID DUPLEX RACHELLE/GANDEIRIA CID, S.C. - LUGO
COTILAN GRAND CHARO/CASA COTILAN - ASTURIAS
COTO SANCHEZ KATHERINE/CASA COTO - ASTURIAS
COTO SID BEA/CASA COTO - ASTURIAS
EL CRUCE SUPERSTITION MUÑECA/S.A.T. EL CRUCE - CANTABRIA
EL.CUETO DUPLEX MARGARITA/EL MOLINO, S.C. - VIZCAYA
ESTAKUA DAMION JOSEPADAN/ESTAKUA - VIZCAYA
FACIO TOYSTORY LEONOR/GANAD. FACIO HOLSTEIN - ASTURIAS
FCO. JAVI MARCONI/HERMANOS ZUBI,S.C. - ALAVA
FERRERU HAMILTON MARQUESA/CASA EL FERRERU - ASTURIAS
FLORA JORDAN MANDY/CASA FLORA. SDAD.CIVIL - ASTURIAS
GAYERE COLINA MASON BARADAL/SAMASILVA - ASTURIAS
GAYERE GOLDWYN SANCHEZ/GAYERE C.B. - ASTURIAS
GAYERE M. MODES BUCKEYE/GAYERE C.B. - ASTURIAS
GAYERE TRINA CUP GOLDWYN 989/LLARRIBA, S.C. - ASTURIAS
GENER MARINA SHOTTLE 898/MAS GENER S.C.P. - GIRONA
GOLFITA/S.A.T. N 39001 CUATROVIENTOS - CANTABRIA
GRANDE KASANDRA SEPTEMBER KATH/S.A.T. GRANDE - LUGO
HERMANOS AIRRAID/HERMANOS ZUBI,S.C. - ALAVA
LA FLOR JORDAN REBECA/LA FLOR - CANTABRIA
LA FLOR OREGON NACATOMI/LA FLOR - CANTABRIA
LA SOLEDAD ROBBIN GISELA/LA SOLEDAD, S.C. - ASTURIAS
LA SOLEDAD SCOOBY-DUU CRISTINA/LA SOLEDAD, S.C. - ASTURIAS
LINA SANCHEZ ELSA/LINA - LUGO
LOS CURTOS DORA/LOS CURTOS, S.C. - CANTABRIA
LUCHO SHOTTLE ALTAMORA/LUCHO, S.C. - ASTURIAS
LUCIA MODEST/LA RIGADA - VIZCAYA
MANOLERO LAUTHORITY CANDELA/GANAD. MANOLERO - ASTURIAS
MANTEIGA ALEXANDER EVY/GANA. MANTEIGA - PONTEVEDRA
MANTEIGA DANCER RULA/GANA. MANTEIGA - PONTEVEDRA
MANTOÑO BOLIVIA LAUSINA/MANTOÑO HOLSTEIN - LUGO
MANTOÑO GOLDWYN BRUXIA ET/MANTOÑO HOLSTEIN - LUGO
MANTOÑO JORDAN GYORGIA ET/MANTOÑO HOLSTEIN - LUGO
MANTOÑO SHOTTLE DAIRA/MANTOÑO HOLSTEIN - LUGO
MOLINO RUEDAS MEGANE GOLDWYN/EL MOLINO DE RUEDAS-CANTABRIA
80 Frisona Española 208 j/a (pasa pág. 82)
MONASTEIRO ROY CABRA/SC GANADERIA MONASTERIO - LUGO
NOGAL CHAMPION CHANEL/GANADERIA NOGAL - ASTURIAS
NOGAL CHAMPION TRUFA/GANADERIA NOGAL - ASTURIAS
OBISPO ASPEN PASTORY/GANADERIA EL OBISPO, S.C. - ASTURIAS
OTURIELLO ARDILLA ERNESTO/EL OTURIELLO, S.L. - ASTURIAS
PACHO KAMPMAN TELVA/CASA DE PACHO - ASTURIAS
PACHO RISING PACHECA/CASA DE PACHO - ASTURIAS
PACHO TALENT LUBITA/CASA DE PACHO - ASTURIAS
POSTIGO MIMOSA ROY/EL POSTIGO - CANTABRIA
PUENTE BLADE TRUFA/GANADERIA PUENTE, S.C. - ASTURIAS
QUINTANA SAMBO 632/S.A.T. QUINTANA N. 7259 - CANTABRIA
QUINTANA SAMBO 633 BUCKEYE/S.A.T. QUINTANA N. 7259 - CANTABRIA
S.A.T. ET SUPERSTIT/S.A.T. ETXALDE - ALAVA
SAVAN DEBORA R. ROY/LLARRIBA, S.C. - ASTURIAS
STAR DOLMAN/LA RIGADA - VIZCAYA
TABOADA XAC. ZARZA/TABOADA DE CASALDOEIRO (CARREIRA D.)-A CORUÑA
TEZANILLOS SANCHEZ WRESTLEMAN/S.A.T. TEZANILLOS - CANTABRIA
TEZANILLOS SPIRTE SELENA/S.A.T. TEZANILLOS - CANTABRIA
5852 PLAZA ATWOOD LUSI/CASA LA PLAZA - ASTURIAS
HEMBRAS MB DE 2º O MAS PARTOS - 87 PUNTOS
ANCILES 8756/LA PIENDA, S.C. - ASTURIAS
AR.MOLINO BEACON AUNITZ/EL MOLINO, S.C. - VIZCAYA
AR.MOLINO SANCHEZ AIXA/EL MOLINO, S.C. - VIZCAYA
AR.MOLINO XACOBEO URKIA/EL MOLINO, S.C. - VIZCAYA
ARCE SHOTTLE GLADIA/S.A.T. ARCE III - CANTABRIA
ARGOMOTA SPIRTE HARMONIA/LA ARGOMOTA - ASTURIAS
ARRABAL NOKIA/ARRABAL, S.C. - CANTABRIA
ARTIME BARADAL HARMONIE/AGROARTIME, S.C. - ASTURIAS
ARTIME LUSTY TIBERIA/AGROARTIME, S.C. - ASTURIAS
ARTIME MILLION ENITA/AGROARTIME, S.C. - ASTURIAS
ARTIME SEAVER KORIE/AGROARTIME, S.C. - ASTURIAS
BADIOLA BAXTER THREAT VERA/GAN. DIPLO. BADIOLA - ASTURIAS
BALDOMERO CHENIA ROUMARE/GANAD. BALDOMERO - ASTURIAS
BALDOMERO TANIA GOLD CHIP ET/GANAD. BALDOMERO - ASTURIAS
BARBEIRO XACOBEO XANA/CASA BARBEIRO, S.C. - LUGO
BARCENIA MAR FEVER/S.A.T. BARCENIA 8.109 - CANTABRIA
BARREIRO 6150 XACOBEO/BARREIRO LODEIROS, S.C. - A CORUÑA
BENERA ALEXIA SHOTTLE/GANADERIA BENERA - CANTABRIA
BENERA PEREDA LALI FEVER ET/GANADERIA BENERA - CANTABRIA
BLANCO M.PRECIUS MANCIÑEIRA/BLANCO - PONTEVEDRA
BOS CARBALLEIRA ROY CONCAVA ET/SAT CARBALLEIRAS - PONTEVEDRA
CALLOBRO BRENDAL ESTRELA GZ/CALLOBRO HOLSTEIN - LUGO
CANEDA SIRIA BOWSER/S.A.T. A CAMPA - A CORUÑA
CARRAL CREGO CREGA/CARRAL - PONTEVEDRA
CARTERO DISCOVERY ESPINA/GANADERIA CARTERO, S.C. - ASTURIAS
CASA-NOVA ROMA SANCHEZ 859/GANAD. CARRO - A CORUÑA
CEDELIKA JEEP NOA/CEDELIKA - VIZCAYA
CELIS ALASKA NATALIA WILDMAN/GANADERIA MANOLERO - ASTURIAS
CERCADO 342/S.A.T. EL CERCADO Nº39146 - CANTABRIA
CID AFTERSHOCK MATICA/GANDEIRIA CID, S.C. - LUGO
CIUCENDE DANCER 9870/AGROCIOCENDE, S.C. - A CORUÑA
CLARA ALEXANDER SIRIA/CASA CLARA - ASTURIAS
COPA/IGLESIAS - ASTURIAS
COROMINES FBI CECILIA/S.A.T. Nº 708 CAN POL - GIRONA
CORU LUSTY RENE/CORU - ASTURIAS
COTO AMAZING EIRA/CASA COTO - ASTURIAS
DONATA DE HAGBENDEN/GRANJA JADO - CANTABRIA
ECHARPE 52/GANADERIA PUENTE, S.C. - ASTURIAS
EL.HAYA FEVER MARY/EL HAYA MATIENZO, C.B. - VIZCAYA
FERRERU DENZEL ESTRELLA/CASA EL FERRERU - ASTURIAS
FINAGA WINDBROOK LINDA/FINAGA - VIZCAYA
FISURE.CB TALENT MAÑANA/FISURE PORTILLO, C.B. - VIZCAYA
FLORA RUBENS MIRANDA/CASA FLORA. SDAD.CIVIL - ASTURIAS
GALLO B. LANDIS PERLORA/EL GALLO,S.C. - ASTURIAS
GAYERE OUTSIDE T. ALEGRIA/GAYERE C.B. - ASTURIAS
GUSTAVO BLITZ BISELA/IGLESIAS-FERRADAS, S.C. - PONTEVEDRA
GUSTAVO WINDBROOK BARRERA/IGLESIAS-FERRADAS - PONTEVEDRA
HNOS. GUTIERREZ NANA/HNOS. GUTIERREZ MADRAZO - CANTABRIA
ISABEL WILDMAN RUBI/GANADERIA ISABEL - ASTURIAS
JADO JANNA DAMION/GRANJA JADO - CANTABRIA
JOALFE GOLDWYN 640/MARCELO SEBRAN,S.C. - ASTURIAS
JULI/CASA GUILLERMO, S.C. - ASTURIAS
JULIANA MODEST MODESTA/CASA JULIANA - ASTURIAS
LA FLOR SID HOOKS/LA FLOR - CANTABRIA
LA HUERTA MARINERA BOLIVIA/LA HUERTA - CANTABRIA
LA RIVA SIRIA SIRACUSA/LA FLOR - CANTABRIA
LA.RIGADA ASHLAR LENINA/MURRIETA - VIZCAYA
LORENZO SANCHEZ SAYAKA/CASA LORENZO,S.C. - ASTURIAS
LOS CURTOS CIRA/LOS CURTOS, S.C. - CANTABRIA
LOS.TEJOS DAMION MAKALA/LOS TEJOS, C.B. - VIZCAYA
LUCARIA SANCHEZ LAURA/CASA LUCARIA - ASTURIAS
LUCARIA WINDBROOK ALASKA/CASA LUCARIA - ASTURIAS
M.R. KAIMAN SHOTTLE/EL MOLINO DE RUEDAS - CANTABRIA
M.R. NINJA SANCHEZ/EL MOLINO DE RUEDAS - CANTABRIA
MANOLERO GOLDWYN TIFANY/GANADERIA MANOLERO - ASTURIAS

MANOLON MERCHANT YOLI/CASA MANOLON, S.C. - ASTURIAS
MANTEIGA XACOBEO MANDARINA/GAN. MANTEIGA - PONTEVEDRA
MANTOÑO DESTRY RAETA/MANTOÑO HOLSTEIN - LUGO
MANTOÑO TALENT CHUECA/MANTOÑO HOLSTEIN - LUGO
MARCELO BOBA BOLTON/MARCELO SEBRAN,S.C. - ASTURIAS
MARIBEL AFTERSHOC FLOR/MARIBEL - VIZCAYA
MATIAS HENDALLA CHAMPION ET/GANADERIA LA CORONA - ASTURIAS
MENOR DUNHILL ZORBA/S.A.T. CASA MENOR 1017 XUGA - A CORUÑA
MIGUEL ROY GRETA/CASA MIGUEL - ASTURIAS
MIGUEL ROY SARA/CASA MIGUEL - ASTURIAS
NODI BRANDY XISTRA/NODI, S.C. - LUGO
NODI SCOOBY-DUU DUFANI/NODI, S.C. - LUGO
NOZALIN AITANA SANCHEZ/NOZALIN - ASTURIAS
NOZALIN MILLION MARILYN/NOZALIN - ASTURIAS
ONDARTZA SID 4122/ONDARTZA BITARTE SC - GUIPUZCOA
OUTEIRO TUNNO KEYTY/GANDERIA SINESIO, S.C. - A CORUÑA
PACHO ALADIN SATIRA/CASA DE PACHO - ASTURIAS
PACHO DUPLEX SALVIA/CASA DE PACHO - ASTURIAS
PACHO ELECTION LUBA/CASA DE PACHO - ASTURIAS
PACHO WINDBROOK FAVILA/CASA DE PACHO - ASTURIAS
PACHON ALMERIA MILAGROS/TAHOCES, S.C. - ASTURIAS
PATIO RAITANA B.GALAN/GAN. CACHORRO - ASTURIAS
PEREJIL MOSKONA ET/GRANJA PEREJIL "EL MACHO" - CANTABRIA
PORCILO JENNIFER JORDAN/GANADERIA PORCILO, S.C. - ASTURIAS
PORCILO RUBINA SHOTTLE/GANADERIA PORCILO, S.C. - ASTURIAS
RIBATXENT AIRRAID YERAI/RIBATXENTA S.L. - ALAVA
S.M. AMAYA CHAMPION/GANADERIA PARLERO, S.C. - ASTURIAS
SAGUALES ESPAÑOLA TALENT/GANADERIA SAGUALES - CANTABRIA
SARABIA SIRENA MILLION/SARABIA - CANTABRIA
SIERRA MARSIA MORTAL/SIERRA DE CUETO REDONDO - CANTABRIA
SOLAPEÑA TALENT MARIJO/SOLAPEÑA - VIZCAYA
TEZANILLOS SPIRTE STA MARIA/S.A.T. TEZANILLOS - CANTABRIA
TEZANILLOS WINDBROOK ROMA/S.A.T. TEZANILLOS - CANTABRIA
TEZANILLOS ZELATI VILMA/S.A.T. TEZANILLOS - CANTABRIA
TRESPANDIO SEPTEMBER LORENA/CASA LORENZO,S.C. - ASTURIAS
URBASA SPIRTE SUIZA/URBASA S.A.T. - ASTURIAS
URBASA STOL JOC YOLI/URBASA S.A.T. - ASTURIAS
URKITZE BATIDO ZIRA/C.NUEVA - VIZCAYA
VEIGA STORMATIC ARIKA/S.A.T. VEIGA - ASTURIAS
VENTURA RESTELL DANIELA/GANADERIA VENTURA, S.C. - ASTURIAS
VENTURO XUANUCO GW ALMUDENA ET/CASA VENTURO - ASTURIAS
VIÑES BUILDER SADE/GANADERIA VIÑES - ASTURIAS
VIÑES WINDBROOK FLOR/GANADERIA VIÑES - ASTURIAS
VILA 824 MEGAWHITE/S.A.T. GANADERIA VILA DE SANTAIA - A CORUÑA
5286 TALENT/S.A.T. M.LAVIN-LOREDO - CANTABRIA
6164 EMIR/LA MORAZA - CANTABRIA
6657 LENON/S.A.T. VALDEAMIGO - CANTABRIA
HEMBRAS MB DE 2º O MAS PARTOS - 86 PUNTOS
ACEBO GALLETERA DUPLEX/S.A.T. ACEBO CORRALES 8252 - CANTABRIA
ADELINA ALINO PANTOJA/LA PIENDA, S.C. - ASTURIAS
ADELINA PRIDE DELICIA/LA PIENDA, S.C. - ASTURIAS
ADELINA WONDER DELICADA/LA PIENDA, S.C. - ASTURIAS
ALCOTX FINALCUT CINIA/BLANCO - PONTEVEDRA
ALKONA/VIRGEN DEL CAMINO, S.C. - A CORUÑA
ALVAREZ DESIREE SENECA/GANADERIA ALVAREZ, S.C. - ASTURIAS
ALVAREZ GOLOSONA ROMEO/GANADERIA ALVAREZ, S.C. - ASTURIAS
AMANDI PEINADA SAMUELO/EL GALLO,S.C. - ASTURIAS
AMETSLEKU ASHLAR ZERUA/AMETSLEKU, C.B. - VIZCAYA
ANCILES 8527 JAMMER/CASA COTO - ASTURIAS
ANDIKOETX CHAMONIX DIANA/ANDIKOETXALDE, S.C. - ALAVA
AORMI FATIMA FEVER/AORMI - CANTABRIA
AR.MOLINO DUPLEX ITSASPE/EL MOLINO, S.C. - VIZCAYA
AR.MOLINO GRAND ARMOLA/EL MOLINO, S.C. - VIZCAYA
AR.MOLINO JORDAN ELARA/EL MOLINO, S.C. - VIZCAYA
ARANGAS SILVIA MEGAXION/ARANGAS, S.C. - ASTURIAS
ARCE CHAMONIX IRMA/S.A.T. ARCE III - CANTABRIA
ARCE CHAMONIX TONEL/S.A.T. ARCE III - CANTABRIA
ARCE JAMMER LITA/S.A.T. ARCE III - CANTABRIA
ARENAS MAHE PLANET/S.A.T. ARENAS Nº 39119 - CANTABRIA
ARENAS ORION SID/S.A.T. ARENAS Nº 39119 - CANTABRIA
ARRIETA AUDI/LAVIN - CANTABRIA
ARRONTE ANCHEN BAXTER/S.A.T. ARRONTE N.8434 - CANTABRIA
ARTEDO 8232 SIREX/EL ARTEDO, S.C. - ASTURIAS
ARTIME ASHLAR REBECA/AGROARTIME, S.C. - ASTURIAS
ARTIME BOLIVIA DESIRE/AGROARTIME, S.C. - ASTURIAS
ARTIME BOLIVIA JAN/AGROARTIME, S.C. - ASTURIAS
ARTIME DAMION CHAVELY/AGROARTIME, S.C. - ASTURIAS
ARTIME DAMION ELFA/AGROARTIME, S.C. - ASTURIAS
ARTIME DUPLEX OLIVIA/AGROARTIME, S.C. - ASTURIAS
ARTIME GRAND SUTIL/AGROARTIME, S.C. - ASTURIAS
ARTIME MILLION DISTA/AGROARTIME, S.C. - ASTURIAS
ARTIME SAREYO CITA/ARTIME, S.C. - ASTURIAS
ARTIME STEADY CARLA/AGROARTIME, S.C. - ASTURIAS
ARTIME STEADY LLANISCA/AGROARTIME, S.C. - ASTURIAS
ARTIME SUPER FLORET/AGROARTIME, S.C. - ASTURIAS
ARTIME WINDBROOK ALIADA/AGROARTIME, S.C. - ASTURIAS
BADIOLA SANCHEZ LOLES/GAN. DIPLO. BADIOLA - ASTURIAS
BADO DIANA CHAMONIX/S.A.T. SERJA Nº 39018 - CANTABRIA
BALDOMERO BERY CHARLY/GANAD. BALDOMERO - ASTURIAS
BALDOMERO CAVA SANCHEZ/GANAD. BALDOMERO - ASTURIAS
BALDOMERO ROXANNE SANCHEZ/GANAD. BALDOMERO - ASTURIAS
BALDOMERO WANA SANCHEZ/GANAD. BALDOMERO - ASTURIAS
BARBEIRO BRANDY BRANDA/CASA BARBEIRO, S.C. - LUGO
BARBEIRO OUTSIDE SINA/CASA BARBEIRO, S.C. - LUGO
BARCENA TRINI/CASA GUILLERMO, S.C. - ASTURIAS
BARCENIA CORA SCOOBY DUU/S.A.T. BARCENIA 8.109 - CANTABRIA
BARDASQUERA DELAROSA 3813/GANAD. BARDASQUERA - ASTURIAS
BARDASQUERA RAMOS 7857/GANAD. BARDASQUERA - ASTURIAS
BARDASQUERA RESTELL X 3810/GANAD. BARDASQUERA - ASTURIAS
BARGAÑA LEGEND ANAIS/LA BARGAÑA, S.C. - ASTURIAS
BEHI-ALDE CHICAGO 5396/COOPERATIVA BEHI-ALDE - ALAVA
BEHI-ALDE TALON 5775/COOPERATIVA BEHI-ALDE - ALAVA
BERNARDO LUME MYSTRI PANDORA/BERNARDO - ASTURIAS
BLANCO DIALMA PELBIS ET/BLANCO - PONTEVEDRA
BLANCO FRANCHESCA/BLANCO - PONTEVEDRA
BLANCO KASANDRA/BLANCO - PONTEVEDRA
BLANCO LAURIE SHEIK LAUSI/BLANCO - PONTEVEDRA
BLANCO MANUELA/BLANCO - PONTEVEDRA
BLANCO ROSE BETHANY/BLANCO - PONTEVEDRA
BLANCO URSULA UXIA/BLANCO - PONTEVEDRA
BLANCO VESCE/BLANCO - PONTEVEDRA
BOS RIVERABASILIO BOLTON ET/GANADERIA RIVERA, S.L. - PONTEVEDRA
C.NUEVA TOBY TIANA/C.NUEVA - VIZCAYA
C.V. WENDY IOTA/S.A.T. N 39001 CUATROVIENTOS - CANTABRIA
CACHORRO SANCHEZ CLAUDIA/GAN. CACHORRO - ASTURIAS
CALLOBRO GERARD SIMPATICA/CALLOBRO HOLSTEIN - LUGO
CAMBA SONIA MAGREBI/CAMBA DE LOUREIROS - A CORUÑA
CAMPO CLEMENTINA/S.A.T.EL CAMPO DE ANERO 7305 - CANTABRIA
CARBALLEIRAS STEADY NICA/S.A.T. CARBALLEIRAS - PONTEVEDRA
CARBAYEDA ANDABAO LURDES/CARBAYEDA - ASTURIAS
CARBAYEDA MESSY CLAUDIA/CARBAYEDA - ASTURIAS
CARPACEIRA MAGREBI Nº8053/A CARPACEIRA DE CAMPOS-A CORUÑA
CARRAL JEFFERSON PALOMA/CARRAL - PONTEVEDRA
CARTEIRO 282 BUCKEYE/GANDEIRIA CARTEIRO, S.C. - A CORUÑA
CARTEIRO 297 MR BURNS/GANDEIRIA CARTEIRO, S.C. - A CORUÑA
CASA DE LOLA CHISPA XACOBEO/CASA DE LOLA - A CORUÑA
CASA LUIS NICOL LARA/CASA LUIS - ASTURIAS
CASA-NOVA CARMELE AMSTERDAM 88/GANAD. CARRO - A CORUÑA
CASA-NOVA MAITE MINISTER 848/GANAD. CARRO - A CORUÑA
CASA-NOVA MARTINA WILDMAN 820/GANAD. CARRO - A CORUÑA
CASIMIRO BOLIVIA ARTILLERA/CASA CASIMIRO, S.C. - ASTURIAS
CASTRO KIKA KINGLY/CASA CASTRO, S.C. - A CORUÑA
CECA BIDE TOJO 388 TOJO/CECA BIDEGAIN, S.COOP. - ALAVA
CECILIA TRIBUTE SELENA/CECILIA - ASTURIAS
CELISTO LISA DENZEL/CASA CELISTO - ASTURIAS
CENIZAL CRESI ALINO/GANADERIA BERNABE, S.C. - ASTURIAS
CENTRAL 1458/GANADERIA LA CENTRAL, S.C. - ASTURIAS
CERNADAS 23 BUCKEYE/CERNADAS, S.C. - A CORUÑA
CHINELO DOCOBO 6448/CHINELO, C.B. - LUGO
CHOUSA STEADY SARA/GANADERIA A CHOUSA, S.L. - LUGO
CHUSCO SC TALENT SHAKYRA/CHUSCO, S.C. - LUGO
CID ALEXANDER AGRA/GANDEIRIA CID, S.C. - LUGO
CIUCENDE TOYSTORY 9898/AGROCIOCENDE, S.C. - A CORUÑA
CLARA DUPLEX SHARON/CASA CLARA - ASTURIAS
COBERTORIA GRETA SUPPORT/CASA ESTEBAN - ASTURIAS
CORONA LHEROS QUETI/GANADERIA LA CORONA, SL - ASTURIAS
CORU VALDES ERIKA/CORU - ASTURIAS
COTO DAMION EMBLEMA/CASA COTO - ASTURIAS
COTO SANCHEZ ALEXANDRA/CASA COTO - ASTURIAS
COVES VEAS BOLIVIA JA PROU/BLANCO - PONTEVEDRA
CRUZ LEZAMA ELECTRA TOYSTORY/S.A.T. CRUZ LEZAMA - CANTABRIA
CRUZ LEZAMA FATIMA SHOT/S.A.T. CRUZ LEZAMA - CANTABRIA
CUDAÑA GERALDITA SPIRTE/JAVIER CANTERO GUTIERREZ - ASTURIAS
CUESTA SAMBITA SANCHEZ/CUESTA VEGA - CANTABRIA
DEL LLANO AFRODITA ROPPA/EL LLANO, S.C. - CANTABRIA
DORIS/S.A.T. AGRIC.JUNQUERA COLMEIRO, S.C. - PONTEVEDRA
EL ANDRAL 452 LIA/S.A.T. EL ANDRAL - CANTABRIA
EL CORINO SAHIRA SPIRTE/EL CORINO S.C. - CANTABRIA
EL CORRAL GINEBRA RIVERA/IGLESIAS - ASTURIAS
EL CRUCE CHAMPION VALERIA/S.A.T. EL CRUCE - CANTABRIA
EL CRUCE JERRICK TASIA/S.A.T. EL CRUCE - CANTABRIA
EL CRUCE LAUTHORITY CARMELA/S.A.T. EL CRUCE - CANTABRIA
EL.HAYA CHAMONIX NEKA/EL HAYA MATIENZO, C.B. - VIZCAYA
EL.HAYA FEVER PATY/EL HAYA MATIENZO, C.B. - VIZCAYA
EL.HAYA STEADY CHISPA/EL HAYA MATIENZO, C.B. - VIZCAYA
ENRIQUE MCAIN MICAELA/EXP.GAN.CASA ENRIQUE, C.B. - ASTURIAS
ERTXIN BA EMIR 5263/ERTXIN BASERRIA - GUIPUZCOA
ESCAROLO CATALINA DENZEL/CASA ESCAROLO - ASTURIAS
ESPINO LUNA LAUTHORITY/LA ISLA, S.C. - CANTABRIA
EVMOSI DOLMAN FLORA/GANADERIA VILLA - CANTABRIA
F.M. 3965 MILLION 1916/S.A.T. FAMILIA MARTINEZ - A CORUÑA
F.M. 8645 LAKOTA/S.A.T. FAMILIA MARTINEZ - A CORUÑA
F.M. 9008 DUPLEX 6932/S.A.T. FAMILIA MARTINEZ - A CORUÑA
FACIO GERARD LEONORA/GANAD. FACIO HOLSTEIN - ASTURIAS
FACIO WINDBROOK SANDY/GANAD. FACIO HOLSTEIN - ASTURIAS
FANSION COMPLEX DUNA/CASA FANSION, S.C. - ASTURIAS
FARIÑEIRO WISCONSIN ANDY ROJA/FARIÑEIRO S.A.T. Nº 1049 - LUGO
FERRERU NEVOR MARAVILLA/CASA EL FERRERU - ASTURIAS
FIGUERAS/S.A.T. A CAMPA - A CORUÑA
FINAGA LOU MARCIA/FINAGA - VIZCAYA
FISURE.CB BOLIVIA PAULA/FISURE PORTILLO, C.B. - VIZCAYA
FISURE.CB GOLDWYN AGLAIA/FISURE PORTILLO, C.B. - VIZCAYA
FISURE.CB WINDBROOK TANIA/FISURE PORTILLO, C.B. - VIZCAYA
FONTELAS BOLTON 536/S.A.T. XUGA 747 FONTELAS - A CORUÑA
FRADE AMSTERDAM SHAKIRA/GANADERIA FRADE,S.C. - PONTEVEDRA
GAHYNA 2948/GANADERIA LA PEDROSA - ASTURIAS
GAMBA 2951/GANADERIA LA PEDROSA - ASTURIAS
GAYERE C. BUCKEYE WONDER/GAYERE C.B. - ASTURIAS
GAYERE LOYOLA CUP MILLION/SAMASILVA - ASTURIAS
GENER BAMBU SHERIFF 1056/MAS GENER S.C.P. - GIRONA
GENER BIFFER BEACON 1047 ET/MAS GENER S.C.P. - GIRONA
GENER GERRY JEEVES 991/MAS GENER S.C.P. - GIRONA
GENER-SOLA AL MAR 1087 ET/MAS GENER S.C.P. - GIRONA
GUARIN CRICKET CALIMA/GANADERIA GUARIN, S.C. - ASTURIAS
GUSTAVO TALENT TALEA/IGLESIAS-FERRADAS, S.C. - PONTEVEDRA
HERBARFER PICOLO RE PERLA/HERBARFER - VIZCAYA
HERVICAM MILEYDI TOYSTORY/S.A.T. HERVICAM - CANTABRIA
HONDAL VICTORIA DUPLEX/HONDAL - CANTABRIA
HS DERRY ALCAZAR/URBASA S.A.T. - ASTURIAS
ILMA GABOR 39/S.A.T. 828 ILMA-XUGA - A CORUÑA
ILMA 0080 BOLTON/S.A.T. 828 ILMA-XUGA - A CORUÑA
JACINTO BOLIVIA MELODY/HJOS.DE JACINTO GUTIERREZ - ASTURIAS
JACINTO MR BURNS BORGIA/HJOS.DE JACINTO GUTIERREZ - ASTURIAS
LA CALEONA WONDER EMPERATRIZ/LA CALEONA, S.C. - ASTURIAS
LA CAMPERA CARETA BARCENA/CASA LUIS - ASTURIAS
LA CORONA KNOWLEDGE 4848/GANADERIA LA CORONA - ASTURIAS
LA CORONA 4870 DENZEL/GANADERIA LA CORONA, SL - ASTURIAS
LA CORONA 4906 STEADY/GANADERIA LA CORONA, SL - ASTURIAS
LA FLOR DUPLEX ISLA/GANADERIA LA FLOR, S.C. - ASTURIAS
LA JORCADA TAMBO 3631/EL PASIEGU - ASTURIAS
LA LLERA RODA ROY/EL GALLO,S.C. - ASTURIAS
LA PONDEROSA JEFFERSON ALESIA/CASA LEONARDO,S.C. - ASTURIAS
LABIÑUELA DUPLEX RAQUEL/LA BIÑUELA - VIZCAYA
LABIÑUELA TALENT TRANCAS/LA BIÑUELA - VIZCAYA
LARREA S. DUPLEX AMETZA/LARREA S.C. - ALAVA
LARREA S. JORDAN DULANTZI/LARREA S.C. - ALAVA
LAS ESCUELAS WILDMAN 5581/LAS ESCUELAS - ASTURIAS
LASTRA LEONA GRAND/S.A.T. CRUZ LEZAMA - CANTABRIA
LAXOBAL TALENT SOFIA/COLEGIO NTRA.SRA.DE FATIMA - ASTURIAS
LINA TEE OFF SHAKIRA/LINA - LUGO
LLAMAS CORAL CURRA/GANADERIA LAS LLAMAS, S.C. - ASTURIAS
LLERA NAVIGATOR VENUS/GANADERIA LA LLERA, S.C. - ASTURIAS
LLONGUERA DISCOVER ROCA/S.A.T. LA LLONGUERA - ASTURIAS
LLONGUERA LHEROS SABINA/S.A.T. LA LLONGUERA - ASTURIAS
LLUISA DUPLEX FIONA/GAND.LAS PALOMAS, S.C. - ASTURIAS
LLUISA SID SIDRA/S.A.T. LLUISA - ASTURIAS
LLUISA WINDBROOK HOLLY/S.A.T. LLUISA - ASTURIAS
LLUISA WONDER WONDERFULL/S.A.T. LLUISA - ASTURIAS
LLUISA XACOBEO JACA/S.A.T. LLUISA - ASTURIAS
LOS CURTOS KIARA/LOS CURTOS, S.C. - CANTABRIA
LOS.TEJOS GOLDWYN LIRYA/LOS TEJOS, C.B. - VIZCAYA
LOUCENZO SANCHEZ TORTOLA/GANDEIRIA LOUCENZO - PONTEVEDRA
LOUREIROS ARZUA TOYSTORY/RIAL DE LOUREIROS - A CORUÑA
LOUREIROS PALMERA BUCKEYE/RIAL DE LOUREIROS - A CORUÑA
LUCARIA ALEXANDER YAMAHA/CASA LUCARIA - ASTURIAS
LUCARIA SANCHEZ PALOMA/CASA LUCARIA - ASTURIAS

LUCHO LINDY SIRA/LUCHO, S.C. - ASTURIAS
MANOLERO LAUTHORITY KELBY/GANADERIA MANOLERO - ASTURIAS
MANOLERO LAUTHORITY SINDY/GANADERIA MANOLERO - ASTURIAS
MANOLERO VALIDO VALIOSA/CASA PANERO - ASTURIAS
MANTEIGA MAGREBI CACHORRA/GANA. MANTEIGA - PONTEVEDRA
MARCELO XSARA XACOBEO/MARCELO SEBRAN,S.C. - ASTURIAS
MARIBEL ROBIN VALENTINA/MARIBEL - VIZCAYA
MARQUES STEADY YANIRA/MARQUES, S.C. - ASTURIAS
MARQUES TALENT QUETA/MARQUES, S.C. - ASTURIAS
MENOR ALAN YOCO/S.A.T. CASA MENOR 1017 XUGA - A CORUÑA
MINGO LUSTY ZAMBA/CASA MINGO, S.C. - ASTURIAS
MINGO STEADY MAELA/CASA MINGO, S.C. - ASTURIAS
MONASTERIO SC CHALAR MARUCHI/GANADERIA MONASTERIO - LUGO
MONASTERIO SHOTTLE VENDETA/SC GANADERIA MONASTERIO - LUGO
MURRIETA WINDBROOK ALHAMBRA/MURRIETA - VIZCAYA
NAYO SPIRTE PARISINA/CASA LEONARDO,S.C. - ASTURIAS
NIEBLA/EL VENTORRILLO - CANTABRIA
NORINO DENZEL SBIKA/GANADERIA ALBAUR,S.C. - ASTURIAS
NORINO DICTATOR ZAMBIA/GANADERIA ALBAUR,S.C. - ASTURIAS
OBISPO BOLIVIA NATIVEL/GANADERIA EL OBISPO, S.C. - ASTURIAS
ONDARTZA SID 3773/ONDARTZA BITARTE SC - GUIPUZCOA
OS AMERICANOS LAUTHORITY 4222/OS AMERICANOS - PONTEVEDRA
OUTEIRO AIRRAID BRUSKA/CALLOBRO HOLSTEIN - LUGO
OUTEIRO ARTIE BRUMA ROJA/OUTEIRO,S.C. - LUGO
OUTEIRO GABOR CHIAPA/OUTEIRO,S.C. - LUGO
OUTEIRO SID BRECHA/OUTEIRO,S.C. - LUGO
OUTEIRO TALENT ANGELA/GANDERIA SINESIO, S.C. - A CORUÑA
PACHO GOLDWYN FOLIA/CASA DE PACHO - ASTURIAS
PACHON ALINO TELMA/TAHOCES, S.C. - ASTURIAS
PALOMAS SOSA LULU/GAND. LAS PALOMAS, S.C. - ASTURIAS
PATALLO PICARD ALELI/TOÑO PATALLO - ASTURIAS
PATALLO SEAVER SABIONA/TOÑO PATALLO - ASTURIAS
PEBI GREEN/S.A.T. Nº 708 CAN POL - GIRONA
PEDREGAL ALINO VELA/EL PEDREGAL, S.C. - ASTURIAS
PEDREGAL BUCKEYE ARIEL/CASA FERREIRO, S.C. - ASTURIAS
PENEDO XESTA JORDAN/FINCA MARISA - A CORUÑA
PONDEROSA ASHLAR AMELIE/GANADERIA PARLERO, S.C. - ASTURIAS
PONDEROSA TALENT MARIA ROJA/LA FLOR - CANTABRIA
POSADA SABLON KATRERINA/CASA POSADA - ASTURIAS
POYO ALEXANDER ALEJANDRA/GANADERIA CASA POYO - ASTURIAS
POYO DJIBY JIVARA/GANADERIA CASA POYO, S.C. - ASTURIAS
POYO TOYSTORY ANA/GANADERIA CASA POYO, S.C. - ASTURIAS
POYO TOYSTORY TOLE/GANADERIA CASA POYO, S.C. - ASTURIAS
POZA LONGTIME MICAELA/LA POZA HOLSTEIN - CANTABRIA
PUENTE BAXTER JUANA/GANADERIA PUENTE, S.C. - ASTURIAS
QUEVEDO BAXTER KATA/GANADERIA QUEVEDO, S.C. - ASTURIAS
QUINTANA MISIL 634 BOLTON/S.A.T. QUINTANA N. 7259 - CANTABRIA
REGUERA BLANCA BIRDIE/GANADERIA LA REGUERA,S.C. - ASTURIAS
REGUERA NICOL CUKA/CASA REGUERA - ASTURIAS
REGUERA SPIRTE CARINA/CASA REGUERA - ASTURIAS
RIBATXENT MICKEY ZIG-ZAG/RIBATXENTA S.L. - ALAVA
RICARDO MORA EMIR/LA CASA - CANTABRIA
RIVERABASILIO MAGOT 7768/GANADERIA RIVERA, S.L. - PONTEVEDRA
ROQUE TAMARGO SHEILA/CASA ROQUE - ASTURIAS
S. ATLAS 5721/SARRAGA - CANTABRIA
SAGUALES COPITO SEPTEMBER/GANADERIA SAGUALES - CANTABRIA
SAN XULIAN 6387 MISCHIEF/S.A.T. SAN JULIAN - A CORUÑA
SEOANE BOLTON VICKY 241/GANDEIRIA SEOANE,S C. - A CORUÑA
SEOANE IGNITER ENERITZ 208/GANDEIRIA SEOANE,S C. - A CORUÑA
SERGIO STIO STELA/CASA DE SERGIO - LUGO
SERJA PERLA GENEVA/S.A.T. SERJA Nº 39018 - CANTABRIA
SERPA BONAIR GABRIELA/S.A.T. EL CRUCE - CANTABRIA
SIMON DUPLEX GONDOLA/SIMON - ASTURIAS
SOLAPEÑA EVEREST JARA/SOLAPEÑA - VIZCAYA
SOMASPRILLA ROSARIO GENOMICO/S.A.T. SOMASPRILLA - CANTABRIA
TEZANILLOS DENZEL MANUELA/S.A.T. TEZANILLOS - CANTABRIA
TEZANILLOS WINDBROOK CELTIBERA/S.A.T. TEZANILLOS - CANTABRIA
TOMAS PONCELLA TALON/CAL TOMAS - GIRONA
TONJOVI JULIETA ROMEO/TONJOVI - ASTURIAS
TONJOVI SPECTRUM JENNI/TONJOVI - ASTURIAS
TORAL QUINTANA IDARGA/EL TORAL - ASTURIAS
TORRE ALANIS TOYSTORY/PRESMANES CAGIGAS, S.C. - CANTABRIA
TRIQUEL BUILDER NANCY/GANADERIA TRIQUEL, S.C. - ASTURIAS
UGASMA GOLDWYN 6999/UGASMA - A CORUÑA
URBASA BOLIVIA FLECHA/URBASA S.A.T. - ASTURIAS
URBASA COMA ROY VANESA/URBASA S.A.T. - ASTURIAS
URBASA COMAROY MARTINA/URBASA S.A.T. - ASTURIAS
URBASA ZIZUR ELBA/URBASA S.A.T. - ASTURIAS
UZQUIANO- DUPLEX UZQUIANO/ZALDUBITXI S.C. PEQUEÑA - ALAVA
UZQUIANO- TEE OFF UZKIANO 3/ZALDUBITXI S.C. PEQUEÑA - ALAVA
VALIENTE CHAMPION PAZITA/CASA VALIENTE, S.C. - ASTURIAS
VALIENTE GABOR MONTANA/VALIENTE - ASTURIAS
VALIENTE KINGLY TIMA/VALIENTE - ASTURIAS
VALIENTE SID QUINDY/VALIENTE - ASTURIAS
VEGA LURECK MATILDE/CASA VEGA - ASTURIAS
VEGA PRIDE COLOMBIANA/CASA VEGA - ASTURIAS
VEGA SEPTEMBER CHATA/CASA VEGA - ASTURIAS
VEIGA AARON GYPSY/S.A.T. VEIGA - ASTURIAS
VEIGA BAXTER TAYS/S.A.T. VEIGA - ASTURIAS
VEIGUEIRO LOFFICIEL LIMA/VEIGUEIRO S.C. GALEGA - LUGO
VIÑA BLITZ BOA/CASA VIÑA, S.C. - ASTURIAS
VIÑA SHOTTLE NURIA/CASA VIÑA, S.C. - ASTURIAS
VIÑES PELAYO COLETA/GANADERIA VIÑES - ASTURIAS
VIÑES SID SIRA/GANADERIA VIÑES - ASTURIAS
VILA 746 SEPTEMBER/S.A.T. GANADERIA VILA DE SANTAIA - A CORUÑA
VILLANUEVA PASTORA BURNS ROJA/GANAD. VILLANUEVA - ASTURIAS
WANDI 42 83-042/ALFREDO JOSE PEREZ FDEZ - ASTURIAS
XACOBO AMBAR Nº18/G. XACOBO - A CORUÑA
XACOBO SHOTTLE Nº31/G. XACOBO - A CORUÑA
XIROMO ROZA ROYMARY 581/CASA XIROMO - ASTURIAS
XUAN FERNAN SILKA PRIDE/CASA XUANFERNAN - ASTURIAS
0223/S.A.T. BERNALLAN N.9127 - CANTABRIA
0363 SEPTEMBER/S.A.T. VALDEAMIGO - CANTABRIA
04113404/BIDARTE BASERRIA - GUIPUZCOA
168/EL MOLINERO SERV.AGROP.S.L. - ASTURIAS
670 CALZADA PATRICIA PLANETE/S.A.T. ISIDRO - A CORUÑA
7140/S.A.T. BERNALLAN N.9127 - CANTABRIA
8605 BAXTER/S.A.T. M.LAVIN-LOREDO - CANTABRIA
9575 JOCKORM/GANDEIRIA OTERO MERELA,S.C. - A CORUÑA
HEMBRAS MB DE 2º O MAS PARTOS - 85 PUNTOS
A.JUNQUERA NAUTILUS XIOMARA/JUNQUERA COLMEIRO-PONTEVEDRA
A-ESPAGNOL/LA ISLA, S.C. - CANTABRIA
ACEBO PASIEGA SHOTTLE/S.A.T. ACEBO CORRALES 8252 - CANTABRIA
ADELINA MIÑOROJO PLANETA/LA PIENDA, S.C. - ASTURIAS
AGIRRESOR FEVER 121/AGIRRESOROAUNDI,S.C. - GUIPUZCOA
AGIRRESOR FEVER 129/AGIRRESOROAUNDI,S.C. - GUIPUZCOA
AGIRRESOR JORDAN 120/XABORDEGI BASERRIA - GUIPUZCOA
ALCALDE AIRBAG LINDA ROJA/CASA ALCALDE - ASTURIAS
ALDAMA L ICE PACK/ALDAMA LANDAZURI, S.C. - ALAVA
ALVAREZ BEYONCE BUCKEYE/GANADERIA ALVAREZ, S.C. - ASTURIAS
ALVAREZ LARINA XACOBEO/GANADERIA ALVAREZ, S.C. - ASTURIAS
ALVAREZ MARTA RUMBO/GANADERIA ALVAREZ, S.C. - ASTURIAS
ANCILES 5594/LA PIENDA, S.C. - ASTURIAS
ANDURIÑA MIQUEL TITA/SC GANADERIA ANDURIÑA - LUGO
ANIBAL CORNELIA II/S.A.T. CARBALLEIRAS - PONTEVEDRA
ANIBAL LENIE III/S.A.T. CARBALLEIRAS - PONTEVEDRA
ANTONIN ALINO ALINA/CASA ANTONIN - ASTURIAS
AR.MOLINO DUBAI ARGIDER/EL MOLINO, S.C. - VIZCAYA
AR.MOLINO JEEVES IXONE/EL MOLINO, S.C. - VIZCAYA
AR.MOLINO SID OLAZTI/EL MOLINO, S.C. - VIZCAYA
ARCE ALMERIA HANNA/S.A.T. ARCE III - CANTABRIA
ARCE RUSH RITA/S.A.T. ARCE III - CANTABRIA
ARCE SHOTTLE METTA/S.A.T. ARCE III - CANTABRIA
ARENAS MARIEL SPIRTE/S.A.T. ARENAS Nº 39119 - CANTABRIA
ARENAS MARIOLA CHICAGO/ARRABAL, S.C. - CANTABRIA
ARENAS WYNONA IOTA/S.A.T. ARENAS Nº 39119 - CANTABRIA
ARGOMOTA SHOTTLE SPOTTIE/LA ARGOMOTA - ASTURIAS
ARGOMOTA SID MIKA/LA ARGOMOTA - ASTURIAS
ARGOMOTA WINDBROOK KINTA/LA ARGOMOTA - ASTURIAS
ARMUCELA LUCUS RUDOLPH/GANDEIRIA ARMUCELA, S.C. - A CORUÑA
ARRABAL VALERIA/ARRABAL, S.C. - CANTABRIA
ARRONTE HELMI BAXTER/S.A.T. ARRONTE N.8434 - CANTABRIA
ARRONTE KIA JORDAN/S.A.T. ARRONTE N.8434 - CANTABRIA
ARRONTE LITA DEMPSEY/S.A.T. ARRONTE N.8434 - CANTABRIA
ARRONTE NICKI XACOBEO/S.A.T. ARRONTE N.8434 - CANTABRIA
ARTATXU B BASAURI LUZENA/ARTATXU BASERRIA - GUIPUZCOA
ARTATXU B CHAMONIX LINDANA/ARTATXU BASERRIA - GUIPUZCOA
ARTEDO 2604 ANDABAO/EL ARTEDO, S.C. - ASTURIAS
ARTIME BOLIVIA FLOR/AGROARTIME, S.C. - ASTURIAS
ARTIME DOLMAN SANY/AGROARTIME, S.C. - ASTURIAS
ARTIME DOMINATOR SARA/ARTIME, S.C. - ASTURIAS
ARTIME FEVER MILAN/AGROARTIME, S.C. - ASTURIAS
ARTIME JERRICK DESIRE/AGROARTIME, S.C. - ASTURIAS
ARTIME JERRICK PANAMA/AGROARTIME, S.C. - ASTURIAS
ARTIME JORDAN JAN/AGROARTIME, S.C. - ASTURIAS
ARTIME JORDAN PATRICIA/AGROARTIME, S.C. - ASTURIAS
ARTIME LAKOTA HARMONIE/AGROARTIME, S.C. - ASTURIAS
ARTIME MILLION ENYA/AGROARTIME, S.C. - ASTURIAS
ARTIME NAVIGATOR DELICIA/ARTIME, S.C. - ASTURIAS
ARTIME TEE OFF FREEDOM/AGROARTIME, S.C. - ASTURIAS
ARTIZAR L BONFIRE/ARTIZAR-LATZA, S.L. - ALAVA
ARTIZAR L SANCHEZ/ARTIZAR-LATZA, S.L. - ALAVA
ARUSE ALLIANCE AVATAR/S.A.T. ARUSE - ASTURIAS
ARUSE ALLIANCE PIROPO/S.A.T. ARUSE - ASTURIAS
ARUSE LAUTHORITY HIPNOSIS ET/S.A.T. ARUSE - ASTURIAS
ARUSE LIONEL ORLA/S.A.T. ARUSE - ASTURIAS
ASTURAO SC SUPER MARIPOSA/GANADERIA ASTURAO, S.C. - LUGO
AVELINA/GANADERIA RASILLO, S.L. - CANTABRIA
BADIOLA GIBSON CHERY/GAN. DIPLO. BADIOLA - ASTURIAS
BADIOLA JORDAN MARTIKA/GAN. DIPLO. BADIOLA - ASTURIAS
BADIOLA WONDER LUCA/GAN. DIPLO. BADIOLA - ASTURIAS
BALDOMERO CANELA ROY/GANAD. BALDOMERO - ASTURIAS
BALDOMERO DINA STRUIK/GANAD. BALDOMERO - ASTURIAS
BALDOMERO R-200 DESTRY/GANAD. BALDOMERO - ASTURIAS
BALDOMERO TALIA GOLD CHIP ET/GANAD. BALDOMERO - ASTURIAS
BALDOMERO TIFA SANCHEZ/GANAD. BALDOMERO - ASTURIAS
BANQUERO MERCHE GAVOR/RODRIGUEZ Y FERNANDEZ - ASTURIAS
BANQUERO NIRVANA TOYSTORY/RODRIGUEZ Y FERNANDEZ - ASTURIAS
BARCA ANDROS KATERINA/LA BARCA, S.C. - ASTURIAS

BARCA PILOTO NADIA/LA BARCA, S.C. - ASTURIAS
BARCENIA INDIA KAMPMAN/S.A.T. BARCENIA 8.109 - CANTABRIA
BARDASQUERA BAXTER 8569/GANAD. BARDASQUERA - ASTURIAS
BARDASQUERA GABA 2286/GANAD. BARDASQUERA - ASTURIAS
BARGAÑA ZIPI SELENA/LA BARGAÑA, S.C. - ASTURIAS
BARTUELO PILOTO LIDIA/BARTUELO - ASTURIAS
BEHI-ALDE OREGON 5739/COOPERATIVA BEHI-ALDE - ALAVA
BENINA DUPLEX MALENA/CASA BENIGNA - ASTURIAS
BIDARTE B CHAMONIX 2517/BIDARTE BASERRIA - GUIPUZCOA
BISBARRA BRODHER NAR-XOSE/NAR-XOSE S.C. GALEGA - LUGO
BLANCO ANABEL KEVYN/GANADERIA BLANCO, S.C. - ASTURIAS
BLANCOH. BAXTER SALVORIÑA/BLANCO - PONTEVEDRA
BORDA ZAH MILLION 984/BORDA ZAHAR BASERRIA-ALZA - GUIPUZCOA
BOS OS AMERICANOS WIN. 4237 ET/OS AMERICANOS - PONTEVEDRA
BOS WINDBROOK SHONIA ET/IGLESIAS-FERRADAS, S.C. - PONTEVEDRA
BOS XACOBEO SELENE ET/S.A.T. A MELLA 1068 XUGA - A CORUÑA
BRANIZA GATILLA/BRANIZA - CANTABRIA
BUSTO AMARO TOJA/GARCIA DEL BUSTO, S.C. - ASTURIAS
C. ROQUI LOLA/S.A.T. EL COTERON - CANTABRIA
C. SEAVER SAMANTA/S.A.T. EL COTERON - CANTABRIA
C. YANK INES/S.A.T. EL COTERON - CANTABRIA
C.B.S.I. JORDAN JUNE/SAN ISIDRO - VIZCAYA
C.NUEVA AIRRAID ARTZAINAK/C.NUEVA - VIZCAYA
C.V. CORAL BOULDER/S.A.T. N 39001 CUATROVIENTOS - CANTABRIA
C.V. GREIS MR BURNS/S.A.T. N 39001 CUATROVIENTOS - CANTABRIA
CA VALIENTE SEAVER PAMELA/CASA VALIENTE, S.C. - ASTURIAS
CAÑADAS SOLANA GABRIEL/S.A.T. MANTECA-SAINZ 39096 - CANTABRIA
CABANARES DENA SAHARA/LOS CABANARES S.C. - ASTURIAS
CABANARES DIAMA CINZANO/LOS CABANARES S.C. - ASTURIAS
CACHORRO LAUTHORITY PALOMA/GAN. CACHORRO - ASTURIAS
CACHORRO RESTELL LOLA/GAN. CACHORRO - ASTURIAS
CALEONA SHOTTLE CANICA/RONDEROS Y GARCIA, S.C. - ASTURIAS
CALEYU TARA SUNDAY/PRUDENCIO GRANDA VIÑA - ASTURIAS
CALLEJAS NEVADA 5057 MARCONI/LAS CALLEJAS, S.C. - CANTABRIA
CALLOBRO DESTRY BRICIA GZ/CALLOBRO HOLSTEIN - LUGO
CAMACHO TALENT LILY/CASA CAMACHO - ASTURIAS
CAMBA SARA XACOBEO/CAMBA DE LOUREIROS - A CORUÑA
CAMPA CID 2649/S.A.T. FINCA EL PILAR 868 XUGA - A CORUÑA
CAMPA XACOBEO 0917/S.A.T. FINCA EL PILAR 868 XUGA - A CORUÑA
CAMPIN MEDALLA LEMMER/CASA CAMPIN - ASTURIAS
CANDELAS RUGBY MIREN/LAS CANDELAS - VIZCAYA
CANTU WONDER REBELDE/GANADERIA EL CANTU,S.C. - ASTURIAS
CAPADOR FRIOL CHUS/S.A.T. CAPADOR - LUGO
CARBALLEIRAS DELETE DIVINA/S.A.T. CARBALLEIRAS - PONTEVEDRA
CARBALLEIRAS DELETE ZAFIRA/S.A.T. CARBALLEIRAS - PONTEVEDRA
CARBALLEIRAS JORDAN BEA/S.A.T. CARBALLEIRAS - PONTEVEDRA
CARBALLEIRAS WINDBROOK ADA/S.A.T. CARBALLEIRAS - PONTEVEDRA
CARBAYEDA ALINO MARIETA/CARBAYEDA - ASTURIAS
CARBAYEDA MESSY KARINA/CARBAYEDA - ASTURIAS
CARBAYEDA WONDER ALFA/CARBAYEDA - ASTURIAS
CARLOS CARLA GAVOR/CASA CARLOS, S.C. - ASTURIAS
CARLOS XACOBEO TELMA/CARLOS IGLESIAS CARREIRA - LUGO
CARRIS ASHLAR MARQUESA/CARRIS - LUGO
CASA DE LOLA SACHA JORDAN/CASA DE LOLA - A CORUÑA
CASA LUIS ANIBAL ANGELA/CASA LUIS - ASTURIAS
CASA NOVA BUILDER JOYA/EXP.GAN.CASANOVA, S.C. - LUGO
CASA NOVA REDENTOR LOMA/EXP.GAN.CASANOVA, S.C. - LUGO
CASA-NOVA MAR BAXTER 854/GANAD. CARRO - A CORUÑA
CASABLANCA MAGISTRATE ROMULA/S.A.T. CASABLANCA - CANTABRIA
CASAMARIANO LHEROS BRISA/CASA MARIANO - PONTEVEDRA
CASANOVA ASHERS FRAGATA/EXP.GAN.CASANOVA, S.C. - LUGO
CASERIO L GRAND 366 CORAL/FELIX SAEZ PORTILLA - ALAVA
CASERIO L RICHMAN 374 DORI/BEASKO, S.C. - ALAVA
CASIMIRA LALAO MIRANDA/GANADERIA CASIMIRA - ASTURIAS
CASTRO BUCKEYE ROSI/GANADERIA CASTRO SEGADE - A CORUÑA
CASTRO INES DUVAL/CASA CASTRO, S.C. - A CORUÑA
CASTRO TRIANA MADAGASCAR/CASA CASTRO, S.C. - A CORUÑA
CASTRO XACOBEO LOCA/GANADERIA CASTRO SEGADE - A CORUÑA
CATALINA/GANADERIA ZAMON - A CORUÑA
CELEDONIO DUPLEX BAMBI/CASA CELEDONIO - ASTURIAS
CERCADO 327/S.A.T. EL CERCADO Nº39146 - CANTABRIA
CERCAO 193/S.A.T. EL CERCADO Nº39146 - CANTABRIA
CHACA 1061 DELAROSA/CHACA OTUR SDAD.COOP. - ASTURIAS
CHAO 7206 AIRRAID/CHAO MEZONZO S.A.T. 1189 XUGA - A CORUÑA
CHAO 7773 BUCKEYE/CHAO MEZONZO S.A.T. 1189 XUGA - A CORUÑA
CHESTERA LOGO/LA PASIEGA - CANTABRIA
CHINELO XACOBEO 7077/CHINELO, C.B. - LUGO
CHOUSA BUCKEYE AVENA/GANADERIA A CHOUSA, S.L. - LUGO
CHRIS ESTEFANIA MISCHIEF/GRANJA SALVADOR - ASTURIAS
CHUSCO SC LAUTHORITY XACOBA/CHUSCO, S.C. - LUGO
CID BRANDY AVERIA/GANDEIRIA CID, S.C. - LUGO
CID MEGAROY MEGALASTRA/GANDEIRIA CID, S.C. - LUGO
CID PAGEWIRE MARCHENA/GANDEIRIA CID, S.C. - LUGO
CID XUBILEO XARA/GANDEIRIA CID, S.C. - LUGO
CIUCENDE DANCER/AGROCIOCENDE, S.C. - A CORUÑA
CIUCENDE EMIR 2170/AGROCIOCENDE, S.C. - A CORUÑA
CIUCENDE XACOBEO 9874/AGROCIOCENDE, S.C. - A CORUÑA
CLARA GOLDWYN IRINIA/CASA CLARA - ASTURIAS
CLARA TOYSTORY GINA/CASA CLARA - ASTURIAS
CLAVELINA BECKAN/ANGEL GONZALEZ TRUEBA - CANTABRIA
COLLADA BOLTON CLARA/COLLADA, S.C. - ASTURIAS
COLLADA DUPLEX CORZA/COLLADA, S.C. - ASTURIAS
COLLADA GOLDWYN DESI/COLLADA, S.C. - ASTURIAS
COLLADA GOLDWYN RICA/COLLADA, S.C. - ASTURIAS
CONEJA TOJO/ANGEL GONZALEZ TRUEBA - CANTABRIA
COROMINES ALLEN STELA/S.A.T. Nº 708 CAN POL - GIRONA
CORU COMPLEX MILAGROS/CORU - ASTURIAS
COTILAN CAMOUFLAGE MELOSA/CASA COTILAN - ASTURIAS
COTILAN TALENT ASUNCION/CASA COTILAN - ASTURIAS
COTO SANCHEZ ADRIANA/CASA COTO - ASTURIAS
COVA NEGRA/GANADERIA COVA - A CORUÑA
CTGD TEIVILIDE XACOBEO 3072/GONZALEZ - PONTEVEDRA
CUESTA FERGOR FEVER/CUESTA VEGA - CANTABRIA
CUESTA VENENO SID/CUESTA VEGA - CANTABRIA
CURISCADA BOLIVIA MUIÑEIRA/CURISCADA - A CORUÑA
D.R. ALAIS DUPLEX/S.A.T. DIEGO RUIZ - CANTABRIA
DA FONTE BOLTON DIANA/CASA DA FONTE - LUGO
DAVID ESC LAUTHORIT/DAVID ESKUZA ARBAIZA - ALAVA
DE WINKELS KOBA 68/GANAD. CARRO - A CORUÑA
DEL LLANO BRISA BLADE/EL LLANO, S.C. - CANTABRIA
DEL LLANO CAPERUCITA ROJA/EL LLANO, S.C. - CANTABRIA
DELI/EL VENTORRILLO - CANTABRIA
DIESTRO SHOTTLE NEVADA/EL DIESTRO - ASTURIAS
DIPSY/GANADERIA PEREZ IGLESIAS,S.C. - ASTURIAS
DORA DEL URO/PEÑA DEL URO - CANTABRIA
DORADO 3272/CASA VEGA - ASTURIAS
DORVISOU DUPLEX LINDA/DORVISOU - PONTEVEDRA
EBENE 18/FINCA RAPOSO, S.C. - A CORUÑA
ECUME 32/GANADERIA CASA BRAULIO, S.C. - ASTURIAS
EDESA ARIADNA AMERICA/GRANJA LA FUENTE, S.C. - CANTABRIA
EL CRUCE DAMION GEMA/S.A.T. EL CRUCE - CANTABRIA
EL CRUCE JERRICK ROSALIA/S.A.T. EL CRUCE - CANTABRIA
EL CRUCE LAUTHORITY ELISENDA/S.A.T. EL CRUCE - CANTABRIA
EL CRUCE SID AMAYA/S.A.T. EL CRUCE - CANTABRIA
EL CRUCE SPIRTE NOA/HERBARFER - VIZCAYA
EL MERACHO XACOBEO BONITA/SARABIA - CANTABRIA
EL POL BUCKEYE ADELA/FERCA, S.C. - CANTABRIA
EL SOLAR CANDIDA SID/NURIA.H - VIZCAYA
EL.CAMPO KNOWLEDGE MINDY/EL CAMPO - VIZCAYA
EL.HAYA ONTARIO CAMELA/EL HAYA MATIENZO, C.B. - VIZCAYA
ELOY ROY MARAGOTA/GANADERIA ELOY, S.C. - ASTURIAS
ENCIMA EL RIU ELIA ROY/ENCINA EL RIU - CANTABRIA
ENRIQUE WONDER FANTA/EXP.GAN.CASA ENRIQUE, C.B. - ASTURIAS
EPHEMERE 3756/GANADERIA PABLO, S.C. - ASTURIAS
EPUISANTE DE FRANLIEU/S.A.T. ARRONTE N.8434 - CANTABRIA
ESCAROLO LUCI SAMUELO/CASA ESCAROLO - ASTURIAS
ESCAROLO RUFA POWER/CASA ESCAROLO - ASTURIAS
ESCAROLO SEVILLINA BUILDER/CASA ESCAROLO - ASTURIAS
ESPINO LUZ DELETE/GANADERIA EL ESPINO, S.C. - CANTABRIA
ESPINO SABINA ERNESTO ET/GANADERIA EL ESPINO, S.C. - CANTABRIA
ESPUMA/FLORA - ASTURIAS
ESTAKUA LHEROS PILI/ESTAKUA - VIZCAYA
ESTEBAN BUCKEYE CRICIUMA/CASA ESTEBAN - ASTURIAS
ESTEBAN DUPLEX YVETT/CASA ESTEBAN - ASTURIAS
ETXEBERRI DUPLEX LORETAN/ETXEBERRI BASERRIA - GUIPUZCOA
F.CASABLANCA 1352 ASHTRO/GANADERIA MANOLERO - ASTURIAS
F.M. 1447 XACOBEO 6910/S.A.T. FAMILIA MARTINEZ - A CORUÑA
F.RAPOSO BOLTON AMADA 332/FINCA RAPOSO, S.C. - A CORUÑA
FABIA/LA TEJA - CANTABRIA
FACIO FEVER AFRODISIACA/GANAD. FACIO HOLSTEIN - ASTURIAS
FACIO TALENT PUB/GANAD. FACIO HOLSTEIN - ASTURIAS
FACIO XACOBEO AMANECER/GANAD. FACIO HOLSTEIN - ASTURIAS
FANSIN ROMEO PETRA/CASA FANSIN - ASTURIAS
FARRIN STEADY JEJU/CASA FARRIN, S.C. - ASTURIAS
FASTOCHE/S.A.T. ISIDRO - A CORUÑA
FDEZ. SABRINA/FERNANDEZ GUTIERREZ, S.C. - CANTABRIA
FELE BAROQUE LILY/GANADERIA FELE, S.C. - ASTURIAS
FELE SPIRTE PILA/GANADERIA FELE, S.C. - ASTURIAS
FELE STEADY ROSI/GANADERIA FELE, S.C. - ASTURIAS
FELINE/S.A.T. Nº 708 CAN POL - GIRONA
FENNIE 31/LA JELGUERA, S.C. - ASTURIAS
FERNANDEZ 627 BRONCO/GANAD. FERNANDEZ SANCHEZ - A CORUÑA
FERREIRO DELAROSA IRENE/CASA FERREIRO, S.C. - ASTURIAS
FERREIRO GOLDWYN CARLA/CASA FERREIRO, S.C. - ASTURIAS
FERREIRO KERBY NAOMI/EL FERREIRO - ASTURIAS
FERRERU LISTA ALEXANDER/GANADERIA FERRERU, S.C. - ASTURIAS
FERRERU PALERMO CUBANA/CASA EL FERRERU - ASTURIAS
FERRERU SHIMMER PRINCESA/CASA EL FERRERU - ASTURIAS
FERRETTE/S.A.T. AGRIC.JUNQUERA COLMEIRO, S.C. - PONTEVEDRA
FISURE.CB GOLDWYN LLAMA/FISURE PORTILLO, C.B. - VIZCAYA
FISURE.CB TIMBER VAINILLA/FISURE PORTILLO, C.B. - VIZCAYA
FISURE.CB TRIBUTE NONO/NURIA.H - VIZCAYA
FLORA GOSPELL MANITOBA ET/CASA FLORA. SDAD.CIVIL - ASTURIAS
FONTELAS SHOTTLE 964/S.A.T. XUGA 747 FONTELAS - A CORUÑA
FONTELAS TOYSTORY 538/S.A.T. XUGA 747 FONTELAS - A CORUÑA
FRADE SANCHEZ RITA ET/GANADERIA FRADE,S.C. - PONTEVEDRA
FRAMBOISE/EL OTURIELLO, S.L. - ASTURIAS
FRISETTE/GANDEIRIA CID, S.C. - LUGO
FUIN CAMOUFLAGE SIRIA/CASA EL FUIN - ASTURIAS
G 1801/S.A.T. N 39001 CUATROVIENTOS - CANTABRIA
GACYLIA/GANADERIA PARLERO, S.C. - ASTURIAS
GALEZE/GANADERIA MADANELO S.A.T. 1063 - LUGO
GALLEGA/LA TEJA - CANTABRIA
GALLO ALINO LETIZIA/EL GALLO,S.C. - ASTURIAS
GARDIENNE/S.A.T. N 39001 CUATROVIENTOS - CANTABRIA
GAYERE ALLIANCE JORDAN/GAYERE C.B. - ASTURIAS
GAYERE GOLDWYN SID 160/GAYERE C.B. - ASTURIAS
GAYERE LOYOLA GOLDWYN MILLION/GAYERE C.B. - ASTURIAS
GAYERE LUZ IRON HAMILTON 979/SAMASILVA - ASTURIAS
GAYERE MARI SANCHEZ/LLARRIBA, S.C. - ASTURIAS
GAYERE S. BUCKEYE WONDER 167/SAMASILVA - ASTURIAS
GAYERE T. MORTY T. ALEGRIA/GAYERE C.B. - ASTURIAS
GAYERE TERESA SPIRTE MR BURNS/SAMASILVA - ASTURIAS
GENER BLEDA SHERIF 1026/MAS GENER S.C.P. - GIRONA
GENER MEGA ZEMINIA 906/MAS GENER S.C.P. - GIRONA
GENER STAR SHANA 1057/MAS GENER S.C.P. - GIRONA
GIBORE DE HAGBENDEN/GRANJA JADO - CANTABRIA
GIL SPIRTE TANIA/S.A.T. CRUZ LEZAMA - CANTABRIA
GLEZ. AGATA/S.A.T. GONZALEZ 39082 - CANTABRIA
GRANDE PRISA BOLTON PECA/S.A.T. GRANDE - LUGO
GUIMAUVE/S.A.T. GANADERIA VILA DE SANTAIA - A CORUÑA
H. GOLDWYN LOLY II/S.A.T. LAS HABAS 39150 - CANTABRIA
HERBARFER KNOWLEDGE LOREA/HERBARFER - VIZCAYA
HERBARFER STARTIT PARDA/HERBARFER - VIZCAYA
HERVICAM DORA/S.A.T. HERVICAM - CANTABRIA
HERVICAM LESLY MARQUIS/S.A.T. HERVICAM - CANTABRIA
HEVAG/S.A.T. GANADERIA VILA DE SANTAIA - A CORUÑA
HEYNCKES DE HAGBENDEN/GRANJA JADO - CANTABRIA
IAGO DANCER LUPE/CASIMIRO-ASOREI, S.C. - PONTEVEDRA
IGLESIAS BELLA JOY/IGLESIAS - ASTURIAS
IGLESIAS LUCI SIMMS/IGLESIAS - ASTURIAS
IGLESIAS NOEMI SEPTEMBER/IGLESIAS - ASTURIAS
IGLESIAS RONDA DISPLAY/IGLESIAS - ASTURIAS
IGNACIO MEGAROY NEVADA/CASA IGNACIO - ASTURIAS
ISABEL LUSTY MARINA/GANADERIA ISABEL - ASTURIAS
JACINTO SANCHEZ LELY/HJOS.DE JACINTO GUTIERREZ - ASTURIAS
JADO GABRIELA SPIRTE/GRANJA JADO - CANTABRIA
JOFRAN 0061 ROUKI/S.A.T. ZORRILLA - CANTABRIA
JOFRAN 0065 BOLTON/S.A.T. ZORRILLA - CANTABRIA
JOMAFE SCOOBY-DUU VANESA/S.A.T. JOMAFE - ASTURIAS
JOSE DE CANDIDA MORRISON MORA/CASA JOSE DE CANDIDA - LUGO
JOSE DE CANDIDA XACOBEO PEREGR/CASA JOSE DE CANDIDA - LUGO
JUANA CHAMPION CARLA/CASA JUANA - ASTURIAS
KASSANDRA/CASA COLAO - ASTURIAS
KATARAN S TALENT 385 TALEN/KATARAN, S.C. - ALAVA
KATJA/ANSO, S.C. - CANTABRIA
KILO AMARO ROSANA/CASA PEPE KILO - ASTURIAS
KILO JORDAN TATIANA/CASA PEPE KILO - ASTURIAS
L. CHIRLA ADAM/LAZA FERNANDEZ S.C. - CANTABRIA
L. PARAMOUNT 6685/S.A.T. EL COTERON - CANTABRIA
LA BARCA SULLY MAKOKE/LA BARCA, S.C. - ASTURIAS
LA CABAÑA TUNA BUCKEYE/GRANJA LA CABAÑA, S.C. - CANTABRIA
LA CALEONA BONAIR BOMBON/LA CALEONA, S.C. - ASTURIAS
LA CALEONA WONDER BAILARINA/LA CALEONA, S.C. - ASTURIAS
LA CORONA KNOWLEDGE 4902/GANADERIA LA CORONA - ASTURIAS
LA CORONA 4804 ALINO/GANADERIA LA CORONA, SL - ASTURIAS
LA CORONA 4828 DENZEL/GANADERIA LA CORONA, SL - ASTURIAS
LA COZ YULY WINDBROOK/LA COZ, S.C. - CANTABRIA
LA ESTRADA KIKA SHOTTLE/GANADERIA RAMON LUIS, C.B - ASTURIAS
LA FIGAR LINDO MAREA/LA FIGAR, S.C. - ASTURIAS
LA FLOR JORDAN ENGRACIA/LA FLOR - CANTABRIA
LA FLOR NOIBE GOLDWYN/LA FLOR - CANTABRIA
LA FLOR SPIRTE NAGASAQUI/LA FLOR - CANTABRIA
LA PIEDRA TAMARGO VANESA/MENENDEZ - ASTURIAS
LA RIVA 0435 DUPLEX/LA RIVA - CANTABRIA
LA VEGUINA BOLIVIA BOLIVIANA/LA VEGUINA - ASTURIAS
LABIÑUELA DUPLEX DUNIA/LA BIÑUELA - VIZCAYA
LACTEOS B DUPLEX 5034/LACTEOS BORDATXO,S.L. - GUIPUZCOA
LAISU HOWIE GREBA/LAISU - VIZCAYA
LALO GASTER COMOTU/CASA LALO - ASTURIAS
LALO PILOTO CAMELIA 0466/CASA LALO - ASTURIAS
LANDAKO JORDAN LIBI/LANDAKO - VIZCAYA
LANDAKO KNOWLEDGE IZARRA/LANDAKO - VIZCAYA
LARRASPI LOTTERY 1052/LARRASPI BASERRIA - GUIPUZCOA
LARREA S. DUPLEX BIZKAIA/LARREA S.C. - ALAVA
LARREA SC DUPLEX/LARREA S.C. - ALAVA
LARREA SC TALENT/LARREA S.C. - ALAVA
LAS CRUCES LUCENTE 417/ENRIQUE ROMANO SORDO - ASTURIAS

Las cojeras preocupan cada vez más al ganadero porque condicionan el bienestar animal y reducen el beneficio económico de las ganaderías de vacuno de leche.
Mejorar la salud de las pezuñas se ha hecho necesario para tener animales funcionales y rentables. Por ello, CONAFE ha visto necesario implementar un programa a nivel nacional para la formación y la recogida de información sobre las patologías que afectan la pezuña para el control y la prevención de las cojeras en las ganaderías de vacuno de leche llamado I-SAP. Dentro del marco de I-SAP y en estrecha colaboración con SERAGRO y la Facultad de Veterinaria de la Universidad Complutense de Madrid, CONAFE organiza el próximo otoño un curso de podología.
Si te apasiona el mundo de la podología y quieres convertirlo en tu profesión o si eres un ganadero que quiere aprender trucos y conceptos teóricos y prácticos para mejorar la salud podal de sus animales, esta también es tu oportunidad.
En esta edición primera edición, el objetivo del curso es combinar el aprendizaje y la unificación de criterios entre profesionales que se dedican a la podología. Por ello nuestras metas son:
•La unificación de criterios a través de la formación y el reciclaje de los podólogos participantes en la recogida de información de salud podal.
•La introducción a la podología a futuros profesionales de la misma.
•La formación de ganaderos en podología y la familiarización de éstos con el programa I-SAP y la información que éste genera.

LAURELES MODEL LAUTHORITY/GANADERIA EL CLARO,S.C. - ASTURIAS
LEONOR LOTTO INTEGRITY/GANADERIA MANOLERO - ASTURIAS
LES PANDIELLES ELISA TITANIC/LES PENDIELLES - ASTURIAS
LINA SHOTTLE MACIÑEIRA/LINA - LUGO
LLAMAS BUCKEYE MOU/GANADERIA LAS LLAMAS, S.C. - ASTURIAS
LLARRIBA ALADIN LUCY/LLARRIBA, S.C. - ASTURIAS
LLARRIBA SANCHEZ BRISA/LLARRIBA, S.C. - ASTURIAS
LLONGUERA BAXTER FABULA/S.A.T. LA LLONGUERA - ASTURIAS
LLONGUERA VERDICIO NOEMI/S.A.T. LA LLONGUERA - ASTURIAS
LLONGUERA VOLCAN CRISTAL/S.A.T. LA LLONGUERA - ASTURIAS
LLUISA DOLMAN DOLMAN/S.A.T. LLUISA - ASTURIAS
LORENA 6301 NEVOR/GANADERIA LORENA, S.C. - ASTURIAS
LORENZO SANCHEZ RHIANNA/CASA LORENZO,S.C. - ASTURIAS
LOS CURTOS FARALA/LOS CURTOS, S.C. - CANTABRIA
LOS CURTOS SIRA/LOS CURTOS, S.C. - CANTABRIA
LOUREIROS BRANZA TOYSTORY/RIAL DE LOUREIROS - A CORUÑA
LOUREIROS TRIANA XACOBEO/RIAL DE LOUREIROS - A CORUÑA
LUCARIA DAMION CASTA/CASA LUCARIA - ASTURIAS
LUCARIA FEVER FLORIDA/CASA LUCARIA - ASTURIAS
LUCARIA FEVER JACINTA/CASA LUCARIA - ASTURIAS
LUCARIA JORDAN MIRANDA/CASA LUCARIA - ASTURIAS
LUCARIA JORDAN POLAR/CASA LUCARIA - ASTURIAS
LUCARIA LAUTHORITY LUISA/CASA LUCARIA - ASTURIAS
LUCARIA SID PILAR/CASA LUCARIA - ASTURIAS
LUCES ATENAS KARO/I.E.S. DE LUCES - ASTURIAS
LUCHO NICOL SERENA/LUCHO, S.C. - ASTURIAS
LUIS BOLTON GALILEA/CASA LUIS - ASTURIAS
LUIS SANCHEZ CASILDA/CASA LUIS - ASTURIAS
LUNA DANCER VANESA 9670/LUNA - LUGO
M.R. DEVA BLITZ/EL MOLINO DE RUEDAS - CANTABRIA
M.R. WISCONSIN LOU/EL MOLINO DE RUEDAS - CANTABRIA
MAESTRO SALOME MERCHANT/EL MAESTRO, S.C. - ASTURIAS
MANDEO 121 SOLANA BOLTON/MANDEO, S.C. - A CORUÑA
MANOLON MASAI TERRY/CASA MANOLON, S.C. - ASTURIAS
MANTEIGA XACOBEO PIRATA/GANA. MANTEIGA - PONTEVEDRA
MARCELINO XANA XACOBEO/MARCELINO, S.C. - ASTURIAS
MARCELO AMANDA ALEXANDER/MARCELO SEBRAN,S.C. - ASTURIAS
MARCELO DEJA VU DUPLEX/MARCELO SEBRAN,S.C. - ASTURIAS
MARCELO SELENE SANCHEZ/MARCELO SEBRAN,S.C. - ASTURIAS
MARCELO XANA XACOBEO/MARCELO SEBRAN,S.C. - ASTURIAS
MARGARITA VERDICIO VERDI/MARGARITA - ASTURIAS
MARIBEL GRAND NEGRITA/MARIBEL - VIZCAYA
MARQUES SCOOBY-DUU ARIELA/MARQUES, S.C. - ASTURIAS
MARQUES STEADY TANIA/MARQUES, S.C. - ASTURIAS
MATIAS BONAIR JUSTY/LA PIENDA, S.C. - ASTURIAS
MATIAS BUCKEYE GYPSY/LA PIENDA, S.C. - ASTURIAS
MATIAS DENZEL GOLDA/GANADERIA MATIAS, S.C. - ASTURIAS
MAXIMILIANO ROMEO LUCIA/MAXIMILIANO - ASTURIAS
MENENDEZ CAMPEONA ARMSTRONG/CASA MENENDEZ - ASTURIAS
MENENDEZ DORA DOLMAN/CASA MENENDEZ, S.C. - ASTURIAS
MERGULLAN XACOBEO NAR-XOSE/NAR-XOSE S. C. GALEGA - LUGO
MEYRAZO DICTATOR CANDELA/CASA EL MEYRAZO - ASTURIAS
MINAS SIERRA BONAIR/LAS MINAS, S.C. - CANTABRIA
MINGO BUCKEYE SULTANA/CASA LEONARDO,S.C. - ASTURIAS
MINGO FEVER MAR/CASA MINGO, S.C. - ASTURIAS
MINGO STEADY MILA/CASA MINGO, S.C. - ASTURIAS
MINGON DORTI BELESAR/GANADERIA MINGON, S.COOP. - ASTURIAS
MINGON TALENT MOLINA/GANADERIA MINGON, S.COOP. - ASTURIAS
MIRANDA ELECTION MARINA/GANADERIA BOBES, S.C. - ASTURIAS
MOLINO RUEDAS MERKEL BLITZ/S.A.T. BERNALLAN N.9127 - CANTABRIA
MONA CASUSO/LAVIN - CANTABRIA
MONASTERIO BOLTON NUBE/SC GANADERIA MONASTERIO - LUGO
MONTE LAUTHORITY ORTAL/SAN CIPRIANO, S.C. - CANTABRIA
MONTE LONGTIME NUBE/SAN CIPRIANO, S.C. - CANTABRIA
MORAL WONDER HELENA/CASA MORAL - ASTURIAS
MORENO OBAMA 82/MORENO - LUGO
NAVEDAS CORZA SORDA/LAS NAVEDAS - CANTABRIA
NAVEDAS HOWIE LEBANIEGA/LAS NAVEDAS - CANTABRIA
NAVEDAS JILGUERA BLADE/LAS NAVEDAS - CANTABRIA
NEVARES ESPIN MALENA/CASA NEVARES - ASTURIAS
NIEVES/ENCINA EL RIU - CANTABRIA
NORINO SCOOBY-DUU RALUKA/GANADERIA ALBAUR,S.C. - ASTURIAS
NORINO STARTIT TIRSA/GANADERIA ALBAUR,S.C. - ASTURIAS
NOVALES A BURTON/NOVALES ALDAY, S.C. - ALAVA
NOZALIN ALEGRIA ATWOOD/NOZALIN - ASTURIAS
NOZALIN JARA SANCHEZ/NOZALIN - ASTURIAS
NOZALIN SERENA SANCHEZ/NOZALIN - ASTURIAS
NOZALIN XISCA SHOTTLE/NOZALIN - ASTURIAS
OLAZABAL EMIR 2268/OLAZABAL BASERRIA - GUIPUZCOA
OLGA GOLWYN/S.A.T. SAINZ AJA - CANTABRIA
ONDARTZA DENZEL 3781/ONDARTZA BITARTE SC - GUIPUZCOA
ONDARTZA DENZEL 3971/ONDARTZA BITARTE SC - GUIPUZCOA
ONDARTZA KNOWLEDGE 4729/ONDARTZA BITARTE SC - GUIPUZCOA
ONDARTZA LAURIN 4534/ONDARTZA BITARTE SC - GUIPUZCOA
ONDARTZA ONTARIO 4125/ONDARTZA BITARTE SC - GUIPUZCOA
ONDAZARTE GOSPEL 844/ONDAZARTE GAIN,S.L. - GUIPUZCOA
ONDAZARTE KNOWLEDGE LAIA/ONDAZARTE GAIN,S.L. - GUIPUZCOA
ONDAZARTE TEE OFF BRIGADA/ONDAZARTE GAIN,S.L. - GUIPUZCOA
OS AMERICANOS SANCHEZ 399 ET/OS AMERICANOS - PONTEVEDRA
OUTEIRO BERRYHILL KALINA/GANDERIA SINESIO, S.C. - A CORUÑA
OUTEIRO KINGLY TELMA/OUTEIRO,S.C. - LUGO
PABLO ALADINO KIRA/GANADERIA PABLO, S.C. - ASTURIAS
PABLO EXTREME 9507/GANADERIA PABLO, S.C. - ASTURIAS
PACHIN XACOBEO ZULEMA/PACHIN, S.C. - ASTURIAS
PACHO DUPLEX SILVA/CASA DE PACHO - ASTURIAS
PACHO ELECTION BRISA/CASA DE PACHO - ASTURIAS
PACHO KAMPMAN SOTAVENTO/CASA DE PACHO - ASTURIAS
PACHO TOLA LHEROS/CASA BENIGNO, S.C. - ASTURIAS
PACHO TOYSTORY TELVA/CASA DE PACHO - ASTURIAS
PACHON CHIQUITA RUDOLPH/PACHON - ASTURIAS
PACHON STORMATIC BRUNA/TAHOCES, S.C. - ASTURIAS
PANADERO TULA MICHINES/LA PARAYA, S.C. - CANTABRIA
PASTORA/EL AGUERO,S.C. - ASTURIAS
PATRON BEHOBIA SILVIA/CASA PATRON, S.C. - ASTURIAS
PATTY JORDAN/SARABIA - CANTABRIA
PB DONAKAREN SHOTTLE/PORTELO-BARBAS,S.C. - LUGO
PB MARTA SANCHEZ 8321/PORTELO-BARBAS,S.C. - LUGO
PB NASSA EXTRA ET/PORTELO-BARBAS,S.C. - LUGO
PEDREGAL WINNERS ROSS/EL PEDREGAL, S.C. - ASTURIAS
PEDREIRA 2455/GANADERIA TILLEIRA,S.C. - A CORUÑA
PELAMBRE CELWIN WINDBROOK/EL PELAMBRE, S.C. - CANTABRIA
PELAMBRE LITA XACOBEO/EL PELAMBRE, S.C. - CANTABRIA
PELAMBRE SETY DENZEL/EL PELAMBRE, S.C. - CANTABRIA
PENEDO OCA TALENT/FINCA MARISA - A CORUÑA
PEREJIL PANZABRUTA/GRANJA PEREJIL "EL MACHO" - CANTABRIA
PEREZ PETA TOJO/HNOS. GUTIERREZ MADRAZO, S.C. - CANTABRIA
PERRITO TALENT PEONZA/S.A.T. GANADERIA PERRITO - ASTURIAS
PETON JASPER CASPER/NAR-XOSE S.C. GALEGA - LUGO
PINTADO WINDBROOK XANA/CASA PINTADO - ASTURIAS
PITERA AMSTERDAN DALLAS/LA PITERA - CANTABRIA
PITERA RUMBA WINDBROOK ET/LA PITERA - CANTABRIA
POLICARPIO BERLINA BUCKEYE/POLICARPIO, S.C. - ASTURIAS
POLO CID FLORA/CASA DE POLO, S.C. - LUGO
POLO PEDREIRO CORAL/CASA DE POLO, S.C. - LUGO
PORCILO ANGY SID ET/GANADERIA PORCILO, S.C. - ASTURIAS
PORCILO DOLORES LAUTHORITY/GANADERIA PORCILO, S.C. - ASTURIAS
PORCILO KAREN LAKOTA/GANADERIA PORCILO, S.C. - ASTURIAS
PORCILO RUFA SID/GANADERIA PORCILO, S.C. - ASTURIAS
POSADA LOMAX CANDELARIA/CASA POSADA - ASTURIAS
POYU.SC GABOR PETRA/POIU BASERRIA, S.C. - VIZCAYA
POYU.SC SANCHEZ LURDES/POIU BASERRIA, S.C. - VIZCAYA
POYU.SC SID BUYA/POIU BASERRIA, S.C. - VIZCAYA
PUENTE AMAZING JUNCAL/GANADERIA PUENTE, S.C. - ASTURIAS
PUENTE GABOR BALSA/GANADERIA PUENTE, S.C. - ASTURIAS
PUENTE KINGLY ARIETA/GANADERIA PUENTE, S.C. - ASTURIAS
PUENTE RUSH PRECIOSA/GANADERIA PUENTE, S.C. - ASTURIAS
PUERMA MCAIN MUÑECA/PUERMA - ASTURIAS
QUEIPO LIN MACARENA/QUEIPO - ASTURIAS
QUEVEDO LONGITUDE KORA/GANADERIA QUEVEDO, S.C. - ASTURIAS
QUINTANA LOCA 651 DENZEL/QUINTANA, S.C. - CANTABRIA
QUINTANA MERIN 636 BUCKEYE/S.A.T. QUINTANA N. 7259 - CANTABRIA
R. DOROTEA ROY/LA REDONDA - CANTABRIA
R/L. ALADIN MARILO/GANADERIA RAMON LUIS, C.B - ASTURIAS
RASILLO BERTIL 6706/GANADERIA RASILLO, S.L. - CANTABRIA
REBUSTIANO TEE OFF FURIA/CASA ROBUSTIANO - ASTURIAS
REDONDA GISELA SID/S.A.T. LA REDONDA - CANTABRIA
REDONDA TIJUANA BLITZ/S.A.T. LA REDONDA - CANTABRIA
REGUEIRO ASHGOLD GALLARDA/G.MENDEZ MURIAS,S.C. - ASTURIAS
REGUEIRO 170 LUCUS/SALMONTE - A CORUÑA
REGUEIRON PALMIRA OSBOUM/REGUEIRON - ASTURIAS
REGUERA ALINO MARILIN/CASA REGUERA - ASTURIAS
REGUERA ROUKI LUNA/CASA REGUERA - ASTURIAS
REI INCOME 4213/GANADERIA REY, S.C. - LUGO
RETO MANA PALERMO/RETO A LA ESPERANZA - CANTABRIA
REYES/GANAD. BARDASQUERA - ASTURIAS
RIBATXENT DOLMAN BERRI/RIBATXENTA S.L. - ALAVA
RICARDO CHICAGO CONEJA/LA CASA - CANTABRIA
RICARDO DUQUESA CHICAGO/LA CASA - CANTABRIA
RICARDO G EMIR/RICARDO GARCIA DE CORTAZAR - ALAVA
RIGUEIRO MADAGASCAR VIRUTA/LINA - LUGO
ROC VELVET 8488/GANADERIA LA PEDROSA - ASTURIAS
ROCA EUREKA SHOUT/S.A.T. Nº 708 CAN POL - GIRONA
RODACO NICOL NICA/CASA RODACO - ASTURIAS
RODACO VALDES VALDESA/CASA RODACO - ASTURIAS
RODRIGUEZ LUSTY ASTURIANA/ANGEL RODRIGUEZ DIAZ - ASTURIAS
ROMO WONDER PAMELA/GANADERIA EL ROMO, S.C. - ASTURIAS
ROQUE CRICKET SAMBA/GANADERIA CASA CURUSIA, S.C. - ASTURIAS
ROQUE ROY KATY/CASA ROQUE - ASTURIAS
ROSALINO SABLON RITA/CASA ROSALINO - ASTURIAS
ROYA HANNA BUCKEYE/FINCA ROYA, S.C. - CANTABRIA
S. RESTHA 5288/SAN EMETERIO GARABIETA, S.C. - CANTABRIA
SAN CRISTOBAL CRISTINA XACOBEO/SAN CRISTOBO - A CORUÑA 88 Frisona Española 208

SAN CRISTOBAL MARIA XACOBEO/SAN CRISTOBO - A CORUÑA
SAN PEDRO PIANTA/ALBITA CALLEJA - VIZCAYA
SAN PEDRO TAMBO AYMAR/SAN PEDRO - ASTURIAS
SAN XULIAN 2786 ASHERS/S.A.T. SAN JULIAN - A CORUÑA
SAN XULIAN 2792 JORDAN/S.A.T. SAN JULIAN - A CORUÑA
SAN XULIAN 6386 SHOTTLE/S.A.T. SAN JULIAN - A CORUÑA
SANCHEZ E JORDAN/SANCHEZ E HIJOS, S.C. - ALAVA
SANTOS DAXTER ALEXIA/CASA SANTOS - ASTURIAS
SARABIA MONICA SPIRTE/SARABIA - CANTABRIA
SARABIA NATACHA OREGON/SARABIA - CANTABRIA
SARABIA SARAZAN DAMION/SARABIA - CANTABRIA
SC CHUSCO BOLIVIA BAMBI/CHUSCO, S.C. - LUGO
SC CHUSCO BOLIVIA REINA/CHUSCO, S.C. - LUGO
SEOANE JORDAN PEDREIRA 276/GANDEIRIA SEOANE,S C. - A CORUÑA
SERGIO LAURIN LAURA/CASA DE SERGIO - LUGO
SERJA PILAR MERCHANT/S.A.T. SERJA Nº 39018 - CANTABRIA
SHOTTLE CAMPANILLA 2/GRANJA MOLINO - CANTABRIA
SIERRA FRIDA KETCHUP/LA SIERRA - CANTABRIA
SIMON GOMEZ UNQUERA/SIMON - ASTURIAS
SIRGO DICTATOR BRAVA/SIRGO, S.C. - ASTURIAS
SISO XACOBEO 8046/MADRIÑAN - PONTEVEDRA
SOMOBOO CAPITANA KNOWLEDGE/SOMOBOO - CANTABRIA
SOTO MALU ANDABAO/SOTO - ASTURIAS
SPIRTE 3789/REVUELTA ORTIZ,S.C. - CANTABRIA
STA ANA FARRUCA/GANADERIA SANTA ANA, S.C. - CANTABRIA
STA ANA PASIEGA AUDI/GANADERIA SANTA ANA, S.C. - CANTABRIA
STA ANA SAMBA SALSA/GANADERIA SANTA ANA, S.C. - CANTABRIA
TEC ARTIME SHOTTLE LIZ ET/ARTIME, S.C. - ASTURIAS
TEZANILLOS SID NOCICA/S.A.T. TEZANILLOS - CANTABRIA
TEZANILLOS SPIRTE NOVA/S.A.T. TEZANILLOS - CANTABRIA
TEZANILLOS WINDBROOK LUZ/S.A.T. TEZANILLOS - CANTABRIA
TINA/GANADERIA RAMON LUIS, C.B - ASTURIAS
TOMAS ROSADA SID/CAL TOMAS - GIRONA
TONJOVI RISING LOLA/TONJOVI - ASTURIAS
TONJOVI SHIMMER PANTOJA/TONJOVI - ASTURIAS
TONJOVI SPECTRUM LEONA/TONJOVI - ASTURIAS
TONJOVI SPECTRUM TAMARA/TONJOVI - ASTURIAS
TORRE BOLIVIA MIGUELINA/GANADERIA LA TORRE - CANTABRIA
TRAVESIA FEVER MELY/GANADERIA PARLERO, S.C. - ASTURIAS
TRESPANDIO PHOENIX MARINERA/CASA LORENZO,S.C. - ASTURIAS
UGASMA MILLION 7544/UGASMA - A CORUÑA
URBASA COMA ROY FANTA/URBASA S.A.T. - ASTURIAS
URBASA PLAYER AMARGA/URBASA S.A.T. - ASTURIAS
URBASA WINDBROOK CAPA/URBASA S.A.T. - ASTURIAS
UZQUIANO- SANCHEZ UZKIANO 3/ZALDUBITXI S.C. PEQUEÑA - ALAVA
VAGA GOLOSA/A VALGA, S.C. - A CORUÑA
VALGA ALBA HORACIO/A VALGA, S.C. - A CORUÑA
VALIENTE ALINO PANTOJA/CASA VALIENTE, S.C. - ASTURIAS
VALIENTE JORDAN CARPA/MOLINERO - ASTURIAS
VALIENTE LAKOTA BRITANIC/VALIENTE - ASTURIAS
VALIOSA HARRY 1ª/GONZALEZ CANO, S.C. - CANTABRIA
VALLE DODY MARAVILLA/CASA DEL VALLE - ASTURIAS
VALLE ROMEO LAIKA/GANADERIA VALLE, S.C. - ASTURIAS
VEGA MODEST SORIA/GANDERIA SINESIO, S.C. - A CORUÑA
VEGA PRIDE AIDA/CASA VEGA - ASTURIAS
VEIGA AMBER ALBA/S.A.T. VEIGA - ASTURIAS
VEIGA LAUTHORITY MORENA/CASA LA VEIGA, S.C. - ASTURIAS
VEIGUEIRO LOFFICIEL RENATA/VEIGUEIRO S.C. GALEGA - LUGO
VEIGUEIRO XACOBEO MURCIANA/VEIGUEIRO S.C. GALEGA - LUGO
VENTA TOYOTA DURABLE/S.A.T. VALLEJA-EL AGUA - CANTABRIA
VENTURA CARISMA NUR/GANADERIA VENTURA, S.C. - ASTURIAS
VENTURA TARTARE ANIA/GANADERIA VENTURA, S.C. - ASTURIAS
VENTURA TARTARE VANESA/GANADERIA VENTURA, S.C. - ASTURIAS
VENTURO DAMION ROSABELLA ET/CASA VENTURO - ASTURIAS
VH PILAR 6440/S.A.T. FINCA EL PILAR 868 XUGA - A CORUÑA
VIÑA SEPTEMBER ISABELA/CASA VIÑA, S.C. - ASTURIAS
VIÑES LLABRES JYNA/GANADERIA VIÑES - ASTURIAS
VIÑES SID TOÑI/GANADERIA VIÑES - ASTURIAS VIÑES
VICENTE NAVIGATOR LLUVIA/CASA VICENTE, S.C. - ASTURIAS
VICENTE USONET FIN BELEN/CASA VICENTE, S.C. - ASTURIAS
VILA XACOBEO ALBITA 5990/GANDERIA SINESIO, S.C. - A CORUÑA
VILA 827 XACOBEO/S.A.T. GANADERIA VILA DE SANTAIA - A CORUÑA
VILAR REXIÑA CID/PEREZ DE VILAR - A CORUÑA
VILARDEVESA 1628/VILARDEVESA, SDAD.COOP.GALEGA - A CORUÑA
VINCULEIRO DANCER DAMA/MOREIRA, S.C. - PONTEVEDRA
VIUDA JORDAN DIANA/EL ALBA, S.C. - ASTURIAS
VIZOSO 3698 PUNTAL/CERNUDA Y VIZOSO,S.C. - ASTURIAS
VOCKA ALEJO/SAN EMETERIO GARABIETA, S.C. - CANTABRIA
XACALEN DE WINDBROOK NETA/XACALEN Y GONZALEZ - ASTURIAS
XACOBO LANDOI LANA/CASA DE XACOBO - A CORUÑA
XEPE GIBSON TRAVIATTA/S.A.T. A CAMPA - A CORUÑA
XIROMO COMPLEX CORA 580/CASA XIROMO - ASTURIAS
XUANFERNAN NOA MAGOT/CASA XUANFERNAN - ASTURIAS
XUANFERNAN RUBI GOLDWYN/CASA XUANFERNAN - ASTURIAS
XUANON GOFAST LAICA/CASA XUANON, S.C. - ASTURIAS
XUANON HAT TRICK MARINERA/CASA XUANON, S.C. - ASTURIAS
XUANON LHEROS CHELA/JOSE LUIS PELAEZ CANO - ASTURIAS
ZAMINA ZURDA 9983/S.A.T. LA ZAMINA - CANTABRIA
ZAPEROS BARCENA CHARITY/GANADERIA ZAPEROS, S.C. - ASTURIAS
ZAPEROS LIN CLAUDIA/GANADERIA ZAPEROS, S.C. - ASTURIAS
ZAPEROS TESSIE DOLMAN MALAX/GANADERIA ZAPEROS - ASTURIAS
ZORRILLA CARMEN TOYSTORY/S.A.T. ZORRILLA - CANTABRIA
ZORRILLA FINLANDESA FINAL CUT/S.A.T. ZORRILLA - CANTABRIA
ZORRILLA MAYALEN BUCKEYE/S.A.T. ZORRILLA - CANTABRIA
0014 PLAZA MAGOT CHISPA/CASA LA PLAZA - ASTURIAS
03373590/CALERA BARON - VIZCAYA
03839779/NURIA.H - VIZCAYA
03950991/BIDARTE BASERRIA - GUIPUZCOA
03951655/BIDARTE BASERRIA - GUIPUZCOA
04113405/BIDARTE BASERRIA - GUIPUZCOA
0730 ALMA/LA PARAYA, S.C. - CANTABRIA
202/EL MOLINERO SERV.AGROP.S.L. - ASTURIAS
2211/COTO DE LOUREDA - A CORUÑA
3043/GANAD. BARDASQUERA - ASTURIAS
3091/GRANJA JADO - CANTABRIA
5227 SPIRTE/S.A.T. VALDEAMIGO - CANTABRIA
5458/S.A.T. BERNALLAN N.9127 - CANTABRIA
5842 POTTER/S.A.T. M.LAVIN-LOREDO - CANTABRIA
6664 L. STORMATIC/S.A.T. M.LAVIN-LOREDO - CANTABRIA
6719 PLAZA SCHUMAKER SHANA/CASA LA PLAZA - ASTURIAS
7305 EMIR LAS BARCENAS/LAS BARCENAS - CANTABRIA
7925/S.A.T. ARRONTE N.8434 - CANTABRIA
8062 DE LA HEUSIERE/GRANJA JADO - CANTABRIA
9000/S.A.T. BERNALLAN N.9127 - CANTABRIA
9064 RAMON/S.A.T. VALDEAMIGO - CANTABRIA
9093/FINCA FERRADAS, S.C. - PONTEVEDRA
9127 ALBA/GANADERIA EL CLARO,S.C. - ASTURIAS
Calendario de Calificación



Septiembre
Lleida, Girona, Barcelona, Ávila, Burgos, Salamanca, Extremadura y Mallorca
Octubre
Girona, Barcelona, Segovia, Palencia, León, Valladolid y Zamora
Resumen de Calificación por tipo 2015. Categorías:


Responde: Rubén Francisco Vázquez* - ANEMBE
Efectivamente, se está hablando mucho de la Fecundación in vitro en los últimos meses y el motivo es evidente: se están obteniendo muy buenos resultados tanto de producción de embriones como de gestaciones obtenidas.
Durante los últimos 50 años, la producción ani-

nivel comercial. Son pocos los países que la están explotando a este nivel. Destaca Brasil, país responsable del 79% de la producción mundial de embriones FIV, unos 350.000 embriones en el año 2013. Le siguen otros países como Colombia, México y Costa Rica, los cuales cuentan con franquicias de laboratorios brasileños y finalmente EE. UU. y Canadá.
En Europa el desarrollo de la técnica es menor, aunque países como Holanda, Alemania, Italia, Francia y España están avanzando de manera importante; en el año 2013 se han producido más de 13.700 embriones FIV. En todos estos países la FIV ha encontrado nichos de desarrollo comercial, logrando despertar el interés de muchos ganaderos.
Pero, ¿en qué consiste la Fecundación in vitro?
La FIV es una técnica por la cual la fecundación de los óvulos por los espermatozoides se realiza fuera del útero de la madre. Estos óvulos se pueden obtener a partir de ovarios procedentes de vacas de matadero, o bien de vacas vivas. En este último caso, los óvulos se obtienen mediante una técnica poco invasiva llamada Aspiración folicular ecoguiada, que consiste en la recuperación de los óvulos mediante la aspiración de folículos presentes en los ovarios de las donantes, atravesando la pared de la vagina con una aguja conectada a un sistema de aspiración. El técnico responsable de realizar la aspiración se ayuda de un ecógrafo para ir visualizando esos folículos.
Esta técnica conocida como OPU (del inglés: Ovum Pick up) combinada con la FIV nos ofrecen el tándem perfecto para maximizar el rendimiento de los animales que queremos multiplicar.
* Veterinario especialista en FIV. Xenética Fontao.
Los óvulos obtenidos, todavía inmaduros, son
transportados en medios específicos hasta un laboratorio. Una vez allí, deben ser madurados durante 24 horas. Pasado este período, los óvulos están preparados para ser fertilizados. Óvulos y espermatozoides se incuban durante otras 20 horas. Superada la etapa de fertilización, los presuntos embriones serán alojados en placas de cultivo con medios específicos durante siete días. Al final del proceso, tenemos embriones listos para transferir en fresco o para congelar.
¿Qué ventajas nos ofrece la Fecundación In vitro de Embriones?
• Producción de un mayor número de embriones por vaca y año: se pueden obtener unos 100 embriones al año por animal.
• Repetitividad: se pueden realizar aspiraciones de cada animal una vez por semana sin comprometer la función productiva ni reproductiva. La destreza y experiencia del técnico de punción son esenciales para el éxito de la técnica. Bajo estas condiciones hay poca probabilidad de producir adherencias u otro tipo de daño.
• Reducción del intervalo generacional. En Xenética Fontao trabajamos con hembras desde los siete meses de edad. Aunque los rendimientos son menores que en animales púberes, para un centro de selección como el nuestro es importante reproducir cuanto antes hembras que genéticamente son interesantes, logrando un alto progreso genético.
• Obtención de embriones sin la necesidad de usar hormonas.
• Posibilidad de reproducir donantes infértiles.
• Obtención de embriones en vacas inseminadas o gestantes (hasta el quinto mes) sin comprometer la función reproductiva.
• Optimización del semen y buenos resultados con semen sexado. Con una pajuela de semen sexado podemos fertilizar óvulos de 6 vacas.
A pesar de sus ventajas, la viabilidad de la FIV se ha visto limitada:
• Una baja tasa de recuperación de óvulos (de 8 a 10 óvulos por donante y por cada sesión) junto con una baja eficiencia en la producción de embriones (3 embriones por sesión).

Embriones FIV listos para transferir
• Variabilidad en los resultados: factores como la edad, estado fisiológico-reproductivo, nutrición, toro, raza, estrés… influyen en el resultado final.
• Técnica compleja con una fuerte inversión en equipamiento y requerimientos de personal especializado.
Es evidente que el progreso genético es un factor clave para mejorar la rentabilidad tanto de las explotaciones de vacuno lechero como de vacuno de carne. La OPU-FIV es una tecnología versátil que nos va a permitir aprovechar aquellos animales que nos ofrecen características interesantes para mejorar la productividad de las explotaciones ganaderas.
La asociación de la OPU-FIV con nuevas tecnologías como el semen sexado y la genómica, nos permiten disponer de las herramientas necesarias para seguir avanzando en la mejora genética y, por lo tanto, mejorar el rendimiento productivo de nuestros animales.
•Menores tasas de gestación (40-50% de preñez) comparadas con las obtenidas por los métodos tradicionales MOET y mayor número de reabsorciones o abortos.


Actualmente las perspectivas son alentadoras, ya son varios los equipos que ofertan la técnica como un servicio comercial, habiendo todavía margen de mejora.
ANEMBE y Frisona Española colaboran en este foro informativo que pretende ser la sección ANEMBE RESPONDE. Aquí tienen cabida las preguntas que normalmente se plantean al veterinario en su actuación cotidiana en el campo.
Aquellos ganaderos interesados en plantear cuestiones, las pueden enviar a la redacción de la revista Frisona Española. Desde aquí se trasmitirán a ANEMBE que las dirigirá a profesionales de prestigio de las diferentes áreas de la clínica y producción bovina y cuyas respuestas se publicarán en estas páginas.

El pasado día 1 de julio entraron en vigor la Ley Orgánica 1/2015, de 30 de marzo, por la que se modifica la Ley Orgánica 10/1995, de 23 de noviembre, del Código Penal, y la Ley Orgánica 2/2015, de 30 de marzo, por la que se modifica la Ley Orgánica 10/1995, de 23 de noviembre, del Código Penal, en materia de delitos de terrorismo. Ambas leyes tienen una importancia significativa en nuestro código legal al modificar más de 250 artículos del Código Penal. A continuación pasaremos a reseñar diez de algunas de las principales modificaciones del texto punitivo tras esta re-

por corrupción. Este nuevo título incluye los artículos 304 bis y 304 ter con los delitos de financiación ilegal de los partidos políticos. Entre dichos delitos se contempla el castigo con multa a las donaciones de menos de 500.00 euros, y las penas de cárcel para las donaciones que superen la citada cifra.
También en relación a la corrupción resaltar una cuarta reforma que modifica la inhabilitación de cargo público por todos los delitos relacionados con la corrupción en el ámbito de la Administración Pública. Entre los cambios acometidos, subrayar que se elevan las penas por este delito, se impide al condenado por delito de corrupción a optar durante el tiempo de la condena a un cargo electivo y se amplían los plazos de prescripción contemplados en el artículo 131 para los supuestos más graves.
En quinto lugar, el artículo 127 del Código Penal se amplía con siete subapartados (127 bis a octies), en los que se regula exhaustivamente el decomiso, permitiéndose lo que la Ley categoriza como el “decomiso ampliado”. El apartado VIII de la Ley Orgánica 1/2015 explica claramente que frente al decomiso directo y el decomiso por sustitución, el decomiso ampliado permite que a una persona se le puedan decomisar objetos de actividades ilícitas distintas a aquellas por las que haya podido ser condenado.
se impondrá en supuestos de excepcional gravedad tales como asesinatos especialmente graves, homicidio del Jefe de Estado o de su heredero, de Jefes de Estado extranjeros y en los supuestos más graves de genocidio o de crímenes de lesa humanidad. Esta nueva pena de duración indeterminada está recurrida ante el Tribunal Constitucional, sin que éste aún se haya pronunciado sobre la cuestión.
Otra de las grandes novedades del reformado Código Penal es la supresión de las faltas, que estaban previstas en el Libro III del Código Penal. Lo que antes se tipificaba como una falta ahora ha pasado o bien a tipificarse como un delito leve, castigados con multa, o a ser perseguido como una infracción mediante sanción administrativa o civil.
La tercera reforma que entendemos de relevancia por su gran actualidad es la creación del título XIII bis, en el que se prevén mayores penas
Mª Teresa Jurado Caballero. Letrada de Valenzuela & Bolás Abogados.
También por su relevancia actual nos parecen importantes de mención los cambios que esta reforma conlleva en materia de terrorismo, ya que se han ampliado los artículos 575 y siguientes del Código Penal relativos al terrorismo, y ahora se castigan, entre otros el adiestramiento de terroristas, los conocidos como “lobos solitarios” y los combatientes extranjeros.
La séptima modificación significativa del reformado Código Penal es el cambio en la edad de consentimiento para mantener relaciones sexuales, modificación que la Ley 1/2015 en el apartado XII de su preámbulo califica como una de las novedades más importantes al conseguir equiparar la legislación española con el marco legislativo de otros países de nuestro entorno. Tras la reforma, se eleva de trece a dieciséis la edad del consentimiento sexual, por lo que realizar actos de carácter sexual con un menor de dieciséis será considerado como un hecho delictivo, salvo, como explica la propia ley, “que se trate de relaciones consentidas con una persona próxima al menor por edad y grado de desarrollo o madurez”.
También en relación a los menores, la reforma del Código Penal presta especial atención al castigo de la pornografía infantil, adaptándose los delitos a la nueva realidad tecnológica y tipificándose como delito, por ejemplo, en el nuevo artí-
culo 183 ter, el contactar a un menor de dieciséis años a través de medios tecnológicos como internet con el fin de embaucarle a realizar actos que faciliten material pornográfico. Aumentan asimismo las penas relacionadas con la prostitución y concretamente las relacionadas con la explotación sexual y la corrupción de menores (artículo 187 del Código Penal).
Como noveno cambio importante también al hilo de la adaptación a las nuevas tecnologías, reseñar que el nuevo Código Penal prevé en sus artículos modificados 510 y siguientes, una agravación de la pena para los delitos de incitación al odio y a la violencia cometidos a través de internet o de otros medios de comunicación social.
Por último, y dado el interés de los lectores por el mundo animal, querríamos reseñar las modificaciones del artículo 337 en relación a los animales. Dicho artículo prevé que el abandono de un animal doméstico ahora constituya un tipo atenuado de maltrato animal, y se refuerza la protección animal, por ejemplo, castigando la zoofilia o las peleas de gallos y perros. Además, se añade el artículo 337 bis, que prevé multas para las personas que abandonen un animal doméstico o que no viva en estado salvaje, cuando pueda peligrar su vida, inhabilitando de uno a tres años a los maltratadores para tener mascotas.
Delitos cometidos en explotaciones agraias o ganaderas
Resaltar asimismo las modificaciones en el catálogo de agravantes de hurtos y robos previstos en los artículos 235 y 240, algo que la propia Ley Orgánica 1/2015 en el apartado XIV de su preámbulo presenta como una “respuesta al grave problema que plantean actualmente los delitos cometidos en explotaciones agrarias o ganaderas con causación de perjuicios relevantes a sus titula-
“ ... penas de prisión de uno a tres años para los hurtos “cuando se trate de productos agrarios o ganaderos, o de los instrumentos o medios que se utilizan para su obtención ...”
valoración de los productos sustraídos, y son causa de una grave sensación de desprotección e inseguridad para quienes los sufren”. El artículo 234 del Código Penal reformado castiga con pena de seis a dieciocho meses de prisión el hurto si la cuantía de lo sustraído excediese de 400 euros. El nuevo agravante, previsto en el artículo 235, apartado 4, contempla penas de prisión de uno a tres años para los hurtos “cuando se trate de productos agrarios o ganaderos, o de los instrumentos o medios que se utilizan para su obtención, siempre que el delito se cometa en explotaciones agrícolas o ganaderas y se cause un perjuicio grave a las mismas”, mientras que el artículo 240 apartado 2 agrava la pena del robo con fuerza pasando de una condena de uno a tres años de prisión a una agravada de dos a cinco años para las circunstancias previstas en el artículo 235, apartado 4. n



Cuando los veterinarios llegamos a las ganaderías, frecuentemente los ganaderos se quejan por el excesivo número de mamitis clínicas. Si empezamos a preguntar y a indagar en el problema, muchas veces nos encontramos con pocos datos realmente fiables: faltan casos por apuntar, no está la fecha de identificación de la mamitis, no se ha tomado ninguna muestra para identificación bacteriológica, los tratamientos no se terminan, o al contrario su duración es excesiva (he visto tratamientos de más de un mes). Y normalmente el comentario generalizado es que suelen ser las mismas vacas que repiten una y otra vez.
Después de analizar los datos, en muchos casos, la conclusión a la que llegamos es que no es que haya muchos casos clínicos, sino que hay muchas vacas que no curan adecuadamente y vuelven con los mismos síntomas al cabo de unos días después de dejar los tratamientos. El problema no está entonces en el porcentaje de casos clínicos sino en determinar la razón de que estos animales no curen.
¿Cuál es el número “normal” de casos clínicos?
En primer lugar, deberíamos definir qué es una mamitis clínica puesto que algo en lo que todos deberíamos estar de acuerdo, sin embargo, varía mucho de una explotación a otra. En algunas, se “cuenta” a la baja, es decir quedan sin apuntar y por lo tanto sin tratar, los casos leves. En otras, al
María Martín Richard. ASPROLAC maria@asprolac.comcontrario, se apuntan incluso las vacas sin síntomas de mamitis pero que han tenido una ligera bajada de producción, aunque no quede clara la razón.
Una mamitis clínica es toda aquella que presenta signos VISIBLES de alteración o bien en la leche o bien en el cuarterón. Puede cursar con cambios en la leche (“grumos” más o menos grandes, cambio de consistencia o de color) y/o con inflamación (mayor o menor). Puede haber o no bajada en la producción, fiebre, falta de apetito, incluso animales que mueren o tienen que ser sacrificados.
Por lo tanto, ante el primer síntoma por muy pequeño que sea, la vaca ya tiene mamitis clínica. Esos pequeños “grumos” que aparecen cuando sacamos los primeros chorros ya indican un caso, incluso si después ya no aparecen los “grumos”. Esto es ya un caso para apuntar y valorar cómo se trata.
Los tratamientos se deben enfocar según sean casos leves, moderados o graves (para algunos autores según sean casos subagudos, agudos o hiper agudos). Esto nos sirve a la hora de establecer protocolos de tratamiento.
Los casos leves son en los que solo existe como único síntoma, una ligera alteración de la leche: pequeños grumos o una secreción decolorada. No existe inflamación del pecho pero sí puede haber un pequeño aumento de la sensibilidad (la vaca se mueve más cuando se le van a poner las pezoneras o se la va a tocar). Existe un estudio que pone de manifiesto un aumento de la distancia entre corvejones pese a que no se perciba inflamación. Entre el 50 y el 90% de los casos pertenecen a este grupo.
En los casos moderados, ya existen otros signos además de la leche alterada. Los síntomas son más fuertes (hinchazón, dolor, leche muy alterada) y además se pueden acompañar ya de otros generales como fiebre, falta de apetito o bajada de la producción. Entre el 20 y 40% pertenecen a este grupo.
En los casos hiperagudos, los síntomas son más fuertes que los anteriores y además puede haber otros como pulso y respiración acelerados, falta de reflejo de pupilas, vacas que caen al suelo, deshidratación, diarrea. En la mayoría de los casos se piensa que la bacteria causante es E coli. Sin embargo, varios estudios han puesto de manifiesto que un porcentaje cercano al 50% de los casos se corresponden a gérmenes Gram positivos. Aproximadamente un 15% de estas vacas morirá.
A la hora de establecer tratamientos, se debe
tener en cuenta la diferente sintomatología y marcar una diferencia entre un tipo y otro de mamitis. Posteriormente, hay que revisar los resultados obtenidos para la curación clínica y bacteriológica de los casos y si es necesario, realizar los cambios que el veterinario considere.
Es muy recomendable, además, conocer las bacterias predominantes en la explotación con el fin de establecer protocolos de tratamientos correctos y efectivos. Para conocer los gérmenes causantes de las mamitis se debe tomar muestra de forma aséptica en el momento de la detección del caso y antes del tratamiento. Esta muestra se puede refrigerar si se va a enviar al laboratorio en 24-48 horas o bien congelar (aunque existen bacterias que mueren con la congelación). Según el coste de los análisis, puede que no sea rentable analizar todos los casos pero sí un número significativo.

Mamitis gangrenosa
Otra opción es tomar muestra de todos los casos y sólo analizar los que no han curado rápidamente o que han mostrado ser algo diferentes a los habituales (más agudos por ejemplo). Además sí se puede hacer al menos una vez al año un análisis por PCR para detección de gérmenes. Preferiblemente se debe elegir la prueba PCR de 16 gérmenes (con un precio de algo más de 20 euros). Esta prueba, al tener un precio más elevado que un análisis habiaño, es decir que al mes deberíamos estar en el 2,5%. En esto sólo contamos los casos que son nuevos, no los de vacas que vuelven a repetir caso clínico cada poco tiempo. En general, las cifras que manejamos en las explotaciones son bastante superiores a esta cifra. Tenemos también que tener en cuenta que se considera que el 40% de todos los

¿Qué son las mamitis recidivantes?
Se considera que una mamitis es recidivante (para algunos habría que hablar mejor de mamitis no curadas) cuando un animal vuelve a tener mamitis clínica en un mismo pecho antes de las 3 semanas del caso anterior. O mejor dicho, si repite un caso de mamitis en 21 días se considera que la bacteria es la misma que la vez anterior y, por lo tanto, que la vaca no curó del caso anterior. En estos casos, con el tratamiento se había producido una curación clínica (los síntomas habían desaparecido y por eso la dimos por curada) sin que haya existido una curación bacteriológica (la bacteria no ha desaparecido totalmente y por ello vuelve a dar síntomas a las pocas semanas).
Se considera que el número de casos recidivantes no debería superar el 10% de los casos de ma-
guno, la bacteria que origina la mamitis. Es lo que se llama curación espontánea. Se habla de un 20 al 40% de los casos. Suele ocurrir en casos leves o recientes y muy raramente en casos crónicos. En estos casos son las propias defensas de la vaca (glóbulos blancos) las que son capaces de eliminar la bacteria. Esto se produce más frecuentemente en vacas vacunadas.
En el lado contrario, existen también estudios que indican que el 65% de las vacas que tienen 2 casos de mamitis clínica en una lactación, también tendrán al menos un caso en la lactación siguiente. Y esta cifra aumenta al 70% cuando ha habido 3 casos clínicos. Esto debe ser tenido en cuenta a la hora de elegir qué animales deben ser sacrificados y cuáles merecen seguir siendo tratados.
Revisión de los tratamientos
Obviamente no se puede contar con la curación espontánea y con el sacrificio de animales para eliminar las infecciones mamarias en una ganadería. Cuando hace ya más de 60 años se empezaron a utilizar los antibióticos, se creyó que con ello se conseguiría eliminar las infecciones.
Sin embargo, la realidad es que existen bacterias que desarrollan no solo resistencias sino “habilidades” para no sucumbir a los tratamientos. Así que la utilización de antibióticos no permite como única medida la disminución de gérmenes de la explotación.
Una vez que la bacteria entra en la ubre, las defensas empiezan a trabajar para “limpiar” y destruir. Son principalmente los glóbulos blancos que acuden desde la sangre a la ubre (por eso aumenta el recuento celular que es el contaje de este tipo de células). Sin embargo y por varios motivos, la destrucción de las bacterias por parte de estos glóbulos blancos no es tan efectiva como debiera. Una de las razones es que la caseína y la grasa también son “engullidas” por el glóbulo blanco e interfieren en la destrucción.
En el caso de una ganadería con muchos casos de recidivantes se debería verificar que el germen causante no sea un micoplasma o una prototheca, puesto que no tienen curación con los tratamientos actuales.
En el caso de haber realizado una buena identificación y de haber verificado mediante el antibiograma qué antibióticos son los más apropiados, en
Los antibióticos, que deberían ser como armas de destrucción masiva, sin embargo, también fallan bien porque no entran en contacto directo con la bacteria (por ejemplo, se interponen tejidos propios de la inflamación), porque el antibiótico no difunde bien dentro de la ubre, porque no se alcanza la concentración requerida o simplemente, porque el antibiótico no es el adecuado para la bacteria a la que hacemos frente.
Los antibióticos no son el único tratamiento que se debe utilizar, al menos en los casos moderados o graves. La aplicación de antiinflamatorios, suero hipertónico e incluso oxitocina deben ser considerados cuando existen más síntomas que la alteración de la leche. También se puede discutir sobre si la


Estrategias para individualizar los sujetos de riesgo en el peripato
Según un estudio canadiense de hace unos años, cerca del 75% de todas las enfermedades metabólicas e infecciosas de las vacas de leche se evidencian en el primer mes de lactación. En las ganaderías a menudo se carece de la percepción, incluso numérica, de este hecho porque raramente se registra esta información o, simplemente, porque no se realizan análisis estadísticos. Sin embargo, preocupa el hecho de que los casos clínicos sean solo una pequeña parte de los animales que acusan problemas serios de salud. De hecho, muchas vacas presentan importantes anomalías fisiológicas que permanecen latentes, en buena parte camufladas por la capacidad de defensa del animal, que enmascara la gravedad del cuadro clínico.
El aumento del tamaño medio de las ganaderías también ha perjudicado a las vacas de más riesgo, en cuanto a que el ritmo de trabajo del personal dedicado a estos animales es a menudo inadecuado, la formación profesional no es siempre suficiente y la interacción entre los distintos profesionales que operan en la misma explotación es poco sólida.


El inicio de la lactación sigue siendo el punto más crítico de todo el ciclo productivo de las vacas de alto valor genético y por lo tanto se supone que la atención de ganaderos y técnicos siempre se concentra más en este periodo. En consecuencia, se han introducido varios instrumentos para atenuar la gravedad de estos problemas, como la monitorización sistemática de algunas funciones fisiológicas (actividad motora, rumia, producción de leche) para detectar los primeros síntomas de malestar; el uso de programas de gestión para localizar los problemas más graves y tener idea de las posibles causas; y la determinación diagnóstica rápida en fluidos biológicos (leche, sangre orina, saliva) para anticipar el diagnóstico de la patología.
mal. En todos los casos, su determinación e interpretación no es sencilla porque pueden influir varias causas. A veces la interpretación es resumida o más bien “informal”, generando no pocos malentendidos y decepcionando las expectativas de los ganaderos. Por tanto, es importante ofrecer cierto rigor.
Perfil hematoquímico: cuándo es útil
El perfil metabólico fue propuesto hace más de 40 años por investigadores ingleses para proporcionar elementos objetivos de juicio sobre enfermedades no rápidamente diagnosticables y para mejorar el diagnóstico de errores alimentarios. Su empleo en ganadería ha encontrado numerosos obstáculos, relacionados sobre todo a la estandarización de los procesos de muestreo, a la interpretación y a los costes.

Desde hace mucho tiempo, la sangre representa la sustancia más idónea para la valoración diagnóstica tanto de naturaleza infecciosa como metabólica. Algunos indicadores como la glucosa, cuerpos cetónicos (a menudo medidos como betahidroxibutirato = BHB), NEFA (ácidos grasos no esterificados), calcio y urea, con frecuencia se detectan en el periparto y forman ya parte del lenguaje común de ganaderos y técnicos. Otros indicadores son menos conocidos (por ejemplo aquellos relacionados con episodios inflamatorios o con el estrés oxidativo), pero recientemente han sido asociados al rendimiento de las vacas y ofrecen, por tanto, información sobre la carrera del ani-

La evolución tecnológica ha introducido progresivamente instrumentos de diagnóstico cada vez más rápidos y sencillos de usar, utilizables directamente en la ganadería (por ejemplo, el proceso analítico de química seca –dry cremistry– que utiliza reactivos secos e inmovilizados en una cantidad predeterminada y en un soporte adecuado). Actualmente es posible determinar algunos parámetros hemáticos en caso de sospecha de una patología específica (ej. calcio para colapso puerperal, BHB para la cetosis), para la verificación de ciertas condiciones nutricionales (urea para la disponibilidad de nitrógeno y energía en el rumen) y también para identificar individuos en riesgo de patologías (proteína de fase aguda).
Con el tiempo, la oferta diagnóstica se ha ido ampliando y algunos indicadores, que antes solo se determinaban a nivel hemático, ahora también se
Erminio Trevisi. Instituto de Zootecnia. Facultad de Ciencias Agrarias, Alimentarias y Medioambientales. Universidad del Sacro Coure, Piacenza (Italia) erminio.trevisi@unicatt.it. Bianco Nero enero/febrero 2015
pueden analizar en otros fluidos biológicos (leche, orina, saliva). Por ejemplo, el BHB puede detectarse en la orina y en la leche, mientras que la urea se mide de forma rutinaria en la leche. Sin embargo, la sangre sigue siendo el fluido elegido, especialmente para controlar la fase de periparto. De hecho, la extracción de la muestra hemática (de la vena yugular o de la caudal) resulta sencilla y rápida en cualquier fase de la vida, es poco invasiva y permite determinar todos los parámetros de interés con métodos fáciles y menos costosos.
(por ejemplo, NEFA, BHB, metabolitos reactivos del oxígeno).
Actualmente, los principales indicadores hemáticos que proporcionan información útil sobre el periparto se pueden agrupar en cuatro categorías: índices de balance energético (glucosa, NEFA, BHB), índices de colapso puerperal (calcio), índices del estado de estrés oxidativo e índices de la respuesta de fase aguda (o de los estados inflamatorios).
La leche está disponible solo después del parto; la toma de muestras de orina requiere más tiempo

1. Índices del Balance Energético Negativo (BEN)
Inmediatamente después del parto, la ingestión de alimentos (en particular los energéticos) es insuficiente en comparación con las necesidades nutricionales y determina la movilización de las reservas corporales, con importantes repercusiones a nivel endocrino-metabólico. Si el BEN es elevado, la glucosa hemática se reduce. La recuperación de los valores dentro del rango de referencia (3,3-3,9 mmol/l) es generalmente rápida en las vacas de leche y se produce incluso cuando el déficit energético aún no ha concluido.
(y es igualmente invasiva si se hace con catéter) y en la saliva solo se pueden hacer unas pocas determinaciones.
Centrándonos en el periparto, que en general incluye las 3-4 semanas antes y después del parto, es preciso señalar que el perfil metabólico clásico no siempre es el instrumento más adecuado, sobre todo al inicio de la lactación. En Italia, este perfil ha sido desarrollado por el Instituto de Zootecnia de la Universidad del Sacro Coure (Piacenza) desde los años 80 y se conoce como Perfil Metabólico Piacenza (PMP). El objetivo del PMP es evaluar vacas clínicamente sanas en el periodo seco, entre 10 y 30 días antes del parto, y en la lactación, entre 25 y 90 días de lactación. Durante el periparto, solo se toman muestras en el periodo seco y se evita hacerlo en la lactación, ya que esta fase se caracteriza por la mayor incidencia de problemas. Además, en el PMP no figuran algunos parámetros que con el tiempo se han revelado como muy útiles para identificar los animales con riesgo de afecciones
En general, la glucemia puede dar indicaciones útiles solo si se determina en la primera semana de lactación. Indicadores más consistentes para identificar las condiciones de BEN son los NEFA y el BHB. La concentración de NEFA es proporcional a la movilización de lípidos del tejido adiposo. Por encima de 1,0 mmol/l denotan un uso excesivo de las reservas, con el consiguiente riesgo de desarrollar cetosis o esteatosis. Es más común la determinación del BHB, cuerpos cetónicos que se forman en el hígado como resultado de la incapacidad de oxidar los ácidos grasos movilizados, por la insuficiente disponibilidad de energía (glucosa). Valores de 1,4 mmol/l se consideran el umbral de la cetosis subclínica, sin embargo, ya en concentraciones superiores a 1,0 mmol/l se ha observado un aumento del riesgo de desplazamiento de abomaso. Las altas concentraciones de BHB agravan, además, los síntomas de otras patologías; Duffield ha subrayado que los episodios de mastitis han resultado más severos y prolongados con valores superiores a 1,4 mmol/l en comparación con vacas con niveles dentro del rango normal. Los valores hemáticos de los NEFA y los BHB por encima del rango de referencia si observan solo después del parto (figura 1), sin embargo, su aumento puede comenzar en la fase final de la gestación si se manifiestan problemas de salud asociados a una disminución significativa de la ingestión de alimentos. En estas situaciones, el aumento por encima de 0,30 mmol/l para los NEFA y de 0,7-0,8 mmol/l para los BHB representan ya situa-
) de la ingestión de SS antes del parto (Trevesi et al., 2002)
Ingestión de sustancia secaHaptoglobina

ninguna tardía precoz


ninguna tardía precoz

ciones de riesgo. Hay que recordar también que la comida es un factor importante de variación de estos parámetros (después de la comida se reducen los NEFA y aumenta el BHB), por lo que para una correcta valoración es necesario obtener la muestra de sangre antes de suministrarla. En presencia de concentraciones demasiado elevadas de NEFA y BHB se debe intervenir con terapias adecuadas para atenuar el nivel de cetosis y facilitar un aumento más rápido de la ingestión de alimentos. Desafortunadamente, estos tratamientos no siempre son eficaces, ya que la cetosis primaria (debida a la carencia de sustratos glucogénicos) es más rara que la cetosis secundaria (producida por la presencia de otras enfermedades con efecto deprimente sobre el apetito). Así que la cetosis solo se puede contrarrestar eficazmente eliminando el agente causal.
2. La calcemia
El contenido de calcio en la sangre está controlado a nivel endocrino y sus oscilaciones normalmente son pequeñas (2,50-2,75 mmol/l), salvo en las primeras horas después del parto, cuando la repentina y enorme demanda mamaria puede provocar una fuerte caída, con la aparición de colapso puerperal si los valores descienden por debajo de 2,0 mmol/l. A menudo, sin embargo, los niveles de calcio en el periparto tienen valores óptimos incluso cuando se utilizan raciones bajas en calcio y potasio en el periodo seco o cuando se añaden sales aniónicas (lo que determina la reducción del pH hemático, favoreciendo la movilización del calcio óseo). En este caso, probablemente, la hipocalcemia es atribuible al desarrollo de estados inflamatorios, muy frecuentes en el periparto, y por tanto no se puede tratar solo con la alimentación.

las vacas de leche, durante el último trimestre de gestación y el inicio de la lactación se produce un aumento importante de metabolitos reactivos de oxigeno (ROM) y simultáneamente aumentan las necesidades de micronutrientes, entre los cuales muchos presentan actividad antioxidante.
El periparto se caracteriza, por tanto, por posibles daños oxidativos que se han asociado con enfermedades y trastornos metabólicos. Por esta razón puede ser de utilidad la determinación de indicadores específicos como ROM, moléculas antioxidantes (por ejemplo, vitamina E, beta-caroteno) y anti-oxidantes (FRAP: Ferric Reducing Antioxidante Power; ORAC: Oxygen Radical Absorbance Capacity). La complejidad, la dificultad analítica y las numerosas interacciones entre los antioxidantes y los sistemas biológicos hacen difícil la valoración del estrés oxidativo del ganado. En la actualidad no se dispone de métodos estandarizados para todos los biomarcadores mencionados anteriormente y también se carece de rangos de referencia. En base a nuestra experiencia, sin embargo, podemos asumir que en la fase de secado son satisfactorias concentraciones de ROM de hasta 10 mg H2O2/100 ml, mientras que después del parto, son aceptables aumentos de hasta 13 mg H2O2/100 ml. Sin embargo, en los siguientes días de lactación se pueden observar picos eventuales de hasta 16-17 mg H2O2/100 ml, sin que esto constituya por sí mismo una alarma seria para la vaca.
Para la vitamina E hay numerosos estudios y, aunque no hay unanimidad sobre el valor mínimo de referencia, el valor mínimo aceptable en plasma se puede fijar en torno a 1,5-2 mg/ml.
4. Índices de la inflamación
El periparto de la vaca, incluso en ausencia de patologías manifiestas, se caracteriza por un cuadro hematoquímico típico del proceso inflamatorio y de la subsiguiente respuesta de fase aguda. La respuesta inflamatoria se debe a varias causas, entre las que figuran algunas condiciones típicas del periparto (traumas e infecciones uterinas, estrés psicológico derivado de la adaptación, anomalías digestivas que conllevan absorción de lipo-polisacáridos, estrés climático) y se mide por la liberación de citocinas pro-inflamatorias (PIC, por ejemplo IL1, IL-6, TNFα) por monolitos-macrófagos, epitelios y el propio hígado. Según nuestra reciente investigación, la concentración de PIC está correlacionada con el rendimiento de la vaca al inicio de la lactación, pero en estos momentos en prematuro su uso en campo.
3. Índices del estrés oxidativo
Las moléculas oxidantes juegan un papel central en la función celular normal, regulando importantes vías metabólicas y funciones de la célula. Sin embargo, en algunas situaciones se comprueba una condición de estrés oxidativo por el desequilibrio entre moléculas pro-oxidantes y moléculas antioxidantes. Por ejemplo, los estados que conllevan la activación del sistema inmunitario aumentan el consumo de antioxidantes y reducen la capacidad tamponante a nivel hemático. También la respuesta inflamatoria, que puede ser independiente de la presencia de procesos infecciosos, es responsable de la producción elevada de moléculas pro-oxidantes. Es interesante destacar que estas dos condiciones se producen en el inicio de la lactación. En
Hace tiempo que se recogen numerosas evidencias sobre los cambios que estos mediadores inducen en el hígado. La liberación de PIC provoca, de hecho, dos fenómenos interesantes: aumento de la síntesis de algunas proteínas, llamadas proteínas de fase aguda positivas (PPA+), como la haptoglobina, ceruloplasmina, amiloide A sérico, y reducción de otras proteínas, llamadas proteínas de fase aguda negativas (PPA-), como albúmina, enzimas (p.e. paraoxonasas), transportadores plasmáticos de vitaminas y hormonas (p.e. la proteína fijadora de retinol que transporta la vitamina A; la transcortina que transporta los corticoesteroides), lipo-proteínas (habitualmente medidas como colesterol). Las variaciones hemáticas de esta proteína (aumento de la PPA+ y reducción de la PPA-) están asociadas a importantes consecuencias en las vacas al inicio de la lactación, como son: aumento de la incidencia de enfermedades, reducción del rendimiento (cantidad de leche y fertilidad), mayor
deposición de triglicéridos en el hígado por la síntesis inadecuada de las lipo-proteínas necesarias para introducirlos en el flujo hemático (torrente sanguíneo). La condición crítica del post-parto es atribuible tanto a la intensa movilización de tejido adiposo, si es severa, como al severo, y en cierto modo incontrolado, estado inflamatorio. Por esta razón, las variaciones en la actividad hepática, con sus efectos sobre las concentraciones de la PPA positiva y negativa, son de gran utilidad diagnóstica. Las PPA+ son útiles para detectar la presencia de patologías que activan la respuesta de fase aguda, tanto clínica como subclínica. Es interesante observar que la bajada de ingestión en la última semana de gestación está asociada a su aumento (figura 1). De hecho, la anorexia se cuenta entre las consecuencias negativas del proceso inflamatorio, y es responsable de la aparición del BEN y del aumento hemático de los NEFA y cuerpos cetónicos. Estos hechos confirman, por tanto, que la caída en la ingestión pre-parto es una señal importantísima de estados de salud inadecuados.
El futuro del PMP: índices hemáticos compuestos para identificar los animales en riesgo
Teniendo en cuenta las notables repercusiones negativas en los animales que muestran indicadores hematoquímicos inadecuados, parece claro que la medición de algunos índices puede ser muy útil en la ganadería. Sin embargo, surge la dificultad de evaluar más parámetros simultáneamente. Una posible estrategia es desarrollar índices compuestos que incluyan los biomarcadores más representativos. Después del parto, la tendencia de la PPA+ no discrimina adecuadamente las vacas respecto a la gravedad de las patologías que se han producido, a excepción de las condiciones más extremas: vacas en condiciones óptimas frente con otras con serios problemas clínicos. Esto se debe a que el proceso inflamatorio no es negativo en sí mismo y, cuando es necesario, debe seguir su curso (rápido
Actividad Hepática), que incluye las tendencias de tres PPA- (albúmina, colesterol como índice de la lipoproteína y vitamina A como índice de su proteína transportadora) en el primer mes de lactación (esquema 1). Las vacas con los niveles más altos de LAI entre la población controlada presentaron menores efectos negativos de la respuesta inflamatoria a nivel hepático, así como menor incidencia de patologías y mejor rendimiento productivo y reproductivo. A nivel hemático, las vacas con alto LAI también evidenciaron un menor estrés oxidativo y reducción más rápida de la PPA+ en el post-parto. El LAI, sin embargo, no puede identificar de antemano las vacas en riesgo en el momento del parto porque necesita mediciones en el primer mes de lactación y expresa una comparación limitada entre una población dada (o el rebaño muestreado). Pero el LAI sí puede utilizarse para identificar a las vacas con problemas subclínicos sobre las que anticipar las terapias de recuperación y facilitar la reanudación de la actividad reproductiva. Se trata de una parte importante del rebaño, al menos del 30% según nuestra experiencia.
Para corregir algunos de los inconvenientes encontrados con el uso del LAI, desarrollamos posteriormente otro índice compuesto llamado Liver Functionality Index (LFI). Este índice se calcula utilizando solo dos muestras hemáticas extraídas los días 3 y 30 de la lactación y evalúa la evolución de dos PPA- (albúmina y lipoproteína) y de la bilirrubina total, cuya concentración aumenta en el plasma cuando el hígado es incapaz de expresar el complejo enzimático necesario para su excreción. El LFI representa un valor absoluto en cuanto que se estima comparando los índices hemáticos seleccionados de un grupo de individuos sanos y con rendimientos óptimos (esquema 1). Por tanto, el LFI permite la comparación de vacas procedentes de distintas ganaderías, porque cuanto más alto es, mejores son las condiciones de los animales en el post-parto.

Figura 2. Evolución de la ingestión de sustancia seca (izquierda) y de bilirrubina total (derecha) en vacas de leche pertenecientes al mismo rebaño, pero con diferentes valores de LFI (Liver Functionality Index): LFI elevado correspondiente al tercio superior ( ) y LFI bajo, correspondiente al tercio inferior () (Trevesi et al., 2002)
kg/d
Ingestión de sustancia secaBilirrubina
μmol/L

LFI alto LFI bajo
-28-21-14-707142128
LFI alto LFI bajo


Días al parto
Esquema 1
Liver Activity Index (LAI) (Trevisi et al., 2001)
-28-21-14-707142128
Días al parto
El LAI incluye las medias de las concentraciones hemáticas de los días 7, 14 y 28 de lactación (DEL) de albúmina, lipoproteína (medida indirectamente como colesterol total) y retinol binding protein (RBP, medido como retinol, cuya concentración hemática está estrechamente relacionada con la de la RBP sintetizada en el hígado).
Para cada vaca, los datos de los tres parámetros hemáticos son transformados en unidad de desviación estándar según el siguiente procedimento: (i) cálculo de la media y desviación estándar de la población controlada para cada parámetro hemático (albúmina, colesterol total y RBP); (ii) el valor medio de la población de cada parámetro se resta del valor medido a los 7, 14 y 28 DEL de cada vaca y se divide por la desviación estándar correspondiente; (iii) para cada índice hemático y para cada vaca, la media de los tres valores obtenidos con las muestras tomadas los días 7, 14 y 28 DEL; (iv) el valor final del LAI de cada vaca se obtiene de la suma de los promedios de los tres índices parciales relativos a la albúmina, lipoproteínas y RBP.
El valor del LAI representa una estimación de las consecuencias del proceso inflamatorio que se produce en periparto en cada vaca, y se evalúa dentro del rebaño. Se trata, por tanto, de una estimación que permite realizar en una población una evaluación retrospectiva del éxito o fracaso del periodo de transición y evaluar el potencial de la futura lactación.
Liver Functionality Index (LFI) (Trevisi et al., 2011)
El LFI incluye tres parámetros hemáticos: albúmina, lipoproteína (medida indirectamente como colesterol total) y bilirrubina total (como medida indirecta de las enzimas sintetizas por el hígado que coordinan la eliminación de la bilirrubina de la sangre). El LFI mide las variaciones de concentración de los tres parámetros entre los días 3 y 28 DEL, estandarizados con las concentraciones óptimas de los tres parámetros obtenidas de vacas sanas en la misma fase de lactación (obtenidos por el mejor cuartil del LAI).
El LFI se calcula en dos fases:
(1)Subíndice Albúmina (Alb-I)=50% DEL3 + 50% (DEL28 - DEL3)
Subíndice Colesterol (Cho-I)=50% DEL3 + 50% (DEL28 - DEL3)
Subindice Bilirrubina (Bil-I)=67% DEL3 + 33% (DEL3 - DEL28)
(2)LFI = (Alb-I - 17,71)/1,08 + (Chol-I - 2,57)/0,43 + (Bil-I - 6,08)/2,17 Igual que el LAI, el LFI permite evaluar las consecuencias de los procesos inflamatorios que ocurren en el periparto. El LFI representa un valor absoluto, por lo que se puede utilizar para comparar vacas procedentes de diferentes ganaderías.
Los lectores interesados en la bibliografía, pueden solicitarla al autor: erminio.trevisi@unicatt.it
de identificar los animales en riesgo en los días inmediatamente siguientes al parto. Por este motivo, estamos desarrollando indicadores compuestos medibles en las últimas semanas de gestación o detectables con una sola extracción hemática realizada en el inicio de la lactación. Un primer intento propuesto por Grossi incluye en el nuevo índice compuesto cuatro biomarcadores –albúmina, ROM, haptoglobina y bilirrubina– y ya se puede probar en ganaderías.
Implicaciones y perspectivas
No hay duda de que a pesar de los notables esfuerzos realizados para mejorar el manejo de la fase de transición de las vacas lecheras de alto potencial productivo, los resultados no son todavía satisfactorios porque aun hay demasiadas vacas que padecen diferentes patologías en los primeros meses de lactación, cuyas consecuencias se prolongan durante toda la lactación. El empleo de algunos biomarcadores hemáticos para identificar de antemano los individuos con patologías subclínicas a principio de lactación resulta prometedor, sobre todo donde no se hayan adoptado sistemas eficaces de monitorización de algunas variables fisiológicas relacionadas con el estado de salud y el bienestar animal (por ejemplo, temperatura corporal, rumia, comportamiento). La observación de los indicadores hemáticos del balance energético parece demasiado simplista y muchas veces no permite identificar con la máxima antelación el inicio de la patología. Más eficaz es, sin embargo, el uso de un pool de indicadores que incluyan parámetros de procesos inflamatorios y de estrés oxidativo. Dos de estos índices (Liver Activity Index y Liver Functionality Index) permiten ya identificar en el rebaño a los individuos que, sin enfermedades clínicas, están en riesgo de padecerlas a lo largo de la lactación, en especial en la funcionalidad reproductiva. En un futuro próximo serán de especial interés algunos biomarcadores (ciertas citocinas, ceruloplasmina, paraoxonasas) que muestran, ya en el periodo seco, importantes diferencias de concentración entre individuos con buen y mal rendimiento en la siguiente lactación, y nuevos índices compuestos calculados con una sola muestra extraída los primeros días de lactación. Por tanto, el camino para identificar a los individuos asintomáticos y con mayor riesgo, está ya trazado.

El cáncer quizás sea la enfermedad de la que más frecuentemente hablamos. Todos tenemos familiares y conocidos que lo han padecido y, aunque hoy día las tasas de curación de muchos de ellos son muy superiores a las de años atrás, sigue siendo una causa importante de mortalidad. Como no podía ser de otra manera, en veterinaria tam-

Debido a que tenemos muchos tipos de células y hay muchos tipos distintos de factores cancerígenos, no podemos decir que el cáncer sea una enfermedad única, sino que existen muchos tipos diferentes, unos doscientos.
En la mayoría de las ocasiones esas células son detectadas y destruidas por el sistema inmune, pero si éste falla,la enfermedad se desarrolla sin control.Puede afectar a tejidos sólidos como por ejemplo la piel o los huesos, cuyas células, al crecer, forman abultamientos, lo que se conoce como tumor cancerígeno. También hay cánceres del tejido sanguíneo que alteran las células de la sangre. En este caso las células se multiplican descontroladamente pero como no forman las protuberancias que comentamos anteriormente, se les conoce como leucemias. Si son los linfocitos sanguíneos los afectados, se alterarán y también aparecerán tumores en los ganglios, dando lugar a los llamados linfomas.
carcinoma de células escamosas suele aparecer en el tercer párpado
El cáncer es una enfermedad que afecta a todos los animales. La palabra cáncer, que significa “cangrejo”, la utilizó por primera vez el médico griego Hipócrates, debido al aspecto que presentaban los tumores cancerosos, que al crecer y ramificarse se asemejaban al cuerpo y las patas de un cangrejo. Y es precisamente eso lo que caracteriza al cáncer, el crecimiento descontrolado de ciertas células. Todas las células del organismo tienen una vida fijada de antemano: nacen, crecen, se reproducen y mueren, tal y como lo tienen programado genéticamente, según la función que desarrollen. Pero a veces ese código genético se altera por factores externos o bien viene alterado de nacimiento y aparecen células que se reproducen sin control.
Juan Vicente González Martín.
DVM, PhD, Dipl. ECBHM.
Profesor Titular Dpto. de Medicina y Cirugía Animal, Facultad de Veterinaria, UCM
TRIALVET Asesoría e Investigación Veterinaria SL. www.trialvet.com
Hemos dicho que la causa de los cánceres viene dada por alteraciones del genoma de la célula, de origen hereditario o por influencia de factores externos, los denominados genéricamente carcinógenos. Hay carcinógenos químicos, tóxicos, siendo el tabaco el más conocido y no por ello menos extendido entre nosotros. Existen también carcinógenos físicos, radiaciones, como la radiación ultravioleta solar, y carcinógenos de origen infeccioso, virus, como los virus de la hepatitis B y C o el virus de la inmunodeficiencia humana, VIH, más conocido entre nosotros como SIDA. Los propios papilomas, conocidos vulgarmente como verrugas son tumores benignos. La diferencia entre un tumor maligno y uno benigno es que este último crece anormalmente pero no invade otros tejidos ni se disemina por el cuerpo a través de la sangre, o lo que es lo mismo, no produce metástasis.
Bueno pero… ¿en nuestras vacas qué? ¿Sufren el cáncer o no?
Como ya dije, nuestras vacas lecheras, al igual que todos los animales, también sufren cáncer, pero afortunadamente los padecen en grado mínimo. Hay varios factores que hacen que sea así. En primer lugar, nuestras vacas raramente llegan a la vejez. En la vejez las células del organismotienen más probabilidad de sufrir los efectos de los agentes carcinógenos, debido a la gran cantidad que han ido acumulandoa lo largo del tiempo. Por otro lado, el sistema inmune funciona peor, por lo que es mucho más probable que aparezcan cánceres. Las vacas pueden vivir algo más de veinte años, pero las vacas lecheras, debido a múltiples causas, raramente alcanzan algo más de diez, por lo que no es fácil ver estos tumores que son más comunes en la vejez.
La vaca también sufre la infección de virus carcinógenos, como el virus de la leucosis bovina, que es el más conocido. Este virus se transmite a través de la sangre, por picaduras de insectos o por material sanitario contaminado con sangre, y también por vía vertical de madre a hijo. Alrededor de un
cinco por ciento de las vacas infectadas desarrollan la enfermedad denominada leucosis enzoótica bovina, caracterizada en animales adultos por la presencia de leucemia y tumores linfáticos llamados linfosarcomas o linfomas malignos. Afortunadamente, aunque ese virus es de distribución mundial, en algunos países de Europa y entre ellos España, se erradicó con las campañas de saneamiento hace ya bastantes años.
A pesar de ello, tenemos que tener en cuenta que, aunque rarísimos, existen tumores semejantes que no son de origen vírico, denominados linfomas esporádicos. Éste, al contrario que los de origen vírico, suele afectar a animales jóvenes o muy jóvenes. Además de las alteraciones sanguíneas podemos ver una forma cutánea con linfosarcomas, que produce múltiples tumores subcutáneos y una forma tímica, en la que se produce una tumoración del timo que provoca graves edemas en el cuello. Se presentan con muy poca frecuencia, de hecho, en más de treinta años de práctica clínica sólo habré diagnosticado media docena.
Las vacas son infectadas por seis tipos distintos de papilomavirus. Al igual que en humanos, esos virus dan lugar a verrugas, pero en la vaca no hay constancia de que puedan malignizarse como sucede con el papiloma de cuello de útero de las mujeres.
Entre los carcinógenos de origen tóxico, los más conocidos en la vaca son los que se encuentran en los helechos, como el helecho macho, Pteridium aquilinum. Dada su localización típica en zonas de montaña, sólo afectan a las vacas que pastan en esos terrenos. Al ingerirlos causan pólipos en el aparato digestivo, principalmente el esófago y rumen, y en la vejiga urinaria. Nunca he conocido un caso en vacas lecheras, aunque por ejemplo en las islas Azores, donde las vacas lecheras viven y pastan en las montañas, son comunes.
Aunque también muy poco frecuentes, existen muchos otros tipos de tumores en las vacas, la mayoría benignos. Los más fácilmente observables son los tumores que aparecen en la piel o en los tejidos subcutáneos y hacen prominencia (primero pondré el nombre de los tumores benignos, que son los más comunes, y después los malignos, que suelen terminar en sarcoma): hemangiomas y hemangiosarcomas de origen vascular, lipomas y liposarcomas del tejido graso subcutáneo, fibromas y fibrosarcomas del tejido cutáneo, melanocitoma y melanomas también del tejido cutáneo, etc. En el aparato genital, al igual que en otros sistemas, también podemos encontrar tumores que, en ocasiones, protruyen a través de la vulva o bien son detectados por palpación rectal al realizar la inseminación artificial. Los más comunes son los fibropapilomas, leiomiomas, fibromiomas, fibromas, adenocarcinomas, etc.,vaginales o uterinos.
Entre los tumores malignos, los más comunes son los carcinomas, que afectan a las células epiteliales. Existen bastantes tipos de carcinomas: uno de ellos es el carcinoma de células escamosas, que es el tumor maligno predominante en la vaca en aquellas zonas, como España, en la que se ha erradicado la leucosis. Las células escamosas son las células epiteliales que se encuentran debajo de la capa más externa de la piel y también en el aparato digestivo, respiratorio y otros órganos con epitelio. Se denominan escamosas porque al microscopio puede verse que son planas, como las escamas de un pez. En la vaca esos tumores se localizan comúnmente en zonas mucocutáneas, esto es, zonas de unión de la piel con la mucosa, como
en los párpados, sobretodo en el inferior, en el tercer párpado e incluso en el propio globo ocular, que cuando progresan pueden extenderse por toda la zona ocular. Es lo que se denomina vulgarmente cáncer de ojo y se produce por efecto de la radiación solar ultravioleta, por lo que los animales más afectados son los que tienen la piel de los párpados de color blanco y están expuestos al sol. Las vacas de las razas hereford, simmental y holstein que habitan en zonas muy soleadas son las que más incidencia sufren. Se da en animales adultos, no antes de los tres años de edad, siendo los animales viejos, de más de siete años, los que más los sufren, ya que igual que sucede en nuestra especie con los melanomas malignos, la radiación ultravioleta tiene un efecto acumulativo.Además, de manera similar a muchos cánceres, tiene un componente genético y se sabe que hay familias de vacas mucho más

En fases más avanzadas invade el resto de tejidos oculares y produce metástasis
Lo normal es que sea una conjuntivitis producida por diversas causas: polvo u otro cuerpo extraño que se ha metido en el ojo, una infección o incluso parásitos como las lombrices del género Thelazia. Esas conjuntivitis se pueden tratar con unas gotas de antibiótico, como por ejemplo el de las jeringas de tratamientode mamitis, usadas como si fueran un colirio durante tres días.Si no mejora es necesario llamar al veterinario; porque si esa inflamación del tercer párpado se cronifica, dará lugar en primer término a una hiperplasia, es decir, un crecimiento exagerado de las células epiteliales del párpado pero que conservan su estructura normal; que posteriormente provocará la displasia del tejido, en la que las células seguirán reproduciéndose pero ya no serán normales; y en un tercer estadio aparecerá el carcinoma denominado in situ, porque aún no habrá metastatizado. Las lesiones precancerosas son redondeadas y tienen un color sonrosado, propio de tejidos inflamados, pero cuando ya ha malignizado las lesiones tienen forma semejante a una coliflor y un color amarillento.
El cáncer de ojo en un estadío inicial se puede operar fácilmente con anestesia local y tranquiliza-

ción general, empleando la cirugía clásica, la criocirugía y la hipertermia con bisturí eléctrico. A pesar de no poder asegurar en un cien por cien que no reaparezca, si se opera pronto los porcentajes de éxito son altos, del orden del noventa por ciento. Los tumores que aparecen en el globo ocular hacen necesaria su enucleación, aunque tienen la ventaja de que metastatizan más lentamente que los de los que se dan en los párpados. Es necesario considerar que según el tumor avanza, las posibilidades de éxito disminuyen porque el tumor no sólo invade todos los tejidos que le rodean sino que también puede producir metástasis a otros órganos Con el tumor afectando a los párpados y el globo ocular, se hace necesaria la extirpación tanto de los párpados como del ojo. En ese punto la tasa de curación es del orden de un cincuenta por ciento o menos. La metástasis se produce por el drenaje del sistema linfático, por lo que los ganglios de la cabeza, parotídeos de debajo de la oreja y los submandibulares y sublinguales de debajo de la quijada, en poco tiempo empezarán a abultarse. En las fases avanzadas el tumor se necrosa y con frecuencia aparece sangrante, purulento, maloliente por la contaminación bacteriana e incluso parasitaria con miasis, debido a lo atractivo que resulta ese olor para las moscas.El cáncer de ojo no es una enfermedad que se transmita de los animales a los hombres, no es una zoonosis, pero los animales enviados al matadero con tumores avanzados son decomisados. El carcinoma de células escamosas también puede darse en la zona vulvar, en las cicatrices producidas por el marcado al fuego, en la punta de las orejas o la piel de la ubre.
Por si todo esto no fuera suficiente, debido al aspecto desagradable y fundamentalmente al sufrimiento que causa en los animales, los propietarios de un animal enfermo pueden sufrir sanciones por


Introducción
Son varios los trabajos que hemos publicado en esta revista sobre el manejo del estrés térmico, analizando las necesidades térmicas de las vacas lecheras, sus mecanismos de producción, eliminación e intercambio de calor, así como los distintos métodos para mitigarlo (Frisona Española nº 196). Asimismo, en el último número (Frisona Española nº 207) exponíamos los principales efectos del estrés calórico (en adelante, EC) en la fisiología digestiva y reproductiva, en el rendimiento y en el comportamiento del animal, así como las consecuencias económicas derivadas.
En este nuevo trabajo expondremos distintas opciones para poder aumentar la pérdida de calor por parte del animal, puesto que los métodos para reducir la ganancia térmica (principalmente sombreo y manejo de la alimentación) ya han sido expuestos en otros trabajos.
Un sistema de mitigación del calor tiene que proporcionar cuatro elementos básicos:
1. Sombra
2. Intercambio de aire (ventilación)
3. Maximizar la pérdida de calor por convección
4. Eliminar calor por evaporación
Si se asume que la estructura de la nave proporciona una sombra adecuada, entonces el proceso
AXR > 42,5 m3/min y vaca o FVN < 4
¿Refrigeración
Ventilación
Ventiladores
Ventiladores axiales o HVLS
AXR < 42,5 m3/min y vaca o FVN > 4
AXR > 42,5 m3/min y vaca o FVN < 6
HVLS FIN
AXR:Caudal
Antonio Callejo Ramos. Dr. Ingeniero Agrónomo
Dpto. de Producción Agraria-E.T.S.I.A.A.B.-UPM antonio.callejo@upm.es
de selección del sistema para evitar el EC se resume en tres pasos:
a. Selección del sistema de ventilación
b. Selección del sistema para aumentar la velocidad del aire
c. Selección del sistema de enfriamiento evaporativo.
La selección de estos sistemas no debe considerar únicamente el diseño y dimensionamiento de los mismos, sino que también deben tener un peso importante en la decisión la inversión y el coste de su funcionamiento con respecto al retorno estimado en producción de leche y en mejor salud de los animales.
Ventilación
Lo fundamental es que la ventilación sea correcta. No puede considerarse ningún sistema de refrigeración por convección o evaporación si no se satisfacen las necesidades de ventilación del alojamiento (ver Frisona Española nº 197).
En primer lugar, se puede utilizar un árbol de decisión (Figura 1) que permita evaluar la calidad de la ventilación del alojamiento y la posible necesidad de añadir un sistema de eliminación de enfriamiento por convección.
No debe considerarse este procedimiento de selección sino como una herramienta que ayude a tomar una decisión, sin olvidar que cada alojamiento es único y que podrá necesitarse consultar otras referencias para el diseño final del sistema de refrigeración.
En el caso de naves con ventilación natural, el valor FVN se explicó en el número 197 de esta revista, ya citado. Si se trata de naves de ventilación dinámica, AXR corresponde al caudal máximo disponible según la capacidad de los ventiladores instalados al efecto dividido entre el número de vacas alojadas en dicha nave
Una vez tomada la primera decisión, podremos utilizar un segundo árbol de decisión (figura 2) para evaluar la necesidad de seleccionar un sistema de enfriamiento evaporativo. Cada una de las posibles decisiones será posteriormente analizada.
Cuando el factor natural de ventilación es mayor de 6 no hay otra solución que instalar un sistema de ventilación mecánica. Incluso en naves con una buena ventilación natural, en las épocas de calor será necesario aumentar la velocidad del
Figura 2. Árbol de decisión para evaluar la necesidad y seleccionar un sistema de refrigeración evaporativa
Inicio
¿Es necesaria refrigeración evaporativa?
¿Refrigeración directa o indirecta?
Directa Indirecta
Nebulizadores
Paneles de evaporación (solo ventilación túnel)
Refrigeración en corral de espera y salida de ordeño
Refrigeración periódica o continua
Rociadores en comedero
aire para evitar que las vacas entren en EC. El objetivo será que las vacas tengan un balance energético igual a cero durante las 24 horas del día. La pregunta es ¿qué sistema se instala?
Ventilación-Túnel
Este sistema se ha ido adoptando cada vez en más granjas a partir de los años noventa, particularmente en climas calurosos y húmedos y con ventilación natural escasa. En este sistema se colocan grandes ventiladores en un extremo de la nave que extraen el aire desde el otro extremo, por donde entra (Figura 3). Por razones prácticas de diseño, las entradas de aire, los ventiladores, o ambos, pueden instalarse en los extremos de las paredes laterales. Las diferencias de funcionamiento son escasas.
La ventilación en túnel es un buen método para lograr aumentar la velocidad del aire sin necesidad de aumentar el caudal de ventilación. La ecuación que liga ambos parámetros es:
siadas diferencias en la reducción del calor alcanzada en naves con una ventilación en túnel o en otras con una ventilación natural bien diseñada y con ventiladores de tipo axial. Por ello, la decisión será económica, comparando los costes de inversión y de funcionamiento de ambos sistemas. No obstante, y como ya indicábamos anteriormente, la ventilación túnel implica cerrar completamente los laterales y los frentes de la nave, en un extremo de la cual se colocarían los ventiladores que extraen el aire; en el otro extremo o frente se situaría la entrada de aire.
La ventilación túnel presenta el inconveniente de no adaptarse bien a temperaturas más suaves pues con los laterales de la nave cerrados, los ventiladores deben estar funcionando de manera continua para conseguir un adecuado intercambio de aire. Cuando las temperaturas bajan, el sistema debe poder abrir automáticamente los cierres laterales, desconectar los ventiladores y mantener el intercambio de aire mediante ventilación natural, si la anchura de la nave lo permite.
Ventiladores de circulación con ventilación natural
La alternativa a la ventilación túnel es lograr el movimiento adecuado del aire colocando ventiladores a lo largo del interior de la nave, capaces de generar una velocidad del aire de aproximadamente 2,2 m/s a la altura de las vacas en el área de reposo y en la línea de comederos, áreas donde los animales pasan el 75% del tiempo. La pérdida de calor se incrementa, aproximadamente, en 380
Por tanto, si el caudal de aire circula entre un extremo y otro de la nave, la sección transversal que atraviesa tiene menor superficie que la sección longitudinal que atravesaría si el aire circulase desde una fachada lateral hacia la otra (ventilación transversal). Al ser inferior la superficie S, de la ecuación se deduce que el caudal de aire de ventilación circulará a mayor velocidad. Puede lograrse una renovación completa del aire de la nave prácticamente cada minuto. La ecuación también puede usarse para, una vez fijada la velocidad a la que se desea que circule el aire y conocida la superficie de entrada del mismo, calcular el caudal que deben proporcionar los ventiladores.
La velocidad mínima del aire para lograr un efecto de enfriamiento del animal es de 1,55 m/s, por lo que se debería disponer de 0,9 m2 de superficie entrada de aire por cada 100 m3/min de caudal de ventilación para compensar las inevitables pérdidas de velocidad por rozamiento que el aire experimenta al desplazarse por el interior de la nave y lograr el efecto deseado.
Para evitar que gran parte de la masa de aire que circula de extremo a extremo de la nave lo haga a una altura excesivamente lejana de los animales y éstos puedan aprovechar todas las ventajas del sistema, es recomendable utilizar pantallas o “baffles“colgados del techo de la nave cada 15-20 metros con el fin de conducir el aire a la altura de los animales (Figura 4).
Gooch y Stowel (2003) no encontraron dema-


La ventilación se maximiza disponiendo de amplias fachadas para la entrada de aire (se recomienda 4,5 a 5 m de altura) y caballete en la cumbrera, de una anchura comprendida entre 3 y 5 cm por cada metro de anchura de nave. Para mover el aire existen dos sistemas alternativos: los ventiladores axiales y los ventiladores HVLS (High Volumen Low Speedvolumen alto a baja velocidad).
Estos ventiladores se colocan ligeramente inclinados hacia abajo (10-30º) de forma que el flujo de aire se dirija hacia las vacas (Figura 5 y 7). Bottcher y col (1995a,b) demostraron que un ventilador axial puede mantener la velocidad de 2,2, m/s a una distancia aproximada de 10 veces su diámetro y en una anchura de 3 veces su diámetro. También comprobaron que los ventiladores de transmisión directa generan un “chorro” de aire más largo y estrecho que los de transmisión por correas, debido a dife-
importante mantenerlos en un estado de limpieza correcto para que su rendimiento y vida útil no disminuyan (Figura 6).
Para establecer la cantidad de ventiladores a colocar en una nave determinada se debe multiplicar el caudal de ventilación necesario por animal por la cantidad de animales y dividir por el caudal del ventilador seleccionado.
Ejemplo:
Número de vacas: 200 Necesidades de ventilación por vaca:
> 42,5 m3/min para tener un FNV inferior a 4 Caudal del ventilador: 34.000 m3/h
42,5 m3/min/vaca x 60 min/h x 200 vacas
30.000 m3/h = 15 ventiladores
Ventiladores HVLS
Este tipo de ventilador se coloca en el techo, con las aspas paralelas al suelo y giran alrededor de un eje vertical. Las aspas son largas, alcanzando el
Por tanto, estos ventiladores deben instalarse a tura de 2,2-2,4 m para evitar que las vacas puedan cubículos y sobre las líneas de comederos. Es muy



hacia
2,7 m
1 m


Estos ventiladores deben ser colocados sobre las áreas mayoritariamente ocupadas por las vacas, aunque debe evaluarse la posible cercanía del techo y de postes y evaluar la utilidad de su colocación. Deben espaciarse una distancia igual a dos veces su diámetro para maximizar la velocidad del aire entre ellos. En la figura 9 observamos que la velocidad del aire encima de los cubículos que ocupan las vacas se sitúa entre 0 y 1 m/s, muy por debajo del valor de 2,2 m/s que se considera acon-
abajo (Gallardo y Valtorta, 2011)









¿Cuánto aire está entrando en su ensilado?*








sejable. Incluso la máxima velocidad (1,5 m/s) conseguida sobre la línea de comedero queda por debajo. Sería más aconsejable colocar dos líneas de ventiladores, una sobre cada doble fila de cubículos.
Estos ventiladores consumen el 63% menos de energía que los ventiladores axiales, pero también son 2,5 veces más caros y la uniformidad de la ventilación es menor. Por ello, en cada caso habrá que realizar el correspondiente estudio económico y técnico de estas dos opciones, en función de las dimensiones de la nave y el número de ventiladores a instalar.
La elección de un sistema u otro de refrigeración por convección deberá estar también condicionada por el coste de instalación y el coste de funcionamiento.
Refrigeración por evaporación
En zonas con veranos calurosos, es probable que no sea suficiente la instalación de sistemas de eliminación de calor por convección explicados en el apartado anterior. Por ello, para reducir o evitar el EC de los animales será necesario incorporar la refrigeración evaporativa.
Este sistema trabaja aprovechando el calor de evaporación (o vaporización) del agua, el cual pasa de estado líquido a gaseoso captando calor del aire, reduciéndose la temperatura de éste y aumentando su nivel de humedad. Por esta razón, este sistema funciona con mayor rendimiento (en términos de reducción de temperatura) cuando la humedad relativa del aire es baja.
Refrigeración evaporativa indirecta
En este sistema de refrigeración se refrigera el aire, no la piel del animal. Una primera opción es pulverizar agua a alta presión sobre las vacas en forma de niebla, es decir, de gotas de agua muy pequeñas que enfrían el aire según se evaporan1 Los ventiladores, instalados sobre los inyectores cada 6-102 metros y bajo la estructura de sombreo, crean la corriente de aire necesaria para distribuir esta agua. Las vacas inhalan aire más frío y pueden cederle el calor que tienen que eliminar.
Sin embargo:
•La presencia de viento (o el propio flujo generado de aire generado por los ventiladores) arrastra estas gotas de agua fuera de la zona donde se ubican los animales.
•Si estas gotas no se evaporan antes de llegar a la superficie del animal, puede formarse una capa de aire entre esta “niebla” y el cuerpo del animal que le dificulta la eliminación de calor.
•Si la ventilación no es adecuada, este sistema pude dar lugar a problemas respiratorios.
•Los nebulizadores no pueden gotear sobre la cama del ganado. Si no se instalan en esta zona, se deja sin refrigeración una parte considerable de la superficie de la nave.
•El sistema es más complejo y costoso que otros. En naves con ventilación mecánica (por ejemplo con ventilación túnel) la refrigeración indirecta puede lograrse colocando la nebulización de agua en la entrada de aire. El objetivo es evaporar tanto agua y tan rápidamente como sea posible de modo que el aire enfriado sea conducido a lo largo de toda la nave. El inconveniente de este sistema es que si la nave no es suficientemente larga, parte
1 Al no llegar las gotas al suelo, este sistema puede instalarse para refrigerar aquellas zonas que no deben mojarse; p.ej., la cama o el comedero
2 Según su diámetro
del agua nebulizada que entra saldrá por el otro extremo (donde están los ventiladores) sin evaporar y, por tanto, sin enfriar el aire.
En regiones muy áridas, donde las vacas lecheras se ubican en grandes corrales de tierra compactada, las imprescindibles estructuras de sombra pueden ser dotadas de un sistema de nebulización y ventilación forzada que se va moviendo con el desplazamiento de la sombra proyectada (Figuras
Figuras 10 y 11. Nebulización y ventilación bajo


Una segunda opción, y que también se ha utilizado muy satisfactoriamente, es la de paneles humectantes similares a los usados en naves de

La eficiencia de estos paneles es del 68 al 85%, dependiendo de la velocidad del aire a través del panel y del espesor del propio panel. Cuanto mayor es la velocidad, menor es el rendimiento, pues el aire tiene menos tiempo para evaporar el agua. Este sistema suele requerir que el aire sea extraído
Figura 12. Esquema de funcionamiento de los paneles humectantespor ventiladores instalados en el lado opuesto al del panel. (Figuras 13 y 14).
El consumo de agua en este sistema de refrigeración fue estimado por Harner y col . (2009) en 0,19 l/min y m2 de panel evaporador, con un valor medio de 49 l/día y plaza y un máximo de 85,8 l/día y plaza. Los datos recogidos sugieren que el consumo de agua en las horas de más calor puede triplicar el consumo medio, lo que hay que tener en cuenta a la hora de dimensionar las tuberías de suministro de agua al panel.
Refrigeración evaporativa directa
Este sistema difiere del anterior en que el objetivo no es enfriar el aire sino mojar directamente la piel del animal. Para ello, Chastain y Turner (1994) recomendaron aplicar 1,2 l/m



dar atrapadas y formar una fina capa de agua sobre el pelo, que atraparía una fina capa de aire entre aquélla y la piel, que actuaría como aislante e impediría la eliminación de calor por el animal. El sistema de evaporación directa más habitual es el que moja a las vacas mientras están en la línea de comederos con boquillas o rociadores de baja presión, alto volumen y gotas gruesas (Figura 15). Para aumentar más la capacidad de evaporación del aire, este rociado de los animales se combina con una ventilación forzada generada por ventiladores, generalmente de tipo axial (Figura 16).
Las especificaciones típicas de este sistema son boquillas de 2,3 l/min de caudal, a 140 kPa de presión, de 180º o inferior de salida de agua y colocadas como se indica en la Figura 17. Son perfectamente válidos los difusores que se utilizan en el riego de jardines. Un ángulo de salida de agua de 135 º da excelentes resultados: consume menos agua y no moja la cabeza y cuello de los animales mientras están comiendo (Li y col., 2012).
Se realizan ciclos de mojado de 1 a 3 minutos, seguidos de secado con la ventilación forzada generada por los ventiladores durante 12 a 14 minutos. Estos ciclos deben acortarse conforme aumenta la temperatura.
La cantidad de agua necesaria en este sistema puede estimarse a partir de la siguiente ecuación:


Distancia entre difusores
Tuberías de difusores
Cornadiza
Típico sistema de pulverizadores colocados sobre la línea de comederos
Cornadiza
3l/m representa la aplicación de 1,25 l/m2 por cada ciclo de mojado-secado en una franja de 1,5 m de ancho a lo largo del comedero
Tuberías de difusores
Área mojada por cada pulverizador
Evitar mojar los cubículos
Vista cenital de los aspersores sobre la cornadiza
Corral de espera
Programador de riego
Pasillo de alimentación
Válvulas, filtros y reductores de presión
Las observaciones realizadas en las granjas muestran que aproximadamente el 50% del agua utilizada no se evaporará en la piel del animal y escurrirá hacia el suelo y formará parte de la producción diaria de purín o de estiércol. Para limitar estas pérdidas de agua se deben ajustar los ciclos de mojado-secado, acortando el tiempo de mojado y aumentando el número de ciclos. Estos ciclos serán controlados por un termostato, que pondrá en marcha el sistema a una temperatura del aire determinada (entre 21 y 24 ºC) y un programador similar a los que se utilizan para el riego de jardines, que abrirá una válvula colocada en la tubería de suministro de agua durante el tiempo de mojado y la cerrará durante el de secado.
Cuando las líneas de comederos son muy largas, conviene dividir la instalación en varios circuitos independientes, cada uno con una válvula solenoide y todas controladas por el mismo controlador. De esta manera, no se suman los consumos de agua de toda la instalación simultáneamente y se puede mantener suministrar un caudal instantáneo y una presión de agua más bajos (Figura 18).
Este sistema también puede instalarse en la sala de espera al ordeño (Figura 20) donde el hacinamiento de los animales antes del ordeño puede provocar un sensible aumento del ITH que debe evitarse. En este caso, los rociadores expulsan agua en un ángulo de 360 º si se colocan en el interior del corral o de 180 si se instalan en los laterales (o ambos). Todo dependerá del diseño y de las dimensiones de la sala. Obviamente también se colocarán ventiladores para crear una corriente forzada de aire.
Finalmente, una tercera posibilidad para refrigerar directamente las vacas es colocar duchas accionadas automáticamente cuando los animales salen de la sala de ordeño a través de un pasillo (Figuras 20 y 11). Cuando la ducha es de libre acceso, su uso se incrementa con la temperatura (0,3h/ºC), aunque hay una amplia variabilidad individual (Legrand y col., 2011).
Deben recordarse las necesidades que deben cubrirse para el buen funcionamiento del sistema de evaporación:
•Amplio suministro de agua (175-265 l/vaca y día)
•Estructura cubierta
•Alojamiento diseñado para recoger y manejar el agua no evaporada (suelo de hormigón y con adecuada pendiente).
•Adecuado suministro eléctrico. Para evitar un pico excesivo de demanda eléctrica, los ventiladores deben ponerse en marcha de forma secuencial, no simultánea.



•Alimento y agua en las proximidades del área que se enfría. El sistema sólo es eficaz si las vacas comen y producen más.

En el apartado “Artículos técnicos” de la web www.revistafrisona.com se puede consultar el Ejemplo de selección del sistema de refrigeración
Figura 18. Esquema de instalación de rociadores en comederos y corral de espera Rociadores de 360ºRociadores de 135ºEl sábado 26 de septiembre a las 12.15 horas, en el salón de actos del Palacio de Congresos del Recinto Ferial de Asturias Luis Adaro, en Gijón, y en el marco de la Feria del Campo y las Industrias Agrícolas, Ganaderas, Forestales y Pesqueras (AGROPEC; 2527 de septiembre), tendrán lugar los IV ENCUENTROS PROFESIONALES CLAS SAT, que como viene siendo habitual, se celebrarán coincidiendo con el Concurso Nacional de Conafe de la Raza Frisona.
El título y el esquema de la Jornada son:
El objetivo principal de la jornada es la concienciación de los ganaderos acerca de la importancia de un correcto manejo de la recría de novillas, así como de los cuidados que requiere la vaca seca, factores ambos determinantes en la rentabilidad de la explotación. El óptimo manejo durante estos periodos prevendrá la aparición de enfermedades metabólicas (hipocalcemias, cetosis, desplazamiento de abomaso, etc.), problemas reproductivos (retención de placenta, metritis, quistes ováricos, etc.), deficiencias del sistema inmunitario (mamitis, elevado índice de células somáticas, etc.) y cojeras.
Los ponentes invitados son profesionales de reconocido prestigio en el ámbito del vacuno lechero.


El Dr. D. José Eduardo Santos es Profesor de la Universidad de Florida, referente mundial en el campo del manejo reproductivo vacuno, y ponente habitual en eventos de primer nivel en España. Su presentación se centrará en el análisis de los puntos críticos del manejo de la vaca seca, y su repercusión sobre la salud posterior de la vaca y del rebaño.

D. José Luis Juaristi es el responsable técnico del Rancho las Nieves, centro de recría de referencia a nivel mundial; es además responsable de la Granja La Travesía. Tiene también una amplia experiencia como consultor externo, y su participación se centrará en el tema de la recría de novillas y su importancia en la rentabilidad de las explotaciones lecheras.
D. José Pérez García, Gerente de Tapia Hospital Veterinario, Ex Presidente de ANEMBE, es un reconocido especialista a nivel nacional en el campo de la clínica y reproducción del vacuno lechero. En su intervención abordará los aspectos más importantes de la atención a la vaca en el momento del parto, y que pueden determinar la adecuada evolución del periodo postparto.

D. Juan Manuel Alonso Menéndez, especialista en nutrición de vacuno de leche de ASA, es poseedor de una amplia experiencia de campo en explotaciones de la cornisa cantábrica. En su charla abordará los puntos críticos en la elaboración de forrajes de buena calidad, como premisa para una correcta alimentación en los rebaños lecheros.
Los ponentes realizarán una presentación breve en la que describirán los puntos clave de cada uno de los temas abordados (recría, vaca seca, parto, elaboración de ensilados), y las actuaciones que el ganadero debería realizar. En la mesa redonda posterior se podrán aclarar todas las dudas que se planteen sobre estos temas.
La mesa redonda será moderada por el Consultor Veterinario Angel Revilla que transmitirá todas las preguntas que se hayan recibido en el correo electrónico info@clasat.es y dará paso a todas aquellas que quieran realizar los ganaderos asistentes



Efecto de la mastitis subclínica
Mientras que la mayoría de los autores e investigadores coinciden en que las vacas que sufren un episodio de mastitis clínica entre los 14 días previos y los 28 días posteriores a la inseminación artificial (IA), tienen una fertilidad inferior a la habitual, tradicionalmente ha existido más discrepancia en cuanto a la relación entre la mastitis subclínica y la eficiencia reproductiva, por lo que muchas veces se tiende a subestimar el efecto de las mastitis subclínicas sobre la fertilidad de las vacas. Sin embargo recientemente se ha demostrado que la mastitis subclínica, caracterizada por la elevación en el recuento de células somáticas sin síntomas clínicos, alrededor de la inseminación, también está asociada con una reducción significativa de la ciclicidad, de la probabilidad de concepción y del tiempo a concepción. Considerando la naturaleza no obvia de la mastitis subclínica y la alta prevalencia (hasta un 40% en muchas explotaciones), esta relación tiende

Cuando la mastitis se registraba entre la primera inseminación y el diagnóstico de gestación, los días abiertos y los servicios por concepción se incrementaron en vacas con mastitis clínica pero no en los casos de mastitis subclínica. Sin embargo, las vacas con mastitis subclínica registrada antes de la primera inseminación tuvieron incrementados los días a primera inseminación (74,8 vs 67,8) los días abiertos (107,7 vs 85,4) y los servicios por concepción (2,1 vs 1,6). La conclusión del estudio fue que no sólo la mastitis clínica afecta a la reproducción, sino también la mastitis subclínica. Además, la mastitis subclínica seguida de mastitis clínica resultó en la pérdida de eficiencia reproductiva más severa.
Posteriormente, en un trabajo desarrollado en Japón y publicado en de 2011 [2], se estudiaron los parámetros en reproducción de vacas según su recuento de células somáticas, de uno a 3 meses posparto, en grupos de menos de 50.000 céls/ml, de 50.000 a 100.000, 100.000 a 200.000, 200.000 a 500.000 y más de 500.000, sin incluir las vacas con mastitis clínica. En los diferentes grupos de vacas con recuentos de células somáticas superiores a 50.000, el retorno a la ciclicidad ovárica tras el parto se retrasó, aumentaron los días abiertos y disminuyeron la fertilidad a primera inseminación y el porcentaje de vacas gestantes a día 150 posparto.
Por último, otro estudio publicado en 2011 [3], que incluyó datos relativos a un total de casi 300.000 inseminaciones realizadas entre los años 2001 y 2008 en más de 200 explotaciones lecheras en Israel, evidenció el efecto negativo que tienen, tanto las mastitis clínicas como las subclínicas, sobre las tasas de concepción. Las vacas incluidas en el estudio se clasificaron en función de los resultados de los recuentos de células somáticas (RCS) de los controles lecheros de los 2 meses previos y el mes posterior a la IA. El umbral para considerar que una vaca tenía mastitis fue 150.000 céls/ml. Así, los 4 grupos de estudio fueron:
• Grupo 1. Vacas sanas: con RCS inferiores a 150.000 células/ ml en los controles de los 3 meses.
• Grupo 2. Vacas recuperadas de la infección: con RCS superior a 150.000 células/ml en al menos 1 de los 2 controles anteriores a la IA, pero negativo en el control del mes posterior a la IA.
Antonio Jiménez. Ceva Salud Animal• Grupo 3. Vacas con infección reciente: con RCS inferiores al 150.000 células/ml en los controles
previos a la IA negativos, pero superiores a 150.000 células/ml en el control posterior a la IA. • Grupo 4. Vacas con mastitis crónicas: con al menos 2 de los 3 controles positivos.
Los investigadores encontraron que, mientras que el patrón de la mayoría de los casos incluidos en los grupos 2 y 3 se corresponde con episodios de mastitis de tipo clínico-agudo, las vacas incluidas en el grupo 4 presentaron mastitis subclínicas-crónicas. Para determinar la importancia del tipo y momento en el que sucede la mastitis sobre la tasa de concepción, los casos se clasificaron también en función de los RCS (casos leves, moderados y graves) y del tiempo (en intervalos de 10 días entre los 30 días anteriores y 30 siguientes a la IA).
Los resultados de los análisis relevaron que, aunque en diferente medida, un elevado RCS disminuye la probabilidad de gestación para todo tipo de mastitis y momento respecto a la IA en el que suceda. Mientras que la tasa de concepción a primera inseminación para las vacas sanas alcanzó el 39,4%, el porcentaje de vacas gestantes a primera inseminación fue del 36,6; 32,9 y 31,5% para los grupos de vacas recuperadas, recientemente infectadas y con mastitis crónicas, respectivamente. Al comparar la fertilidad de las vacas sanas frente a las afectadas con distintos grados de mastitis subclí-

disminuye en un 23% la probabilidad de concepción si sucede entre los 10 días anteriores y los 30 días posteriores a la IA, pero que no tiene efectos sobre la fertilidad si sucede antes de los 10 días previos a la IA.
La probabilidad de concepción disminuyó en


dad de concepción, pero que además, la elevación del recuento de células somáticas por mililitro, típica de las mastitis subclínicas, alrededor de la inseminación artificial, está asociada con una reducción significativa en la probabilidad de concepción, y que incluso elevaciones ligeras en el recuento celular reducen la tasa de concepción.
Límites de la relación mastitis-reproducción: Multifactoralidad y diferencias de efecto a nivel individual y a nivel de explotación
Otro trabajo reciente en forma de estudio probabilístico ha evaluado el efecto global de la mastitis sobre la eficiencia reproductiva a nivel de explotación [4]. Como hemos visto, varios trabajos recientes han demostrado que la mastitis clínica alrededor de la inseminación está asociada con una reducción en la probabilidad de gestación de entre un 20 a un 80 % (Hertl et al., 2010; Hudson et al., 2012) y que los recuentos elevados de células somá-

cantidad de factores que influencian tanto a la relación entre mastitis y reproducción, como a la eficiencia reproductiva general. El resultado de esta simulación ha sido que la asociación entre infecciones intramamarias en una explotación (mastitis clínicas y recuento de células somáticas) y el rendimiento reproductivo a nivel de explotación es débil en la mayoría de los escenarios posibles, a pesar de la fuerte asociación a nivel individual encontrada en anteriores estudios y usada como datos introducidos en el modelo. En concreto, según este estudio se esperaría que un importante incremento en la tasa de incidencia de mastitis clínica (de 92 a 131 casos por 100 vacas por año) incrementaría las pérdidas por reproducción en sólo 6 euros por vaca y año. El estudio probabilístico sugiere que a nivel de explotación, la mejora de la salud de la ubre podría no proporcionar a veterinarios y ganaderos una posibilidad de mejorar la fertilidad general de la explotación.
Aún así, está claro que los efectos de la mastitis sobre la reproducción son bastante fuertes y se producen de forma consistente cuando se observan de forma individual en vacas o grupos de vacas afectadas. La atención a la salud a nivel de la ubre puede ser entonces considerada no sólo como una oportunidad de mejora en sí misma, sino también como una posibilidad de mejorar los resultados reproductivos en esas poblaciones de vacas afectadas.
Bibliografia
1-Schrick FN, Hockett ME, Saxton AM, Lewis MJ, Dowlen HH, Oliver SP., 2001. Influence of Subclinical Mastitis During Early Lactation on Reproductive Parameters. J Dairy Sci 84: 1407-1412.
2-Nguyen TC, Nakao T, Gautam G, Su LT, Ranasinghe RM, Yusuf M. 2011. Relationship between milk somatic cell count and postpartum ovarian cyclicity and fertility in dairy cows. Acta Vet Hung 59:349-62.
3-Y Lavon, E Ezra, G Leither, Wolfenson, 2011: Association of conception rate with pattern and level of somatic cell count elevation relative to time of insemination in dairy cows. Journal of Dairy Science; 94:4538-45.
4-Hudson CD, Bradley AJ, Breen JE, Green MJ. Dairy herd mastitis and reproduction: Using simulation to aid interpretation of results from discrete time survival analysis. Vet J. 2015 Jan 28.





Jueves, día 24 de septiembre:
Entrada de ganado. La entrada de ganado deberá realizarse hasta las 20 horas del día 24 de septiembre.
Viernes, día 25 de septiembre:
Descanso del ganado.
Sábado, día 26 de septiembre:
Mañana: Concurso (Terneras y Novillas)
•Primera Sesión: desde las 10:00 horas.
Juzgamiento de las secciones: 1, 2, 3, 4, 5, 6, 7, 8 y 9.
Tarde:
•16:30 horas. XV Campeonato Nacional de Manejadores.
Domingo, día 27 de septiembre:
Mañana: Concurso (Vacas lactación y grupos).
•Segunda Sesión: desde las 10:00 horas.
Juzgamiento de las secciones: 10, 11, 12, 13, 14, 15, 16, 17, 18, 19, 20, 21, 22, 23 y 24.
NOTA: Todos los actos comenzarán rigurosamente a las horas fijadas.
Fecha de referencia: A efectos de determinar la edad, se considera como tal el día 31 de agosto de 2015.
1. La identificación, edad, parentesco y propiedad de los animales se comprobarán por el Comité de Admisión mediante la correspondiente Carta Genealógica Oficial o Certificado de Registro, que deberá ser entregado siempre que el Comité lo solicite. El animal del que no se presente la documentación anterior no podrá competir.
2. Definiciones:
a) Novilla no parida: Toda aquella que no haya parido nunca.
b) Hembra lactación: Es aquella que se encuentra en ordeño.
3. El Juez en cada sección establecerá un orden de mejor a peor.


4. Se publicará a continuación del Concurso, antes de finalizar los actos, una relación de todos los animales con el lugar establecido por el Juez de pista en cada sección.
5. A efectos de consecución de premios (banderines, estandartes, trofeos, diplomas, etc.) se considerarán los cinco primeros puestos en pista.
6. Los estandartes y/o banderines y trofeos se entregarán en la misma pista de competición, en el momento de realizar su dictamen el Juez al final de cada sección.
7. Los campeonatos no serán premios únicos, sino que se subdividirán en:
-Campeona.
-Subcampeona.
8. El Gran Campeonato de Novillas será premio único y el Gran Campeonato de Vacas se subdividirá en:
-Gran Campeona Nacional (Vacas).
-Gran Campeona Nacional Reserva (Vacas).
9. El título de Campeona queda reservado para animales individuales, no para grupos de animales.
10. Los grupos de animales obtendrán el título de Mejor y Segundo.
11. Se concederán Estandartes de color azul (letras y cenefas doradas) a:
•Campeona y Subcampeona.
•Gran Campeona Nacional y Gran Campeona Nacional Reserva (Vacas).
•Mejor Rebaño Nacional y Segundo Rebaño Nacional.
•Mejor Criador Nacional y Segundo Criador Nacional.
•Mejor Autonomía y Segunda Autonomía.
12. Se concederán Banderines a los cinco primeros clasificados en cada sección individual, con el distintivo de color único (azul), indicando su clasificación.
13. Se concederá Banderín a la mejor ubre de cada sección.
14. Las actuaciones del Juez en pista se realizarán de forma ininterrumpida, desde el comienzo de cada sección hasta finalizar el programa previsto para el día.
15. Cada sección será juzgada siguiendo el orden que figura en el calendario.
Fecha de Referencia: A efectos de determinar la edad, se considera como tal el día 31 de agosto de 2015
Sección 1ª. Terneras de 8 a 10 meses
Son las hembras de 8 a 10 meses. (Nacidas entre el 1 de octubre de 2014 y el 31 de diciembre de 2014).
Sección 2ª. Terneras de 11 a 13 meses
Son las hembras de 11 a 13 meses. (Nacidas entre el 1 de julio de 2014 y el 30 de septiembre de 2014).
Sección 3ª. Terneras de 14 a 16 meses
Son las hembras de 14 a 16 meses. (Nacidas entre el 1 de abril de 2014 y el 30 de junio de 2014).
Sección 4ª. Novillas de 17 a 19 meses
Son las hembras de 17 a 19 meses, no paridas. (Nacidas entre el 1 de enero de 2014 y el 31 de marzo de 2014).
Sección 5ª. Novillas de 20 a 22 meses
Son las hembras de 20 a 22 meses, no paridas. (Nacidas entre el 1 de octubre de 2013 y el 31 de diciembre de 2013).
Sección 6ª. Novillas de 23 a 26 meses
Son las hembras de 23 a 26 meses, no paridas. (Nacidas entre el 1 de junio de 2013 y el 30 de septiembre de 2013).


Nota: la Organización podrá limitar la participación a 3 animales por ganadería, en las secciones 1ª, 2ª, 3ª, 4ª, 5ª y 6ª.
Sección 7ª. Ternera Campeona
Competirán las dos primeras clasificadas en las secciones 1ª, 2ª y 3ª. Se obtendrán los títulos de Ternera Campeona y Ternera Subcampeona.
Sección 8ª. Novilla Campeona
Competirán las dos primeras clasificadas de las secciones 4ª, 5ª y 6ª. Se obtendrán los títulos de Novilla Campeona y Novilla Subcampeona.
Sección 9ª. Gran Campeona Nacional (Novillas)
Competirán la Ternera Campeona (Sec. 7ª) y la Novilla Campeona (Sec. 8ª). Se obtendrá el premio único de Gran Campeona Nacional (Novillas).
Nota: El juzgamiento de las secciones 7ª, 8ª y 9ª (Campeonato de Terneras, Campeonato de Novillas y Gran Campeonato de Novillas), se realizará simultáneamente en pista.
Sección 10ª. Vaca Joven Lactación hasta 30 meses
Hembras hasta 30 meses en ordeño. (Nacidas después del 31 de enero de 2013). Se entregará un banderín a la Mejor Ubre.
Sección 11ª. Vaca Joven Lactación de 31 a 35 meses
Hembras de 31 a 35 meses en ordeño. (Nacidas entre el 1 de septiembre de 2012 y el 31 de enero de 2013). Se entregará un banderín a la Mejor Ubre.
Sección 12ª. Vaca Intermedia Lactación de 36 a 41 meses
Hembras de 36 a 41 meses en ordeño. (Nacidas entre el 1 de marzo de 2012 y el 31 de agosto de 2012). Se entregará un banderín a la Mejor Ubre.
Sección 13ª. Vaca Intermedia Lactación de 42 a 47 meses
Hembras de 42 a 47 meses en ordeño. (Nacidas entre el 1 de septiembre de 2011 y el 29 de febrero de 2012). Se entregará un banderín a la Mejor Ubre.
Sección 14ª. Vaca Intermedia Lactación de 4 años
Hembras de 48 a 59 meses en ordeño. (Nacidas entre el 1 de septiembre de 2010 y el 31 de agosto de 2011). Se entregará un banderín a la Mejor Ubre.
Sección 15ª. Vaca Adulta Lactación de 5 años
Hembras de 60 a 71 meses en ordeño. (Nacidas entre el 1 de septiembre de 2009 y el 31 de agosto de 2010). Se entregará un banderín a la Mejor Ubre.
Sección 16ª. Vaca Adulta Lactación de 6 años o más
Hembras de 72 meses o más en ordeño. (Nacidas antes del 1 de septiembre de 2009). Se entregará un banderín a la Mejor Ubre.
Sección 17ª. Vaca en Producción de más de 50.000 kg
Competirán un mínimo de cinco hembras en lactación, con al menos tres partos, que hayan producido en lactaciones naturales finalizadas un total de 50.000 kg de leche o más según los datos de producción registrados en la Base de Datos de CONAFE e incluidos en la valoración genética de junio de 2015. Se entregará un banderín a la Mejor Ubre.
En caso de no alcanzarse el mínimo de participación establecido para esta categoría, los animales inscritos en la misma competirán en la sección anterior (Sección 16ª. Vaca adulta lactación de 6 años o más) y se les entregará el banderín que corresponda según la sección 17ª. Los puntos se asignarán a todas las vacas participantes, como una sección normal, no correspondiéndoles puntos por su posición respecto a las de más de 50.000 kg.
Sección 18ª. Vaca Joven Campeona
Competirán las dos primeras clasificadas en las secciones
Vaca Joven Lactación hasta 30 meses (Sec. 10ª) y Vaca Joven Lactación de 31 a 35 meses (Sec. 11ª). Se obtendrán los títulos de Vaca Joven Campeona y Vaca Joven Subcampeona.
Sección 19ª. Vaca Intermedia Campeona
Competirán las dos primeras clasificadas en las secciones
Vaca Intermedia Lactación de 36 a 41 meses (Sec. 12ª), Vaca Intermedia Lactación de 42 a 47 meses (Sec. 13ª) y Vaca In-
termedia Lactación de 4 años (Sec. 14ª). Se obtendrán los títulos de Vaca Intermedia Campeona y Vaca Intermedia Subcampeona.
Sección 20ª. Vaca Adulta Campeona
Competirán las dos primeras clasificadas en las secciones de Vaca Adulta Lactación de 5 años (Sec. 15ª), Vaca Adulta Lactación de 6 años o más (Sec. 16ª) y Vaca Producción de más de 50.000 kg (Sec. 17ª) . Se obtendrán los títulos de Vaca Adulta Campeona y Vaca Adulta Subcampeona.
Sección 21ª. Gran Campeona Nacional (Vacas)
Se obtendrán dos títulos:
Gran Campeona Nacional:
Competirán la Vaca Joven Campeona (Sec. 18ª), Vaca Intermedia Campeona (Sec. 19ª) y Vaca Adulta Campeona (Sec. 20ª). Se obtendrá el título de Gran Campeona Nacional (Vacas).
Gran Campeona Nacional Reserva:
Competirán las vacas campeonas de las secciones que no hayan conseguido el título de Gran Campeona Nacional y la Subcampeona de la sección de la que quede Gran Campeona. Se obtendrá el título de Gran Campeona Nacional Reserva.
Nota: El juzgamiento de las secciones 18ª, 19ª, 20ª y 21ª (Campeonatos de Vaca Joven, Vaca Intermedia, Vaca Adulta y Gran Campeona y Gran Campeona Reserva), se realizarán simultáneamente en pista.
Sección 22ª. Mejor Autonomía
Se entregará este premio a la Autonomía que obtenga el mayor número de puntos ganados en las secciones individuales por hembras en lactación cuyos criadores y propietarios sean ganaderos de la misma, en base al siguiente baremo:
1º2º3º4º5º6º7º8º9º10º
Vacas lactación 2018161412108642
Se obtendrán los títulos de Mejor Autonomía y Segunda Autonomía. Solo puntuarán los mejores cinco animales de cada Autonomía. En caso de empate a puntos, ganará la Autonomía que tenga más primeros puestos de sección y más segundos o terceros si siguiera habiendo empate.
Sección 23ª. Mejor Rebaño Nacional
Se entregará este premio al ganadero que obtenga el mayor número de puntos ganados en las secciones individuales por hembras de su propiedad, en base al siguiente baremo:
1º2º3º4º5º6º7º8º9º10º
Vacas lactación 2018161412108642
Terneras y Novillas 10987654321
Se obtendrán los títulos de Mejor Rebaño Nacional y Segundo Rebaño Nacional. Sólo puntuarán los mejores cinco animales de cada ganadería propietaria. En caso de empate a puntos, ganará el ganadero que tenga más primeros puestos de sección y más segundos o terceros si siguiera habiendo empate.
Sección 24ª. Mejor Criador Nacional
Se entregará este premio al ganadero que, inscrito como participante en el Concurso, obtenga el mayor número de puntos ganados en las secciones individuales por hembras con su prefijo ganadero, en base al siguiente baremo:
1º2º3º4º5º6º7º8º9º10º
Vacas lactación 2018161412108642
Terneras y Novillas 10987654321
Se obtendrán los títulos de Mejor Criador Nacional y Segundo Criador Nacional. Sólo puntuarán los mejores cinco animales de cada ganadería criadora. En caso de empate a puntos, ganará el ganadero que tenga más primeros puestos de sección y más segundos o terceros si siguiera habiendo empate.


Objeto
Con estas distinciones se trata de fomentar que la exposición de los animales en sus cubículos se realice siguiendo unas características deseables de bienestar animal, limpieza y estética, además del trabajo en grupo y la colaboración entre participantes.
Participación
Para participar hay que formar un grupo expositor, compuesto por diferentes participantes.
Los grupos se inscribirán contactando con Gabriel Blanco, jefe del Departamento de Morfología, a la llegada al recinto ferial.
Valoración de Expositores
1.Jurado
El jurado estará compuesto por:
-Gabriel Blanco, jefe del Departamento de Morfología de CONAFE
-Juan Manuel Fernández, técnico calificador de CONAFE
-Javier Álvarez, profesor de la Escuela preparadores de CONAFE.
2.Criterios de valoración
Se valorarán los siguientes apartados desde el día de entrada de los animales en el recinto ferial hasta el último día del Concurso:
a) Bienestar de los animales expuestos: Comodidad, limpieza del espacio, alimentación y bienestar en términos generales.
b) Preparación de los animales expuestos: Limpieza y pelado.
c) Camas: Calidad y el mantenimiento de las camas durante todo el concurso así como la limpieza del pasillo adyacente.
d) Espacio de exposición: Limpieza, orden y originalidad del mismo.
e) Trabajo en equipo: Armonía en el trabajo y el buen talante de los componentes del grupo durante el concurso y en la pista de juzgamiento.
f) Opinión del resto de grupos participantes, mediante encuesta realizada por el jurado.
3.Normas a seguir por los expositores
En todo momento hay que cumplir lo establecido en el Reglamento del Concurso y todo aquello que la organización exija. No estará permitido obstaculizar el paso de animales ni de personas en los pasillos mediante la colocación de elementos ornamentales en los mismos.
Se podrá ambientar musicalmente la exposición, pero no está permitido poner música demasiado alta.
Distinciones
Las distinciones se harán públicas y se otorgarán el domingo, 27 de septiembre.
Se distinguirán los 3 expositores de mayor calidad, según lo decida el jurado, con:
-Mención pública en el Concurso por megafonía.
-Reconocimiento en la revista Frisona Española.
-Entrega de diplomas.
Las cédulas de inscripción se pueden descargar desde
en
XV Campeonato Nacional de Manejadores CONAFE 2015
Objetivo
CONAFE organizará durante su Concurso Nacional en Gijón, el XV Campeonato Nacional "CONAFE 2015" de Manejadores.
Se pretende con este Campeonato:
1º Fomentar la profesionalidad y autoestima de ganaderos y profesionales.
2º Estimular a los manejadores en la formación de las técnicas de presentación de los animales en concursos, subastas, exposiciones de su ganado, etc.
1. Podrán participar en el Campeonato todas las personas que lo deseen sin ninguna distinción específica.
2. Se establecerán tres categorías:
•Infantil: Hasta 11 años
•Júnior: De 12 a 17 años
•Sénior: De 18 a 30 años
3. Los que deseen participar deberán inscribirse antes de las 13:00 horas del día 26 de septiembre, provistos con su D.N.I.
Condiciones de Participación
1. Todos los manejadores deberán presentarse uniformados con pantalón y camisa blancos.
2. Presentarse con un animal suficientemente domado, de tal forma que no perturbe las acciones del resto de participantes.
3. Aceptar estas norma y las decisiones del Juez.

Condiciones de Juzgamiento
1. El Juzgamiento se basará fundamentalmente en:
1.Presentación del manejador
2.Preparación del animal: doma, limpieza, etc.
3.Habilidades del manejador en la conducción del animal
4.Atención al Juez y a sus indicaciones
2. No se valorará la morfología del animal ni su extrema preparación.
Títulos
Se concederán los títulos de:
•Campeón Nacional Infantil de Manejadores CONAFE´15
•Subcampeón Nacional Infantil de Manejadores CONAFE´15
•Campeón Nacional Júnior de Manejadores CONAFE´15
•Subcampeón Nacional Júnior de Manejadores CONAFE´15
•Campeón Nacional Sénior de Manejadores CONAFE´15
•Subcampeón Nacional Sénior de Manejadores CONAFE´15
Programa
Sábado, día 26 de septiembre.
•A las 16,15 horas se presentarán todos los participantes inscritos en la pista del Concurso con la indumentaria exigida.
•A las 16,30 horas el Juez del Concurso y Gabriel Blanco (CONAFE) explicarán:
1º)las normas para una buena presentación en pista de los animales y
2º)las reglas para ser un buen manejador.
•A continuación tendrá el desarrollo de las secciones.










LAS NIEVES PORTU SELMA (BB-83)
• Vacas productoras y de muy buena conformación.
• De excelentes ubres y con buenas patas.
• Mucha longevidad y bajo recuento celular.
• De muy fácil parto, para utilizar en novillas.
 BEHI-ALDE PORTU 5827 (BB-83)
Coop. Behi-Alde - Aramaiona – Araba
David Saiz Díaz - Servillas - Cantabria
BEHI-ALDE PORTU 5827 (BB-83)
Coop. Behi-Alde - Aramaiona – Araba
David Saiz Díaz - Servillas - Cantabria

